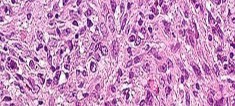

Score: 0%
ORTHOPEDIC MCQS ONLINE PATHOLOGY 017
QUESTION 1
of 100
What is the diagnosis?
What is the diagnosis?
1
Dedifferentiated liposarcoma
2
Intramuscular lipoma
3
Atypical lipomatous tumor
4
Myositis ossificans
- Dedifferentiated liposarcoma_
QUESTION 2
of 100
The role of surgery in this condition is best described as
The role of surgery in this condition is best described as
1
marginal resection is performed with a low likelihood of recurrence.
2
best performed after the lesion becomes “cold” on a bone scan.
3
wide resection as an indication for curative treatment.
4
not indicated.
- wide resection as an indication for curative treatment._
QUESTION 3
of 100
The role of radiation treatment for this lesion is
The role of radiation treatment for this lesion is
1
proven to decrease local recurrence.
2
associated with a high rate of post-radiation sarcoma development.
3
contra-indicated for benign pathology.
4
associated with a higher risk of wound complications if given post-operatively.
- proven to decrease local recurrence._
QUESTION 4
of 100
Chemotherapy for this condition is
Chemotherapy for this condition is
1
contraindicated when pathology is benign.
2
associated with a high risk for subsequent myelodysplastic syndrome.
3
provides dramatic survival benefits.
4
provides modest survival benefits.
This patient has a dedifferentiated liposarcoma within a preexisting atypical lipomatous tumor. The imaging demonstrates a large fatty mass with increased internal septations proximally (the atypical lipomatous tumor) and a solid enhancing mass distally (the dedifferentiated portion). A biopsy reveals a high-grade liposarcoma. The other diagnostic responses do not reflect sarcomatous transformation of the lesion.
Surgical treatment of a high-grade sarcoma involves wide surgical resection. Radiation decreases local recurrence but does not clearly influence overall survival. The role of chemotherapy in high-grade soft-tissue sarcomas remains investigational; there is a modest (8%-15%) associated improvement in overall survival.
Intramuscular lipomas and atypical lipomatous tumors are treated with marginal resection alone. Radiation therapy for soft-tissue sarcomas may be given before or after surgery. When administered before surgery, patients have a higher wound complication rate but better long-term function attributable to lower rates of lymphedema, fibrosis, and contractures.
RECOMMENDED READINGS
1. [Schlieman M, Smith R, Kraybill WG. Adjuvant therapy for extremity sarcomas. Curr Treat Options Oncol. 2006 Nov;7(6):456-63. Review. PubMed PMID: 17032558.](http://www.ncbi.nlm.nih.gov/pubmed/17032558)[View Abstract at PubMed](http://www.ncbi.nlm.nih.gov/pubmed/17032558)
2. [Yang JC, Chang AE, Baker AR, Sindelar WF, Danforth DN, Topalian SL, DeLaney T, Glatstein E, Steinberg SM, Merino MJ, Rosenberg SA. Randomized prospective study of the benefit of adjuvant radiation therapy in the treatment of soft tissue sarcomas of the extremity. J Clin Oncol. 1998 Jan;16(1):197-203. PubMed PMID: 9440743.](http://www.ncbi.nlm.nih.gov/pubmed/9440743)[View Abstract at PubMed](http://www.ncbi.nlm.nih.gov/pubmed/9440743)
3. Soft tissue tumors. In: Damron TA, ed. _Orthopaedic Surgery Essentials: Oncology and Basic Science_. Philadelphia, PA: Lippincott Williams and Wilkins; 2008:87-92
Surgical treatment of a high-grade sarcoma involves wide surgical resection. Radiation decreases local recurrence but does not clearly influence overall survival. The role of chemotherapy in high-grade soft-tissue sarcomas remains investigational; there is a modest (8%-15%) associated improvement in overall survival.
Intramuscular lipomas and atypical lipomatous tumors are treated with marginal resection alone. Radiation therapy for soft-tissue sarcomas may be given before or after surgery. When administered before surgery, patients have a higher wound complication rate but better long-term function attributable to lower rates of lymphedema, fibrosis, and contractures.
RECOMMENDED READINGS
1. [Schlieman M, Smith R, Kraybill WG. Adjuvant therapy for extremity sarcomas. Curr Treat Options Oncol. 2006 Nov;7(6):456-63. Review. PubMed PMID: 17032558.](http://www.ncbi.nlm.nih.gov/pubmed/17032558)[View Abstract at PubMed](http://www.ncbi.nlm.nih.gov/pubmed/17032558)
2. [Yang JC, Chang AE, Baker AR, Sindelar WF, Danforth DN, Topalian SL, DeLaney T, Glatstein E, Steinberg SM, Merino MJ, Rosenberg SA. Randomized prospective study of the benefit of adjuvant radiation therapy in the treatment of soft tissue sarcomas of the extremity. J Clin Oncol. 1998 Jan;16(1):197-203. PubMed PMID: 9440743.](http://www.ncbi.nlm.nih.gov/pubmed/9440743)[View Abstract at PubMed](http://www.ncbi.nlm.nih.gov/pubmed/9440743)
3. Soft tissue tumors. In: Damron TA, ed. _Orthopaedic Surgery Essentials: Oncology and Basic Science_. Philadelphia, PA: Lippincott Williams and Wilkins; 2008:87-92
QUESTION 5
of 100
Figures 5a and 5b are the radiographs of a 74-year-old man with poorly differentiated squamous cell carcinoma of the lung. He has had an uneventful recovery after undergoing a wedge resection of his left upper lobe 6 months ago. He is experiencing left lateral knee pain, and a whole-body positron emission tomography/CT scan shows no avid area other than the lateral left distal femur. This patient has needed to use a wheelchair for 3 weeks because of his pain. You discuss these treatment options: aggressive curettage, local adjuvant treatment, cementation, and prophylactic fixation vs distal femoral resection and megaprosthesis total knee arthroplasty reconstruction. You should tell him that


Figures 5a and 5b are the radiographs of a 74-year-old man with poorly differentiated squamous cell carcinoma of the lung. He has had an uneventful recovery after undergoing a wedge resection of his left upper lobe 6 months ago. He is experiencing left lateral knee pain, and a whole-body positron emission tomography/CT scan shows no avid area other than the lateral left distal femur. This patient has needed to use a wheelchair for 3 weeks because of his pain. You discuss these treatment options: aggressive curettage, local adjuvant treatment, cementation, and prophylactic fixation vs distal femoral resection and megaprosthesis total knee arthroplasty reconstruction. You should tell him that


1
his overall disease-free survival will be no different with either procedure.
2
fixation failure may occur with cementation and prophylactic fixation but not with megaprosthesis reconstruction.
3
infection rates with megaprosthesis reconstruction are lower than with cementation after aggressive curettage.
4
radiation will not be necessary after undergoing either procedure.
Distal femoral megaprosthetic reconstruction after tumor resection is a reliable oncologic procedure, but 5-year implant survival is as low as 74% with an approximate 8% deep infection rate. The amputation rate is as high as 8% because of infection or recurrence, and there is an overall 18% revision rate. More than 10% of distal femoral megaprosthetic reconstructions are performed to address metastatic disease.
Fixation failure and infection may occur with either procedure. Radiation may not be recommended after a megaprosthesis reconstruction unless margins are not free of tumor. Either operation may be equally successful in returning patients to functional activities. Overall disease-free survival is related to the aggressiveness of the tumor and not the type of reconstruction performed.
RECOMMENDED READINGS
4. [Henrichs MP, Krebs J, Gosheger G, Streitbuerger A, Nottrott M, Sauer T, Hoell S, Singh G, Hardes J. Modular tumor endoprostheses in surgical palliation of long-bone metastases: a reduction in tumor burden and a durable reconstruction. World J Surg Oncol. 2014 Nov 7;12:330. doi: 10.1186/1477-7819-12-330. PubMed PMID: 25376274.](http://www.ncbi.nlm.nih.gov/pubmed/25376274)[View Abstract at PubMed](http://www.ncbi.nlm.nih.gov/pubmed/25376274)
5. [Sharma S, Turcotte RE, Isler MH, Wong C. Cemented rotating hinge endoprosthesis for limb salvage of distal femur tumors. Clin Orthop Relat Res. 2006 Sep;450:28-32. ](http://www.ncbi.nlm.nih.gov/pubmed/16906068)[View Abstract at PubMed](http://www.ncbi.nlm.nih.gov/pubmed/16906068)
Fixation failure and infection may occur with either procedure. Radiation may not be recommended after a megaprosthesis reconstruction unless margins are not free of tumor. Either operation may be equally successful in returning patients to functional activities. Overall disease-free survival is related to the aggressiveness of the tumor and not the type of reconstruction performed.
RECOMMENDED READINGS
4. [Henrichs MP, Krebs J, Gosheger G, Streitbuerger A, Nottrott M, Sauer T, Hoell S, Singh G, Hardes J. Modular tumor endoprostheses in surgical palliation of long-bone metastases: a reduction in tumor burden and a durable reconstruction. World J Surg Oncol. 2014 Nov 7;12:330. doi: 10.1186/1477-7819-12-330. PubMed PMID: 25376274.](http://www.ncbi.nlm.nih.gov/pubmed/25376274)[View Abstract at PubMed](http://www.ncbi.nlm.nih.gov/pubmed/25376274)
5. [Sharma S, Turcotte RE, Isler MH, Wong C. Cemented rotating hinge endoprosthesis for limb salvage of distal femur tumors. Clin Orthop Relat Res. 2006 Sep;450:28-32. ](http://www.ncbi.nlm.nih.gov/pubmed/16906068)[View Abstract at PubMed](http://www.ncbi.nlm.nih.gov/pubmed/16906068)
QUESTION 6
of 100
Figures 6a through 6d are the radiographs and T1-weighted sagittal and fat-saturated axial MR images of an otherwise healthy 56-year-old man who has anterior knee pain and intermittent swelling after sustaining a noncontact twisting injury. Low-power and high-power hematoxylin and eosin stained histologic specimens are shown in Figures 6e and 6f. Based on the history, radiographs, CT scan, MR imaging, and histologic findings, what is the most likely diagnosis?






Figures 6a through 6d are the radiographs and T1-weighted sagittal and fat-saturated axial MR images of an otherwise healthy 56-year-old man who has anterior knee pain and intermittent swelling after sustaining a noncontact twisting injury. Low-power and high-power hematoxylin and eosin stained histologic specimens are shown in Figures 6e and 6f. Based on the history, radiographs, CT scan, MR imaging, and histologic findings, what is the most likely diagnosis?






1
Localized pigmented villonodular synovitis (PVNS)
2
Synovial hemangioma
3
Synovial chondromatosis
4
Biphasic synovial sarcoma
The lesion in the posterior intercondylar knee notch is a benign synovial hemangioma. Intralesional calcifications, classically associated with hemangiomas, are frequently not identified on plain radiographs. The MR imaging reveals a hypervascular lesion with multiple filling defects, with hyperintensity on T2-weighted images and low-to-intermediate signal intensity on T1-weighted images. Histologically, vascular lakes within fine capillaries with a synovium on the surface of the lesion are characteristic of this condition. Many patients with synovial hemangioma have pain, swelling, stiffness, or mechanical symptoms. The correlation of symptoms with the hemangioma for this patient is unclear because there was recent trauma and a concurrent meniscus tear. Simultaneous treatment of both potential sources of pain is typically recommended. As with PVNS, the disease can be localized or diffuse. Surgical excision, either open or arthroscopic, is the recommended treatment. PVNS is the most common intra-articular tumor, but hypointensity in either the diffuse or localized type is characteristic in both T1- and T2-weighted images. Synovial sarcoma, although often found close to a joint, is not characteristically found within a joint.
RECOMMENDED READINGS
6. [Lopez-Oliva CL, Wang EH, Cañal JP. Synovial haemangioma of the knee: an under recognised condition. Int Orthop. 2015 Oct;39(10):2037-40. Epub 2015 Jul 31. PMID: 26227920. ](http://www.ncbi.nlm.nih.gov/pubmed/26227920)[View Abstract](http://www.ncbi.nlm.nih.gov/pubmed/26227920)[ ](http://www.ncbi.nlm.nih.gov/pubmed/26227920)[at PubMed](http://www.ncbi.nlm.nih.gov/pubmed/26227920)
7. [Adelani MA, Wupperman RM, Holt GE. Benign synovial disorders. J Am Acad Orthop Surg. 2008 May;16(5):268-75. Review. PubMed PMID: 18460687.](http://www.ncbi.nlm.nih.gov/pubmed/18460687)[View Abstract at PubMed](http://www.ncbi.nlm.nih.gov/pubmed/18460687)
8. Weiss SW, Goldblum JR. Benign tumors and tumor-like lesions of blood vessels. In: Weiss SW, Goldblum JR, eds. _Soft Tissue Tumors_. 5th ed. Philadelphia, PA: Mosby Elsevier; 2008:664-665
RECOMMENDED READINGS
6. [Lopez-Oliva CL, Wang EH, Cañal JP. Synovial haemangioma of the knee: an under recognised condition. Int Orthop. 2015 Oct;39(10):2037-40. Epub 2015 Jul 31. PMID: 26227920. ](http://www.ncbi.nlm.nih.gov/pubmed/26227920)[View Abstract](http://www.ncbi.nlm.nih.gov/pubmed/26227920)[ ](http://www.ncbi.nlm.nih.gov/pubmed/26227920)[at PubMed](http://www.ncbi.nlm.nih.gov/pubmed/26227920)
7. [Adelani MA, Wupperman RM, Holt GE. Benign synovial disorders. J Am Acad Orthop Surg. 2008 May;16(5):268-75. Review. PubMed PMID: 18460687.](http://www.ncbi.nlm.nih.gov/pubmed/18460687)[View Abstract at PubMed](http://www.ncbi.nlm.nih.gov/pubmed/18460687)
8. Weiss SW, Goldblum JR. Benign tumors and tumor-like lesions of blood vessels. In: Weiss SW, Goldblum JR, eds. _Soft Tissue Tumors_. 5th ed. Philadelphia, PA: Mosby Elsevier; 2008:664-665
QUESTION 7
of 100
Figures 7a through 7d are the radiograph, MR images, and biopsy specimen of a 35-year-old man who has a painful, slowly enlarging knee mass. Which chromosomal translocation is characteristic of this pathology?





Figures 7a through 7d are the radiograph, MR images, and biopsy specimen of a 35-year-old man who has a painful, slowly enlarging knee mass. Which chromosomal translocation is characteristic of this pathology?





1
t(11;22)
2
t(9;22)
3
t(x;18)
4
t(12;16)
Synovial sarcoma is a soft-tissue sarcoma that usually occurs in young adults. Synovial sarcoma often causes pain, unlike most soft-tissue sarcomas, which generally do not cause pain. Imaging characteristics include soft-tissue calcifications on plain radiographs and a heterogeneous mass that is generally isointense to muscle on T1-weighted images and hyperintense to muscle on T2-weighted images. There are biphasic and monophasic types of synovial sarcoma. The biphasic
type, which is depicted here, has both spindle cell and epithelial components and will stain for both vimentin and cytokeratin. More than 90% of patients with synovial sarcoma have a characteristic genetic translocation of t(X;18), which results in the fusion protein SS18-SSX. This translocation can be stained for use of florescence in situ hybridization technology. t(11;12) is seen in Ewing sarcoma. T(9;22) is seen in extraskeletal myxoid chondrosarcoma. t(12;16) is seen in myxoid liposarcoma.
RECOMMENDED READINGS
9. [Nielsen TO, Poulin NM, Ladanyi M. Synovial sarcoma: recent discoveries as a roadmap to new avenues for therapy. Cancer Discov. 2015 Feb;5(2):124-34. ](http://www.ncbi.nlm.nih.gov/pubmed/25614489)[View Abstract at PubMed](http://www.ncbi.nlm.nih.gov/pubmed/25614489)
10. [Thway K, Fisher C. Synovial sarcoma: defining features and diagnostic evolution. Ann Diagn Pathol. 2014 Dec;18(6):369-80. doi: 10.1016/j.anndiagpath.2014.09.002. Epub 2014 Oct 13. Review. PubMed PMID: 25438927.](http://www.ncbi.nlm.nih.gov/pubmed/25438927)[View Abstract at PubMed](http://www.ncbi.nlm.nih.gov/pubmed/25438927)
type, which is depicted here, has both spindle cell and epithelial components and will stain for both vimentin and cytokeratin. More than 90% of patients with synovial sarcoma have a characteristic genetic translocation of t(X;18), which results in the fusion protein SS18-SSX. This translocation can be stained for use of florescence in situ hybridization technology. t(11;12) is seen in Ewing sarcoma. T(9;22) is seen in extraskeletal myxoid chondrosarcoma. t(12;16) is seen in myxoid liposarcoma.
RECOMMENDED READINGS
9. [Nielsen TO, Poulin NM, Ladanyi M. Synovial sarcoma: recent discoveries as a roadmap to new avenues for therapy. Cancer Discov. 2015 Feb;5(2):124-34. ](http://www.ncbi.nlm.nih.gov/pubmed/25614489)[View Abstract at PubMed](http://www.ncbi.nlm.nih.gov/pubmed/25614489)
10. [Thway K, Fisher C. Synovial sarcoma: defining features and diagnostic evolution. Ann Diagn Pathol. 2014 Dec;18(6):369-80. doi: 10.1016/j.anndiagpath.2014.09.002. Epub 2014 Oct 13. Review. PubMed PMID: 25438927.](http://www.ncbi.nlm.nih.gov/pubmed/25438927)[View Abstract at PubMed](http://www.ncbi.nlm.nih.gov/pubmed/25438927)
QUESTION 8
of 100
A 45-year-old woman has a painless thigh mass that is larger than 5 cm. What is the best next step?




A 45-year-old woman has a painless thigh mass that is larger than 5 cm. What is the best next step?




1
Percutaneous biopsy
2
Positron emission tomography (PET)/CT scan
3
Excisional biopsy
4
MRI of the thigh with gadolinium
Masses exceeding 5 cm in size and any deep mass should be evaluated with MRI prior to biopsy or excision to ensure the most viable tissue is sampled and to minimize morbidity and complications from an improperly placed biopsy site. Examinations are unreliable when attempting to determine if a mass is a simple lipoma, and any large or deep mass should be considered a sarcoma until proven otherwise. PET/CT is a staging examination to evaluate for metastatic or multifocal disease. These are expensive tests that should not be ordered prior to MR imaging of the primary lesion. For patients that are unable to obtain an MRI, CT of the mass is the preferred imaging modality.
RECOMMENDED READINGS
11. [Gilbert NF, Cannon CP, Lin PP, Lewis VO. Soft-tissue sarcoma. J Am Acad Orthop Surg. 2009 Jan;17(1):40-7. Review. PubMed PMID: 19136426.](http://www.ncbi.nlm.nih.gov/pubmed/19136426)[View Abstract at PubMed](http://www.ncbi.nlm.nih.gov/pubmed/19136426)
12. [Damron TA, Beauchamp CP, Rougraff BT, Ward WG Sr. Soft-tissue lumps and bumps. Instr Course Lect. 2004;53:625-37. Review. PubMed PMID: 15116652.](http://www.ncbi.nlm.nih.gov/pubmed/15116652)[View Abstract at PubMed](http://www.ncbi.nlm.nih.gov/pubmed/15116652)
13. Simon MA. Diagnostic Strategies. In: Simon MA, Springfield D, eds. _Surgery for Bone and Soft Tissue Tumors_. Philadelphia, PA: Lippincott-Raven; 1998:21-30.
CLINICAL SITUATION FOR QUESTIONS 9 THROUGH 11
Figures 9a through 9d are the anteroposterior and lateral radiographs, CT scan, and technetium bone scan of a 12-year-old boy who has experienced 7 months of pain in his lower leg. The pain limits his ability to participate in sports and he is having difficulty sleeping. He is afebrile, and laboratory study findings including an erythrocyte sedimentation rate, C-reactive protein, and complete blood count are within normal limits.
RECOMMENDED READINGS
11. [Gilbert NF, Cannon CP, Lin PP, Lewis VO. Soft-tissue sarcoma. J Am Acad Orthop Surg. 2009 Jan;17(1):40-7. Review. PubMed PMID: 19136426.](http://www.ncbi.nlm.nih.gov/pubmed/19136426)[View Abstract at PubMed](http://www.ncbi.nlm.nih.gov/pubmed/19136426)
12. [Damron TA, Beauchamp CP, Rougraff BT, Ward WG Sr. Soft-tissue lumps and bumps. Instr Course Lect. 2004;53:625-37. Review. PubMed PMID: 15116652.](http://www.ncbi.nlm.nih.gov/pubmed/15116652)[View Abstract at PubMed](http://www.ncbi.nlm.nih.gov/pubmed/15116652)
13. Simon MA. Diagnostic Strategies. In: Simon MA, Springfield D, eds. _Surgery for Bone and Soft Tissue Tumors_. Philadelphia, PA: Lippincott-Raven; 1998:21-30.
CLINICAL SITUATION FOR QUESTIONS 9 THROUGH 11
Figures 9a through 9d are the anteroposterior and lateral radiographs, CT scan, and technetium bone scan of a 12-year-old boy who has experienced 7 months of pain in his lower leg. The pain limits his ability to participate in sports and he is having difficulty sleeping. He is afebrile, and laboratory study findings including an erythrocyte sedimentation rate, C-reactive protein, and complete blood count are within normal limits.
QUESTION 9
of 100
What is the most likely diagnosis?
What is the most likely diagnosis?
1
Osteomyelitis
2
Osteoid osteoma
3
Stress fracture
4
Adamantinoma
- Osteoid osteoma_
QUESTION 10
of 100
The most appropriate treatment of this lesion involves
The most appropriate treatment of this lesion involves
1
radiofrequency ablation (RFA).
2
wide resection and hemicortical allograft reconstruction.
3
prophylactic internal fixation followed by radiation.
4
local debridement and an infectious disease consultation.
- radiofrequency ablation (RFA)._
QUESTION 11
of 100
If this lesion occurred in the spine, which features would most likely be present?
If this lesion occurred in the spine, which features would most likely be present?
1
Syrinx and paralysis
2
Spondylolisthesis and radiculopathy
3
Epidural abscess and fever
4
Scoliosis and paraspinal pain
The images and clinical history support a diagnosis of osteoid osteoma, which most commonly occurs in adolescence. Although these lesions can be seen in any bone, they are usually located in the femur and tibia. The significant inflammatory response to this tumor is secondary to high levels of prostaglandin production. Characteristic night pain is relieved with nonsteroidal anti-inflammatory drugs (NSAIDs) or by aspirin.
Radiographic images show thickened bone and a small central nidus. Thin-cut CT scan is the imaging of choice to visualize the nidus. A bone scan is associated with uptake but is not specific. Treatment options include expectant management with NSAIDs and observation under the premise that these lesions eventually burn out. Contemporary treatment involves RFA. Historically, these lesions were treated with en bloc resection; however, this technique has largely fallen out of favor because of the high efficacy and comparative low morbidity associated with RFA.
When an osteoid osteoma occurs in the spine, it is located in the posterior elements, and paraspinal pain and scoliosis often are present.
RECOMMENDED READINGS
14. [Volkmer D, Sichlau M, Rapp TB. The use of radiofrequency ablation in the treatment of musculoskeletal tumors. J Am Acad Orthop Surg. 2009 Dec;17(12):737-43. Review. PubMed PMID: 19948698. ](http://www.ncbi.nlm.nih.gov/pubmed/19948698)[View Abstract at PubMed](http://www.ncbi.nlm.nih.gov/pubmed/19948698)
15. [Donahue F, Ahmad A, Mnaymneh W, Pevsner NH. Osteoid osteoma. Computed tomography guided percutaneous excision. Clin Orthop Relat Res. 1999 Sep;(366):191-6. PubMed PMID: 10627735. ](http://www.ncbi.nlm.nih.gov/pubmed/10627735)[View](http://www.ncbi.nlm.nih.gov/pubmed/10627735)[ ](http://www.ncbi.nlm.nih.gov/pubmed/10627735)[Abstract at PubMed](http://www.ncbi.nlm.nih.gov/pubmed/10627735)
16. [Boscainos PJ, Cousins GR, Kulshreshtha R, Oliver TB, Papagelopoulos PJ. Osteoid osteoma. Orthopedics. 2013 Oct 1;36(10):792-800. doi: 10.3928/01477447-20130920-10. Review. PubMed PMID: 24093694. ](http://www.ncbi.nlm.nih.gov/pubmed/24093694)[View Abstract at PubMed](http://www.ncbi.nlm.nih.gov/pubmed/24093694)
Radiographic images show thickened bone and a small central nidus. Thin-cut CT scan is the imaging of choice to visualize the nidus. A bone scan is associated with uptake but is not specific. Treatment options include expectant management with NSAIDs and observation under the premise that these lesions eventually burn out. Contemporary treatment involves RFA. Historically, these lesions were treated with en bloc resection; however, this technique has largely fallen out of favor because of the high efficacy and comparative low morbidity associated with RFA.
When an osteoid osteoma occurs in the spine, it is located in the posterior elements, and paraspinal pain and scoliosis often are present.
RECOMMENDED READINGS
14. [Volkmer D, Sichlau M, Rapp TB. The use of radiofrequency ablation in the treatment of musculoskeletal tumors. J Am Acad Orthop Surg. 2009 Dec;17(12):737-43. Review. PubMed PMID: 19948698. ](http://www.ncbi.nlm.nih.gov/pubmed/19948698)[View Abstract at PubMed](http://www.ncbi.nlm.nih.gov/pubmed/19948698)
15. [Donahue F, Ahmad A, Mnaymneh W, Pevsner NH. Osteoid osteoma. Computed tomography guided percutaneous excision. Clin Orthop Relat Res. 1999 Sep;(366):191-6. PubMed PMID: 10627735. ](http://www.ncbi.nlm.nih.gov/pubmed/10627735)[View](http://www.ncbi.nlm.nih.gov/pubmed/10627735)[ ](http://www.ncbi.nlm.nih.gov/pubmed/10627735)[Abstract at PubMed](http://www.ncbi.nlm.nih.gov/pubmed/10627735)
16. [Boscainos PJ, Cousins GR, Kulshreshtha R, Oliver TB, Papagelopoulos PJ. Osteoid osteoma. Orthopedics. 2013 Oct 1;36(10):792-800. doi: 10.3928/01477447-20130920-10. Review. PubMed PMID: 24093694. ](http://www.ncbi.nlm.nih.gov/pubmed/24093694)[View Abstract at PubMed](http://www.ncbi.nlm.nih.gov/pubmed/24093694)
QUESTION 12
of 100
Figures 12a and 12b are a recent radiograph and a whole-body bone scan of an 81-year-old man who has hip pain and difficulty walking. His medical history is significant for obesity, hypertension, chronic kidney disease, and coronary artery disease. An examination demonstrates
moderate tenderness with passive range of motion of the left hip and an inability to actively flex the left hip against gravity. What is the best next step?


Figures 12a and 12b are a recent radiograph and a whole-body bone scan of an 81-year-old man who has hip pain and difficulty walking. His medical history is significant for obesity, hypertension, chronic kidney disease, and coronary artery disease. An examination demonstrates
moderate tenderness with passive range of motion of the left hip and an inability to actively flex the left hip against gravity. What is the best next step?


1
Dynamic hip screw
2
Long cephalomedullary nail
3
Staging studies
4
Toe-touch weight-bearing activity for 6 weeks
This patient has no known history of active malignancy. The radiograph shows a lesser trochanteric avulsion fracture (a fracture routinely associated with an underlying neoplasm). The bone scan reveals no other bone lesions. The femur fracture is statistically most likely to occur because of metastatic disease, but, without other evidence of metastasis, a primary bone sarcoma is possible, and biopsy is recommended before surgical fixation. Observation of this fracture, which is pathognomonic for neoplastic disease, is strongly discouraged.
RECOMMENDED READINGS
17. Adams SC, Potter BK, Mahmood Z, Pitcher JD, Temple HT. Consequences and prevention of inadvertent internal fixation of primary osseous sarcomas. Clin Orthop Relat Res. 2009 Feb;467(2):519-25. doi: 10.1007/s11999-008-0546-3. Epub 2008 Oct 21. PubMed PMID: 18937020.
[View Abstract at PubMed](http://www.ncbi.nlm.nih.gov/pubmed/18937020)
18. [Herren C, Weber CD, Pishnamaz M, Dienstknecht T, Kobbe P, Hildebrand F, Pape HC. Fracture of the lesser trochanter as a sign of undiagnosed tumor disease in adults. Eur J Med Res. 2015 Sep 4;20:72. doi: 10.1186/s40001-015-0167-8. PubMed PMID: 26336955. ](http://www.ncbi.nlm.nih.gov/pubmed/26336955)[View Abstract at PubMed](http://www.ncbi.nlm.nih.gov/pubmed/26336955)
19. Rouvillain JL, Jawahdou R, Labrada Blanco O, Benchikh-El-Fegoun A, Enkaoua E, Uzel M. Isolated lesser trochanter fracture in adults: an early indicator of tumor infiltration. Orthop Traumatol Surg Res. 2011 Apr;97(2):217-20. doi: 10.1016/j.otsr.2010.11.005. Epub 2011 Feb 26. PubMed PMID:
[21354885/. ](http://www.ncbi.nlm.nih.gov/pubmed/21354885)[View Abstract at PubMed](http://www.ncbi.nlm.nih.gov/pubmed/21354885)
RECOMMENDED READINGS
17. Adams SC, Potter BK, Mahmood Z, Pitcher JD, Temple HT. Consequences and prevention of inadvertent internal fixation of primary osseous sarcomas. Clin Orthop Relat Res. 2009 Feb;467(2):519-25. doi: 10.1007/s11999-008-0546-3. Epub 2008 Oct 21. PubMed PMID: 18937020.
[View Abstract at PubMed](http://www.ncbi.nlm.nih.gov/pubmed/18937020)
18. [Herren C, Weber CD, Pishnamaz M, Dienstknecht T, Kobbe P, Hildebrand F, Pape HC. Fracture of the lesser trochanter as a sign of undiagnosed tumor disease in adults. Eur J Med Res. 2015 Sep 4;20:72. doi: 10.1186/s40001-015-0167-8. PubMed PMID: 26336955. ](http://www.ncbi.nlm.nih.gov/pubmed/26336955)[View Abstract at PubMed](http://www.ncbi.nlm.nih.gov/pubmed/26336955)
19. Rouvillain JL, Jawahdou R, Labrada Blanco O, Benchikh-El-Fegoun A, Enkaoua E, Uzel M. Isolated lesser trochanter fracture in adults: an early indicator of tumor infiltration. Orthop Traumatol Surg Res. 2011 Apr;97(2):217-20. doi: 10.1016/j.otsr.2010.11.005. Epub 2011 Feb 26. PubMed PMID:
[21354885/. ](http://www.ncbi.nlm.nih.gov/pubmed/21354885)[View Abstract at PubMed](http://www.ncbi.nlm.nih.gov/pubmed/21354885)
QUESTION 13
of 100
Figures 13a and 13b are the radiographs of a 57-year-old man who is seen in the emergency department. He has been experiencing left thigh pain for 2 month. Four years ago he underwent laparoscopic nephrectomy and states that he has been disease free since the resection (although he has not seen a doctor in 2 years). The pathogenesis of osteolysis in renal cell carcinoma metastatic to bone includes secretion of parathyroid hormone-related peptide (PTHrP), transforming growth factor-B (TGF-B), and vascular endothelial growth factor (VEGF), which directly cause overexpression receptor activation of nuclear factor kB ligand (RANKL) on which cells?


Figures 13a and 13b are the radiographs of a 57-year-old man who is seen in the emergency department. He has been experiencing left thigh pain for 2 month. Four years ago he underwent laparoscopic nephrectomy and states that he has been disease free since the resection (although he has not seen a doctor in 2 years). The pathogenesis of osteolysis in renal cell carcinoma metastatic to bone includes secretion of parathyroid hormone-related peptide (PTHrP), transforming growth factor-B (TGF-B), and vascular endothelial growth factor (VEGF), which directly cause overexpression receptor activation of nuclear factor kB ligand (RANKL) on which cells?


1
Osteoblasts
2
Osteoclasts
3
Osteoclast precursors
4
Both osteoclast precursors and the mature osteoclast
Tumor cells in renal cell carcinoma interact with the bone microenvironment to drive bone destruction and tumor growth by secreting factors such as PTHrP, TGF-B, and VEGF. These factors stimulate the host osteoblast, causing overexpression of RANKL, which in turn causes bone resorption through stimulation of osteoclasts. RANKL expression is upregulated in many types of metastatic cancer to bone, and blocking the RANK/RANKL interaction prevents progression of metastases.
Other actions of RANKL include triggering the migration of human tumor cells that express RANK. RANK and RANKL are expressed in metastatic renal cell carcinoma, and their presence strongly signifies potential recurrence. The use of denosumab, which binds and inactivates RANKL, has its basis in these findings in renal cell carcinoma.
RECOMMENDED READINGS
20. Dougall WC. Molecular pathways: osteoclast-dependent and osteoclast-independent roles of the RANKL/RANK/OPG pathway in tumorigenesis and metastasis. Clin Cancer Res. 2012 Jan 15;18(2):326-35. doi: 10.1158/1078-0432.CCR-10-2507. Epub 2011 Oct 26. PubMed PMID:
[22031096/. ](http://www.ncbi.nlm.nih.gov/pubmed/22031096)[View Abstract at PubMed](http://www.ncbi.nlm.nih.gov/pubmed/22031096)
21. Mikami S, Oya M, Mizuno R, Kosaka T, Katsube K, Okada Y. Invasion and metastasis of renal cell carcinoma. Med Mol Morphol. 2014 Jun;47(2):63-7. doi: 10.1007/s00795-013-0064-6. Epub 2013 Nov
[9/. Review. PubMed PMID: 24213520. ](http://www.ncbi.nlm.nih.gov/pubmed/24213520)[View Abstract at PubMed](http://www.ncbi.nlm.nih.gov/pubmed/24213520)
Other actions of RANKL include triggering the migration of human tumor cells that express RANK. RANK and RANKL are expressed in metastatic renal cell carcinoma, and their presence strongly signifies potential recurrence. The use of denosumab, which binds and inactivates RANKL, has its basis in these findings in renal cell carcinoma.
RECOMMENDED READINGS
20. Dougall WC. Molecular pathways: osteoclast-dependent and osteoclast-independent roles of the RANKL/RANK/OPG pathway in tumorigenesis and metastasis. Clin Cancer Res. 2012 Jan 15;18(2):326-35. doi: 10.1158/1078-0432.CCR-10-2507. Epub 2011 Oct 26. PubMed PMID:
[22031096/. ](http://www.ncbi.nlm.nih.gov/pubmed/22031096)[View Abstract at PubMed](http://www.ncbi.nlm.nih.gov/pubmed/22031096)
21. Mikami S, Oya M, Mizuno R, Kosaka T, Katsube K, Okada Y. Invasion and metastasis of renal cell carcinoma. Med Mol Morphol. 2014 Jun;47(2):63-7. doi: 10.1007/s00795-013-0064-6. Epub 2013 Nov
[9/. Review. PubMed PMID: 24213520. ](http://www.ncbi.nlm.nih.gov/pubmed/24213520)[View Abstract at PubMed](http://www.ncbi.nlm.nih.gov/pubmed/24213520)
QUESTION 14
of 100
Figures 14a through 14c are the MR images of a 72-year-old man who has had a slow-growing asymptomatic mass in his thigh for more than 5 years. Cytogenetic testing on the mass reveals a ring chromosome and MDM2 expression with no 12;16 translocation. What is the most likely diagnosis?



Figures 14a through 14c are the MR images of a 72-year-old man who has had a slow-growing asymptomatic mass in his thigh for more than 5 years. Cytogenetic testing on the mass reveals a ring chromosome and MDM2 expression with no 12;16 translocation. What is the most likely diagnosis?



1
Myxoid liposarcoma
2
High-grade pleomorphic liposarcoma
3
Atypical lipomatous tumor
4
Intramuscular lipoma
This slowly growing mass has lipomatous features on MRI with a fat signal noted on T1 and T2 fat-suppressed images. Some thin striations seen on MRI may suggest an atypical lipomatous tumor. The molecular changes confirm that this is not a simple lipoma. High-grade sarcomas are generally rapidly growing and typically do not have the significant amount of largely homogenous fat signal as seen on this MRI. The negative result of a 12;16 translocation makes the diagnosis of myxoid liposarcoma unlikely. Atypical lipomas typically have a ring chromosome and express MDM2 but do not have the 12;16 translocation, as demonstrated in this patient. Atypical lipomas are synonymous with well-differentiated liposarcomas and pose risk for local recurrence but do not pose significant risk for metastatic spread.
RECOMMENDED READINGS
22. [Binh MB, Sastre-Garau X, Guillou L, de Pinieux G, Terrier P, Lagacé R, Aurias A, Hostein I, Coindre JM. MDM2 and CDK4 immunostainings are useful adjuncts in diagnosing well-differentiated and dedifferentiated liposarcoma subtypes: a comparative analysis of 559 soft tissue neoplasms with genetic data. Am J Surg Pathol. 2005 Oct;29(10):1340-7. PubMed PMID: 16160477. ](http://www.ncbi.nlm.nih.gov/pubmed/16160477)[View Abstract at ](http://www.ncbi.nlm.nih.gov/pubmed/16160477)[PubMed](http://www.ncbi.nlm.nih.gov/pubmed/16160477)
23. Dei Tos AP. Liposarcomas: diagnostic pitfalls and new insights. Histopathology. 2014 Jan;64(1):38-
[52/. doi: 10.1111/his.12311. Epub 2013 Dec 6. Review. PubMed PMID: 24118009. ](http://www.ncbi.nlm.nih.gov/pubmed/24118009)[View Abstract at](http://www.ncbi.nlm.nih.gov/pubmed/24118009)[ ](http://www.ncbi.nlm.nih.gov/pubmed/24118009)[PubMed](http://www.ncbi.nlm.nih.gov/pubmed/24118009)
24. [Iwasaki H, Ishiguro M, Nishio J, Aoki M, Yokoyama R, Yokoyama K, Taguchi K, Nabeshima K. Extensive lipoma-like changes of myxoid liposarcoma: morphologic, immunohistochemical, and molecular cytogenetic analyses. Virchows Arch. 2015 Apr;466(4):453-64. doi: 10.1007/s00428-015-1721-z. Epub 2015 Feb 4. PubMed PMID: 25650275. ](http://www.ncbi.nlm.nih.gov/pubmed/25650275)[View Abstract at PubMed](http://www.ncbi.nlm.nih.gov/pubmed/25650275)
RECOMMENDED READINGS
22. [Binh MB, Sastre-Garau X, Guillou L, de Pinieux G, Terrier P, Lagacé R, Aurias A, Hostein I, Coindre JM. MDM2 and CDK4 immunostainings are useful adjuncts in diagnosing well-differentiated and dedifferentiated liposarcoma subtypes: a comparative analysis of 559 soft tissue neoplasms with genetic data. Am J Surg Pathol. 2005 Oct;29(10):1340-7. PubMed PMID: 16160477. ](http://www.ncbi.nlm.nih.gov/pubmed/16160477)[View Abstract at ](http://www.ncbi.nlm.nih.gov/pubmed/16160477)[PubMed](http://www.ncbi.nlm.nih.gov/pubmed/16160477)
23. Dei Tos AP. Liposarcomas: diagnostic pitfalls and new insights. Histopathology. 2014 Jan;64(1):38-
[52/. doi: 10.1111/his.12311. Epub 2013 Dec 6. Review. PubMed PMID: 24118009. ](http://www.ncbi.nlm.nih.gov/pubmed/24118009)[View Abstract at](http://www.ncbi.nlm.nih.gov/pubmed/24118009)[ ](http://www.ncbi.nlm.nih.gov/pubmed/24118009)[PubMed](http://www.ncbi.nlm.nih.gov/pubmed/24118009)
24. [Iwasaki H, Ishiguro M, Nishio J, Aoki M, Yokoyama R, Yokoyama K, Taguchi K, Nabeshima K. Extensive lipoma-like changes of myxoid liposarcoma: morphologic, immunohistochemical, and molecular cytogenetic analyses. Virchows Arch. 2015 Apr;466(4):453-64. doi: 10.1007/s00428-015-1721-z. Epub 2015 Feb 4. PubMed PMID: 25650275. ](http://www.ncbi.nlm.nih.gov/pubmed/25650275)[View Abstract at PubMed](http://www.ncbi.nlm.nih.gov/pubmed/25650275)
QUESTION 15
of 100
Figures 15a through 15c are the radiograph and MR images of a 16-year-old girl who experienced posterior knee pain after a dance recital 3 weeks ago; the pain resolved 1 week ago with ibuprofen use. What is the most appropriate treatment for this patient?



Figures 15a through 15c are the radiograph and MR images of a 16-year-old girl who experienced posterior knee pain after a dance recital 3 weeks ago; the pain resolved 1 week ago with ibuprofen use. What is the most appropriate treatment for this patient?



1
Image-guided core needle biopsy
2
Clinical observation and serial radiographs
3
Tc-99 whole-body bone scan
4
CT scan with sagittal and coronal reconstructions



The images reveal a small reactive-type lesion in the posteromedial aspect of the distal femur consistent with an avulsive cortical irregularity. Also referred to as a cortical desmoid, periosteal desmoid, or “tug lesion,” this lesion is seen most commonly in young adolescents, with a slight preponderance in boys, with one-third occurring bilaterally. It is thought to be related to repeated microtrauma from pulling of the adductor magnus or medial gastrocnemius on their respective periosteal attachment sites. Proper treatment involves recognition of this benign disorder without further workup. Often best seen on an oblique radiograph, the lack of soft-tissue mass or bone destruction leads to the benign diagnosis. Serial radiographs typically show complete resolution by age 20.
RECOMMENDED READINGS
25. [Gould CF, Ly JQ, Lattin GE Jr, Beall DP, Sutcliffe JB 3rd. Bone tumor mimics: avoiding misdiagnosis. Curr Probl Diagn Radiol. 2007 May-Jun;36(3):124-41. Review. PubMed PMID: 17484955. ](http://www.ncbi.nlm.nih.gov/pubmed/17484955)[View](http://www.ncbi.nlm.nih.gov/pubmed/17484955)[ ](http://www.ncbi.nlm.nih.gov/pubmed/17484955)[Abstract at PubMed](http://www.ncbi.nlm.nih.gov/pubmed/17484955)
26. [Yamazaki T, Maruoka S, Takahashi S, Saito H, Takase K, Nakamura M, Sakamoto K. MR findings of avulsive cortical irregularity of the distal femur. Skeletal Radiol. 1995 Jan;24(1):43-6. PubMed PMID: 7709251. ](http://www.ncbi.nlm.nih.gov/pubmed/7709251)[View Abstract at PubMed](http://www.ncbi.nlm.nih.gov/pubmed/7709251)
27. [Damron TA, Morris C, Rougraff B, Tamurian R. Diagnosis and treatment of joint-related tumors that mimic sports-related injuries. Instr Course Lect. 2009;58:833-47. PubMed PMID: 19385590. ](http://www.ncbi.nlm.nih.gov/pubmed/19385590)[View](http://www.ncbi.nlm.nih.gov/pubmed/19385590)[ ](http://www.ncbi.nlm.nih.gov/pubmed/19385590)[Abstract at PubMed](http://www.ncbi.nlm.nih.gov/pubmed/19385590)
RECOMMENDED READINGS
25. [Gould CF, Ly JQ, Lattin GE Jr, Beall DP, Sutcliffe JB 3rd. Bone tumor mimics: avoiding misdiagnosis. Curr Probl Diagn Radiol. 2007 May-Jun;36(3):124-41. Review. PubMed PMID: 17484955. ](http://www.ncbi.nlm.nih.gov/pubmed/17484955)[View](http://www.ncbi.nlm.nih.gov/pubmed/17484955)[ ](http://www.ncbi.nlm.nih.gov/pubmed/17484955)[Abstract at PubMed](http://www.ncbi.nlm.nih.gov/pubmed/17484955)
26. [Yamazaki T, Maruoka S, Takahashi S, Saito H, Takase K, Nakamura M, Sakamoto K. MR findings of avulsive cortical irregularity of the distal femur. Skeletal Radiol. 1995 Jan;24(1):43-6. PubMed PMID: 7709251. ](http://www.ncbi.nlm.nih.gov/pubmed/7709251)[View Abstract at PubMed](http://www.ncbi.nlm.nih.gov/pubmed/7709251)
27. [Damron TA, Morris C, Rougraff B, Tamurian R. Diagnosis and treatment of joint-related tumors that mimic sports-related injuries. Instr Course Lect. 2009;58:833-47. PubMed PMID: 19385590. ](http://www.ncbi.nlm.nih.gov/pubmed/19385590)[View](http://www.ncbi.nlm.nih.gov/pubmed/19385590)[ ](http://www.ncbi.nlm.nih.gov/pubmed/19385590)[Abstract at PubMed](http://www.ncbi.nlm.nih.gov/pubmed/19385590)
QUESTION 16
of 100
Figures 16a through 16c are the radiograph, MR image, and biopsy specimen of a 12-year-old boy who injured his leg during a soccer game. Assuming other staging study findings are negative, what is the Musculoskeletal Tumor Society (MSTS) stage of this lesion?



Figures 16a through 16c are the radiograph, MR image, and biopsy specimen of a 12-year-old boy who injured his leg during a soccer game. Assuming other staging study findings are negative, what is the Musculoskeletal Tumor Society (MSTS) stage of this lesion?



1
IA
2
IB
3
IIA
4
IIB
The MSTS staging system assigns progressively higher degrees of risk to neoplasms based on their surgical grade, anatomic location, and presence or absence of metastases. Lesions that are low grade are assigned a score of I, while high-grade lesions are assigned a score of II. Lesions contained in the bone or those that are intracompartmental are designated as A, and extracompartmental lesions are designated as B. Metastases elevates the score to III. The radiograph and biopsy specimen reveal a high-grade bone sarcoma with a soft-tissue component with no evidence of metastatic disease. Therefore, this is a stage IIB lesion.
RECOMMENDED READINGS
28. [Wolf RE, Enneking WF. The staging and surgery of musculoskeletal neoplasms. Orthop Clin North Am. 1996 Jul;27(3):473-81. Review. PubMed PMID: 8649730.](http://www.ncbi.nlm.nih.gov/pubmed/8649730)[View Abstract at PubMed](http://www.ncbi.nlm.nih.gov/pubmed/8649730)
29. [Wafa H, Grimer RJ. Surgical options and outcomes in bone sarcoma. Expert Rev Anticancer Ther. 2006 Feb;6(2):239-48. Review. PubMed PMID: 16445376. ](http://www.ncbi.nlm.nih.gov/pubmed/16445376)[View Abstract at PubMed](http://www.ncbi.nlm.nih.gov/pubmed/16445376)
RECOMMENDED READINGS
28. [Wolf RE, Enneking WF. The staging and surgery of musculoskeletal neoplasms. Orthop Clin North Am. 1996 Jul;27(3):473-81. Review. PubMed PMID: 8649730.](http://www.ncbi.nlm.nih.gov/pubmed/8649730)[View Abstract at PubMed](http://www.ncbi.nlm.nih.gov/pubmed/8649730)
29. [Wafa H, Grimer RJ. Surgical options and outcomes in bone sarcoma. Expert Rev Anticancer Ther. 2006 Feb;6(2):239-48. Review. PubMed PMID: 16445376. ](http://www.ncbi.nlm.nih.gov/pubmed/16445376)[View Abstract at PubMed](http://www.ncbi.nlm.nih.gov/pubmed/16445376)
QUESTION 17
of 100
A 57-year-old man has a bone lesion that was identified on radiograph and MR imaging (Figures 17a and 17b) that were taken to evaluate anterior knee pain. An examination reveals a positive patellar apprehension test finding. The patient brings his imaging findings to his appointment, and you learn that an image-guided core needle biopsy was performed based upon the radiologist’s interpretation of the imaging. The core needle biopsy pathology interpretation text reads, “a low-
grade cartilage consistent with either enchondroma or low-grade chondrosarcoma. Clinical and imaging correlation is recommended.” What is the best next step?





A 57-year-old man has a bone lesion that was identified on radiograph and MR imaging (Figures 17a and 17b) that were taken to evaluate anterior knee pain. An examination reveals a positive patellar apprehension test finding. The patient brings his imaging findings to his appointment, and you learn that an image-guided core needle biopsy was performed based upon the radiologist’s interpretation of the imaging. The core needle biopsy pathology interpretation text reads, “a low-
grade cartilage consistent with either enchondroma or low-grade chondrosarcoma. Clinical and imaging correlation is recommended.” What is the best next step?





1
Fluorescent in situ hybridization analysis of the biopsy sample for the t(9;22) translocation
2
Repeat core needle biopsy, sampling a different site within the tumor
3
Observation with serial radiographs or MR imaging
4
Intercalary resection and intramedullary fixation
Low-grade cartilage lesions are among the few diagnoses for which proceeding to definitive surgical treatment without a definitive histologic diagnosis is appropriate. Extended curettage with adjuvants is an acceptable treatment option for both enchondroma and low-grade chondrosarcoma of the extremities; as such, it is appropriate to proceed to definitive treatment when these are the only diagnoses in the differential. There is no consensus regarding the number and type of adjuvants used in intralesional curettage. There is also lack of consensus regarding how to reconstruct the resultant defect, with some favoring cement and others favoring bone grafting. A wide resection with intercalary resection is not indicated. Most commonly, serial radiologic studies are recommended to ensure no change occurs over time when the lesion is found incidentally, as in this patient.
The t(9;22) translocation occurs in extraskeletal myxoid chondrosarcoma, which is not a consideration for this patient based upon location, imaging, and the biopsy interpretation. Repeat core needle biopsy is not indicated because the value of core needle biopsy in general for low-grade cartilage lesions is questionable in light of sampling error concerns and the inability of expert pathologists to reliably distinguish between enchondroma and low-grade chondrosarcoma. Many orthopaedic oncologists favor proceeding directly to curettage with adjuvants without any biopsy
when the imaging is classic for a low-grade cartilage tumor without any evidence of dedifferentiation. Enchondromas are frequently positron emission tomography (PET) avid, and PET is not used to distinguish enchondroma from low-grade chondrosarcoma.
RECOMMENDED READINGS
30. [Hickey M, Farrokhyar F, Deheshi B, Turcotte R, Ghert M. A systematic review and meta-analysis of intralesional versus wide resection for intramedullary grade I chondrosarcoma of the extremities. Ann Surg Oncol. 2011 Jun;18(6):1705-9. doi: 10.1245/s10434-010-1532-z. Epub 2011 Jan 22. Review. PubMed PMID: 21258968. ](http://www.ncbi.nlm.nih.gov/pubmed/21258968)[View Abstract at PubMed](http://www.ncbi.nlm.nih.gov/pubmed/21258968)
31. [Meftah M, Schult P, Henshaw RM. Long-term results of intralesional curettage and cryosurgery for treatment of low-grade chondrosarcoma. J Bone Joint Surg Am. 2013 Aug 7;95(15):1358-64. doi: 10.2106/JBJS.L.00442. PubMed PMID: 23925739. ](http://www.ncbi.nlm.nih.gov/pubmed/23925739)[View Abstract at PubMed](http://www.ncbi.nlm.nih.gov/pubmed/23925739)
32. [Skeletal Lesions Interobserver Correlation among Expert Diagnosticians (SLICED) Study Group. Reliability of histopathologic and radiologic grading of cartilaginous neoplasms in long bones. J Bone Joint Surg Am. 2007 Oct;89(10):2113-23. PubMed PMID: 17908885. ](http://www.ncbi.nlm.nih.gov/pubmed/17908885)[View Abstract at PubMed](http://www.ncbi.nlm.nih.gov/pubmed/17908885)
33. Jesus-Garcia R, Osawa A, Filippi RZ, Viola DC, Korukian M, de Carvalho Campos Neto G, Wagner
[J. Is PET-CT an accurate method for the differential diagnosis between chondroma and chondrosarcoma? Springerplus. 2016 Feb 29;5:236. doi: 10.1186/s40064-016-1782-8. eCollection 2016. PubMed PMID: 27026930. ](http://www.ncbi.nlm.nih.gov/pubmed/27026930)[View Abstract at PubMed](http://www.ncbi.nlm.nih.gov/pubmed/27026930)
CLINICAL SITUATION FOR QUESTIONS 18 THROUGH 21
Figures 18a through 18c are the radiographs and bone scan of a 23-year-old woman.
The t(9;22) translocation occurs in extraskeletal myxoid chondrosarcoma, which is not a consideration for this patient based upon location, imaging, and the biopsy interpretation. Repeat core needle biopsy is not indicated because the value of core needle biopsy in general for low-grade cartilage lesions is questionable in light of sampling error concerns and the inability of expert pathologists to reliably distinguish between enchondroma and low-grade chondrosarcoma. Many orthopaedic oncologists favor proceeding directly to curettage with adjuvants without any biopsy
when the imaging is classic for a low-grade cartilage tumor without any evidence of dedifferentiation. Enchondromas are frequently positron emission tomography (PET) avid, and PET is not used to distinguish enchondroma from low-grade chondrosarcoma.
RECOMMENDED READINGS
30. [Hickey M, Farrokhyar F, Deheshi B, Turcotte R, Ghert M. A systematic review and meta-analysis of intralesional versus wide resection for intramedullary grade I chondrosarcoma of the extremities. Ann Surg Oncol. 2011 Jun;18(6):1705-9. doi: 10.1245/s10434-010-1532-z. Epub 2011 Jan 22. Review. PubMed PMID: 21258968. ](http://www.ncbi.nlm.nih.gov/pubmed/21258968)[View Abstract at PubMed](http://www.ncbi.nlm.nih.gov/pubmed/21258968)
31. [Meftah M, Schult P, Henshaw RM. Long-term results of intralesional curettage and cryosurgery for treatment of low-grade chondrosarcoma. J Bone Joint Surg Am. 2013 Aug 7;95(15):1358-64. doi: 10.2106/JBJS.L.00442. PubMed PMID: 23925739. ](http://www.ncbi.nlm.nih.gov/pubmed/23925739)[View Abstract at PubMed](http://www.ncbi.nlm.nih.gov/pubmed/23925739)
32. [Skeletal Lesions Interobserver Correlation among Expert Diagnosticians (SLICED) Study Group. Reliability of histopathologic and radiologic grading of cartilaginous neoplasms in long bones. J Bone Joint Surg Am. 2007 Oct;89(10):2113-23. PubMed PMID: 17908885. ](http://www.ncbi.nlm.nih.gov/pubmed/17908885)[View Abstract at PubMed](http://www.ncbi.nlm.nih.gov/pubmed/17908885)
33. Jesus-Garcia R, Osawa A, Filippi RZ, Viola DC, Korukian M, de Carvalho Campos Neto G, Wagner
[J. Is PET-CT an accurate method for the differential diagnosis between chondroma and chondrosarcoma? Springerplus. 2016 Feb 29;5:236. doi: 10.1186/s40064-016-1782-8. eCollection 2016. PubMed PMID: 27026930. ](http://www.ncbi.nlm.nih.gov/pubmed/27026930)[View Abstract at PubMed](http://www.ncbi.nlm.nih.gov/pubmed/27026930)
CLINICAL SITUATION FOR QUESTIONS 18 THROUGH 21
Figures 18a through 18c are the radiographs and bone scan of a 23-year-old woman.
QUESTION 18
of 100
What is the most likely diagnosis?
What is the most likely diagnosis?
1
Fibrous dysplasia
2
Metastatic carcinoma
3
Multiple hereditary exostosis
4
Multiple myeloma
- Fibrous dysplasia_
QUESTION 19
of 100
Despite adequate medical management, the patient continues to experience leg pain that interferes with even the lowest demands of daily living. You recommend prophylactic intramedullary nailing of the tibia with interlocking screws. Prior to the surgery, you should recommend
Despite adequate medical management, the patient continues to experience leg pain that interferes with even the lowest demands of daily living. You recommend prophylactic intramedullary nailing of the tibia with interlocking screws. Prior to the surgery, you should recommend
1
an echocardiogram.
2
an endocrinology consultation.
3
a serum calcium level.
4
a repeat nuclear bone scan.
- an endocrinology consultation._
QUESTION 20
of 100
The most common extraskeletal manifestation of this disease is
The most common extraskeletal manifestation of this disease is
1
café au lait macules.
2
urinary protein elevation.
3
a primary lung mass.
4
an arrhythmia.
- café au lait macules._
QUESTION 21
of 100
The underlying cause of the neoplasm is
The underlying cause of the neoplasm is
1
ALK gene rearrangement.
2
a nongerm-cell mutation of the GNAS1 gene.
3
a germline alteration in EXT1 and EXT2.
4
an abnormality arising from the translocation t(11;14)(q13;q32).
The bone scan reveals multiple bone lesions, which does not rule out any of the responses. The radiographs reveal dysplastic bone with a “ground glass” appearance, suggesting fibrous dysplasia as the preferred response. Multiple myeloma typically demonstrates purely lytic, “punched out” lesions and would be highly unusual in a 23-year-old woman. Multiple hereditary exostosis would demonstrate more expansile lesions concentrated in the metaphysis. Metastatic carcinoma could have a lytic or blastic appearance but is less likely to occur in a 23-year-old woman.
McCune-Albright syndrome in polyostotic fibrous dysplasia is present in as many as 50% of patients and should be evaluated for during an endocrine consultation. Adrenal, pituitary, parathyroid, and thyroid endocrinopathies may be present. Untreated hyperthyroidism can be life threatening during a surgical procedure. There is no indication to repeat the nuclear bone scan. Although phosphate wasting and, rarely, oncogenic osteomalacia have been reported in polyostotic fibrous dysplasia, an endocrinology consultation always should be sought.
Café au lait macules are the most common extraskeletal manifestation of fibrous dysplasia, often referred to as “coast of Maine” in appearance because of their irregular borders (in comparison to the “Coast of California” with smooth borders as seen in neurofibromatosis). Multiple myeloma would not ordinarily appear with increased uptake on a bone scan unless a pathologic fracture of some duration were present. A long area of bone involvement would not appear in patients with metastatic lung adenocarcinoma.
An ALK rearrangement occurs in nonsmall-cell lung cancer. The translocation t(11;14)(q13;q32) should be recognized as a poor prognosticator in multiple myeloma. The germline alteration in EXT1 and EXT2 occurs in multiple hereditary exostosis.
All forms of fibrous dysplasia are caused by a nongerm-cell mutation that occurs during early embryogenesis. A missense mutation of the GNAS1 gene, which encodes the alpha subunit of the stimulatory G-protein-couple-receptor, Gs alpha, results in G-protein activation and the production of cyclic adenosine monophosphate affecting melanocytes, endocrine cells, and osteoprogenitor cells.
RECOMMENDED READINGS
1. [DiCaprio MR, Enneking WF. Fibrous dysplasia. Pathophysiology, evaluation, and treatment. J Bone Joint Surg Am. 2005 Aug;87(8):1848-64. Review.](http://www.ncbi.nlm.nih.gov/pubmed/16085630)[View Abstract at PubMed](http://www.ncbi.nlm.nih.gov/pubmed/16085630)
2. [Parekh SG, Donthineni-Rao R, Ricchetti E, Lackman RD. Fibrous dysplasia. J Am Acad Orthop Surg. 2004 Sep-Oct;12(5):305-13. Review. PubMed PMID: 15469225. ](http://www.ncbi.nlm.nih.gov/pubmed/15469225)[View Abstract at PubMed](http://www.ncbi.nlm.nih.gov/pubmed/15469225)
3. [Shin HJ, Kim K, Lee JJ, Song MK, Lee EY, Park SH, Kim SH, Jang MA, Kim SJ, Chung JS. The t(11;14)(q13;q32) translocation as a poor prognostic parameter for autologous stem cell transplantation in myeloma patients with extramedullary plasmacytoma. Clin Lymphoma Myeloma Leuk. 2015 Apr;15(4):227-35. doi: 10.1016/j.clml.2014.12.007. Epub 2014 Dec 12.](http://www.ncbi.nlm.nih.gov/pubmed/25812994)[View Abstract at PubMed](http://www.ncbi.nlm.nih.gov/pubmed/25812994)
4. [Esfahani K, Agulnik JS, Cohen V. A Systemic Review of Resistance Mechanisms and Ongoing Clinical Trials in ALK-Rearranged Non-Small Cell Lung Cancer. Front Oncol. 2014 Jul 21;4:174. doi: 10.3389/fonc.2014.00174. eCollection 2014. Review. PubMed PMID: 25101240. ](http://www.ncbi.nlm.nih.gov/pubmed/25101240)[View Abstract at](http://www.ncbi.nlm.nih.gov/pubmed/25101240)[ ](http://www.ncbi.nlm.nih.gov/pubmed/25101240)[PubMed](http://www.ncbi.nlm.nih.gov/pubmed/25101240)
McCune-Albright syndrome in polyostotic fibrous dysplasia is present in as many as 50% of patients and should be evaluated for during an endocrine consultation. Adrenal, pituitary, parathyroid, and thyroid endocrinopathies may be present. Untreated hyperthyroidism can be life threatening during a surgical procedure. There is no indication to repeat the nuclear bone scan. Although phosphate wasting and, rarely, oncogenic osteomalacia have been reported in polyostotic fibrous dysplasia, an endocrinology consultation always should be sought.
Café au lait macules are the most common extraskeletal manifestation of fibrous dysplasia, often referred to as “coast of Maine” in appearance because of their irregular borders (in comparison to the “Coast of California” with smooth borders as seen in neurofibromatosis). Multiple myeloma would not ordinarily appear with increased uptake on a bone scan unless a pathologic fracture of some duration were present. A long area of bone involvement would not appear in patients with metastatic lung adenocarcinoma.
An ALK rearrangement occurs in nonsmall-cell lung cancer. The translocation t(11;14)(q13;q32) should be recognized as a poor prognosticator in multiple myeloma. The germline alteration in EXT1 and EXT2 occurs in multiple hereditary exostosis.
All forms of fibrous dysplasia are caused by a nongerm-cell mutation that occurs during early embryogenesis. A missense mutation of the GNAS1 gene, which encodes the alpha subunit of the stimulatory G-protein-couple-receptor, Gs alpha, results in G-protein activation and the production of cyclic adenosine monophosphate affecting melanocytes, endocrine cells, and osteoprogenitor cells.
RECOMMENDED READINGS
1. [DiCaprio MR, Enneking WF. Fibrous dysplasia. Pathophysiology, evaluation, and treatment. J Bone Joint Surg Am. 2005 Aug;87(8):1848-64. Review.](http://www.ncbi.nlm.nih.gov/pubmed/16085630)[View Abstract at PubMed](http://www.ncbi.nlm.nih.gov/pubmed/16085630)
2. [Parekh SG, Donthineni-Rao R, Ricchetti E, Lackman RD. Fibrous dysplasia. J Am Acad Orthop Surg. 2004 Sep-Oct;12(5):305-13. Review. PubMed PMID: 15469225. ](http://www.ncbi.nlm.nih.gov/pubmed/15469225)[View Abstract at PubMed](http://www.ncbi.nlm.nih.gov/pubmed/15469225)
3. [Shin HJ, Kim K, Lee JJ, Song MK, Lee EY, Park SH, Kim SH, Jang MA, Kim SJ, Chung JS. The t(11;14)(q13;q32) translocation as a poor prognostic parameter for autologous stem cell transplantation in myeloma patients with extramedullary plasmacytoma. Clin Lymphoma Myeloma Leuk. 2015 Apr;15(4):227-35. doi: 10.1016/j.clml.2014.12.007. Epub 2014 Dec 12.](http://www.ncbi.nlm.nih.gov/pubmed/25812994)[View Abstract at PubMed](http://www.ncbi.nlm.nih.gov/pubmed/25812994)
4. [Esfahani K, Agulnik JS, Cohen V. A Systemic Review of Resistance Mechanisms and Ongoing Clinical Trials in ALK-Rearranged Non-Small Cell Lung Cancer. Front Oncol. 2014 Jul 21;4:174. doi: 10.3389/fonc.2014.00174. eCollection 2014. Review. PubMed PMID: 25101240. ](http://www.ncbi.nlm.nih.gov/pubmed/25101240)[View Abstract at](http://www.ncbi.nlm.nih.gov/pubmed/25101240)[ ](http://www.ncbi.nlm.nih.gov/pubmed/25101240)[PubMed](http://www.ncbi.nlm.nih.gov/pubmed/25101240)
QUESTION 22
of 100
Figures 22a and 22b are the anteroposterior knee radiograph and an axial T2-weighted MR image of an 11-year-old boy who experienced knee pain following soccer practice. What is the best approach for biopsy?


Figures 22a and 22b are the anteroposterior knee radiograph and an axial T2-weighted MR image of an 11-year-old boy who experienced knee pain following soccer practice. What is the best approach for biopsy?


1
Lateral parapatellar
2
Medial parapatellar
3
Directly medial
4
Directly anterior
The biopsy should cross only 1 compartment if possible and proceed as directly as possible to the tumor. The lateral parapatellar and medial parapatellar approaches cross the knee joint, potentially visualizing tumor into the knee. A direct anterior approach will contaminate an extensive portion of the quadriceps muscle and potentially complicate limb salvage. Biopsy should be performed at the institution at which definitive resection is planned.
RECOMMENDED READINGS
5. Webber NP. Biopsy. In: Biermann JS, ed. _Orthopaedic Knowledge Update Musculoskeletal Tumors 3_. Rosemont, IL: American Academy of Orthopaedic Surgeons; 2013:23-30.
6. Biopsy. In: Simon MA, Springfield D, eds. _Surgery for Bone and Soft Tissue Tumors_. Philadelphia, PA: Lippincott-Raven; 1998:55-66.
RECOMMENDED READINGS
5. Webber NP. Biopsy. In: Biermann JS, ed. _Orthopaedic Knowledge Update Musculoskeletal Tumors 3_. Rosemont, IL: American Academy of Orthopaedic Surgeons; 2013:23-30.
6. Biopsy. In: Simon MA, Springfield D, eds. _Surgery for Bone and Soft Tissue Tumors_. Philadelphia, PA: Lippincott-Raven; 1998:55-66.
QUESTION 23
of 100
Figures 23a through 23c are the MR images of a 55-year-old woman who has experienced more than 10 years of right lower extremity pain that is radiating along the sciatic nerve distribution even though she has had multiple spine decompression procedures. She cannot sit comfortably in a chair and feels a fullness in the posterior aspect of her thigh. What is the most likely diagnosis?



Figures 23a through 23c are the MR images of a 55-year-old woman who has experienced more than 10 years of right lower extremity pain that is radiating along the sciatic nerve distribution even though she has had multiple spine decompression procedures. She cannot sit comfortably in a chair and feels a fullness in the posterior aspect of her thigh. What is the most likely diagnosis?



1
Malignant peripheral nerve sheath tumor
2
Schwannoma
3
Myxoid liposarcoma
4
Desmoid fibromatosis
This patient has had long-standing radiating pain along the sciatic nerve distribution that has not been relieved with spine decompression procedures. Localized symptoms to her posterior thigh should elicit further evaluation with MR imaging. The chronicity of pain and homogeneous appearance of the lesion on MRI would speak against a malignant peripheral nerve sheath tumor. MR imaging reveals a large fusiform mass along the course of the sciatic nerve with a bright T2 signal that is consistent with a nerve sheath tumor. Neurofibroma is another viable option but is not listed as a response, and the patient does not have neurofibromatosis. Myxoid liposarcoma is an intermediate-grade malignancy and could cause long-standing symptoms, but this diagnosis is inconsistent with the imaging provided. Desmoid fibromatosis has features inconsistent with the imaging provided; it typically would involve a darker T2 signal than a myxoid liposarcoma or Schwannoma, and, while sometimes involving a major nerve, this condition typically does not grow along the course of the nerve like a benign nerve sheath tumor.
RECOMMENDED READINGS
7. [Kralick F, Koenigsberg R. Sciatica in a patient with unusual peripheral nerve sheath tumors. Surg Neurol. 2006 Dec;66(6):634-7. PubMed PMID: 17145335. ](http://www.ncbi.nlm.nih.gov/pubmed/17145335)[View Abstract at PubMed](http://www.ncbi.nlm.nih.gov/pubmed/17145335)
8. [Rhanim A, El Zanati R, Mahfoud M, Berrada MS, El Yaacoubi M. A rare cause of chronic sciatic pain: Schwannoma of the sciatic nerve. J Clin Orthop Trauma. 2013 Jun;4(2):89-92. doi: 10.1016/j.jcot.2013.04.001. Epub 2013 Apr 26. PubMed PMID: 26403631. ](http://www.ncbi.nlm.nih.gov/pubmed/26403631)[View Abstract at PubMed](http://www.ncbi.nlm.nih.gov/pubmed/26403631)
9. [Omezzine SJ, Zaara B, Ben Ali M, Abid F, Sassi N, Hamza HA. A rare cause of non discal sciatica: schwannoma of the sciatic nerve. Orthop Traumatol Surg Res. 2009 Nov;95(7):543-6. doi: 10.1016/j.otsr.2009.05.007. Epub 2009 Oct 24. PubMed PMID: 19854690. ](http://www.ncbi.nlm.nih.gov/pubmed/19854690)[View Abstract at PubMed](http://www.ncbi.nlm.nih.gov/pubmed/19854690)
RECOMMENDED READINGS
7. [Kralick F, Koenigsberg R. Sciatica in a patient with unusual peripheral nerve sheath tumors. Surg Neurol. 2006 Dec;66(6):634-7. PubMed PMID: 17145335. ](http://www.ncbi.nlm.nih.gov/pubmed/17145335)[View Abstract at PubMed](http://www.ncbi.nlm.nih.gov/pubmed/17145335)
8. [Rhanim A, El Zanati R, Mahfoud M, Berrada MS, El Yaacoubi M. A rare cause of chronic sciatic pain: Schwannoma of the sciatic nerve. J Clin Orthop Trauma. 2013 Jun;4(2):89-92. doi: 10.1016/j.jcot.2013.04.001. Epub 2013 Apr 26. PubMed PMID: 26403631. ](http://www.ncbi.nlm.nih.gov/pubmed/26403631)[View Abstract at PubMed](http://www.ncbi.nlm.nih.gov/pubmed/26403631)
9. [Omezzine SJ, Zaara B, Ben Ali M, Abid F, Sassi N, Hamza HA. A rare cause of non discal sciatica: schwannoma of the sciatic nerve. Orthop Traumatol Surg Res. 2009 Nov;95(7):543-6. doi: 10.1016/j.otsr.2009.05.007. Epub 2009 Oct 24. PubMed PMID: 19854690. ](http://www.ncbi.nlm.nih.gov/pubmed/19854690)[View Abstract at PubMed](http://www.ncbi.nlm.nih.gov/pubmed/19854690)
QUESTION 24
of 100
Figures 24a and 24b are the right femur radiograph and bone scan of a 71-year-old man with longstanding metastatic prostate cancer who has experienced increasing right thigh pain for 2 months. The pain is worse with activity and is alleviated with rest. He experienced similar pain in his left thigh 18 months ago and subsequently sustained a left subtrochanteric femur fracture after a low-energy twisting injury. He was successfully treated with an intramedullary nail. He had been receiving zoledronic acid for 4 years prior to the fracture. This patient’s history includes heavy steroid use. His current symptoms are most likely the result of


Figures 24a and 24b are the right femur radiograph and bone scan of a 71-year-old man with longstanding metastatic prostate cancer who has experienced increasing right thigh pain for 2 months. The pain is worse with activity and is alleviated with rest. He experienced similar pain in his left thigh 18 months ago and subsequently sustained a left subtrochanteric femur fracture after a low-energy twisting injury. He was successfully treated with an intramedullary nail. He had been receiving zoledronic acid for 4 years prior to the fracture. This patient’s history includes heavy steroid use. His current symptoms are most likely the result of


1
a prostaglandin-secreting prostate metastasis.
2
inhibition of osteoclastic function.
3
right L4 radiculopathy secondary to prostate metastasis.
4
direct inhibition of osteoclast prenylation.
_
This patient’s history and imaging are most consistent with an atypical femoral fracture attributable to impaired bone remodeling. Both bisphosphonates and denosumab are associated with atypical
femur fractures. Atypical fractures may occur in the diaphysis and the subtrochanteric region. The patient’s prior femur fracture was attributable to bisphosphonate (zoledronic acid) use. Bisphosphonates directly inhibit osteoclasts. He subsequently experienced a long symptom-free interval during which he took denosumab, which is an indirect osteoclast inhibitor. The imaging is not consistent with a symptomatic prostate metastasis. L4 radiculopathy may cause thigh pain, but there is no evidence (other than the mention of spine metastasis) supporting this diagnosis.
RECOMMENDED READINGS
10. [Shane E, Burr D, Abrahamsen B, Adler RA, Brown TD, Cheung AM, Cosman F, Curtis JR, Dell R, Dempster DW, Ebeling PR, Einhorn TA, Genant HK, Geusens P, Klaushofer K, Lane JM, McKiernan F, McKinney R, Ng A, Nieves J, O'Keefe R, Papapoulos S, Howe TS, van der Meulen MC, Weinstein RS, Whyte MP. Atypical subtrochanteric and diaphyseal femoral fractures: second report of a task force of the American Society for Bone and Mineral Research. J Bone Miner Res. 2014 Jan;29(1):1-23. doi: 10.1002/jbmr.1998. Epub 2013 Oct 1. Review. PubMed PMID: 23712442. ](http://www.ncbi.nlm.nih.gov/pubmed/23712442)[View Abstract at PubMed](http://www.ncbi.nlm.nih.gov/pubmed/23712442)
11. [Schilcher J, Koeppen V, Aspenberg P, Michaëlsson K. Risk of atypical femoral fracture during and after bisphosphonate use. N Engl J Med. 2014 Sep 4;371(10):974-6. doi: 10.1056/NEJMc1403799. PubMed PMID: 25184886.](http://www.ncbi.nlm.nih.gov/pubmed/25184886)[View Abstract at PubMed](http://www.ncbi.nlm.nih.gov/pubmed/25184886)
femur fractures. Atypical fractures may occur in the diaphysis and the subtrochanteric region. The patient’s prior femur fracture was attributable to bisphosphonate (zoledronic acid) use. Bisphosphonates directly inhibit osteoclasts. He subsequently experienced a long symptom-free interval during which he took denosumab, which is an indirect osteoclast inhibitor. The imaging is not consistent with a symptomatic prostate metastasis. L4 radiculopathy may cause thigh pain, but there is no evidence (other than the mention of spine metastasis) supporting this diagnosis.
RECOMMENDED READINGS
10. [Shane E, Burr D, Abrahamsen B, Adler RA, Brown TD, Cheung AM, Cosman F, Curtis JR, Dell R, Dempster DW, Ebeling PR, Einhorn TA, Genant HK, Geusens P, Klaushofer K, Lane JM, McKiernan F, McKinney R, Ng A, Nieves J, O'Keefe R, Papapoulos S, Howe TS, van der Meulen MC, Weinstein RS, Whyte MP. Atypical subtrochanteric and diaphyseal femoral fractures: second report of a task force of the American Society for Bone and Mineral Research. J Bone Miner Res. 2014 Jan;29(1):1-23. doi: 10.1002/jbmr.1998. Epub 2013 Oct 1. Review. PubMed PMID: 23712442. ](http://www.ncbi.nlm.nih.gov/pubmed/23712442)[View Abstract at PubMed](http://www.ncbi.nlm.nih.gov/pubmed/23712442)
11. [Schilcher J, Koeppen V, Aspenberg P, Michaëlsson K. Risk of atypical femoral fracture during and after bisphosphonate use. N Engl J Med. 2014 Sep 4;371(10):974-6. doi: 10.1056/NEJMc1403799. PubMed PMID: 25184886.](http://www.ncbi.nlm.nih.gov/pubmed/25184886)[View Abstract at PubMed](http://www.ncbi.nlm.nih.gov/pubmed/25184886)
QUESTION 25
of 100
Denosumab, the human monoclonal antibody that specifically binds and inactivates receptor activator of nuclear factor-kB ligand (RANKL), is commonly used in the setting of metastatic disease. Its cell surface receptor is expressed by
Denosumab, the human monoclonal antibody that specifically binds and inactivates receptor activator of nuclear factor-kB ligand (RANKL), is commonly used in the setting of metastatic disease. Its cell surface receptor is expressed by
1
mature osteoclasts only.
2
mature osteoblasts only.
3
both osteoclast precursors and mature osteoclasts.
4
both osteoblast precursors and mature osteoblasts.
Bone remodeling involves both osteoblasts and osteoclasts. RANKL, a member of the tumor necrosis factor (TNF) family, is a key regulator of osteoclast formation and function. The receptor of RANKL, RANK, is expressed by both osteoclast precursors and mature osteoclasts. Denosumab inhibits the binding of RANKL to RANK, decreasing osteoclastogenesis and bone-resorption by mature osteoclasts.
Osteoblasts produce osteoprotegerin, which stimulates osteoclasts to induce apoptosis by acting as a decoy for RANKL, preventing the binding of RANKL to RANK. Osteoprotegerin also binds to other TNF-related apoptosis-inducing ligands and other TNF members including TNF-a, TNF-B, and CD40 ligand. Denosumab does not bind to any other TNF members.
Breast cancer metastases produce cytokines that induce osteoblasts to express elevated levels of RANKL, stimulating osteoclastogenesis via binding to RANK and activating downstream signaling pathways to osteoclast precursors, causing further bone resorption. Measurements of bone product turnover (including N-telopeptide) decrease during treatment with denosumab.
RECOMMENDED READINGS
12. [Gül G, Sendur MA, Aksoy S, Sever AR, Altundag K. A comprehensive review of denosumab for bone metastasis in patients with solid tumors. Curr Med Res Opin. 2016 Jan;32(1):133-45. doi: 10.1185/03007995.2015.1105795. Epub 2015 Nov 25. PubMed PMID: 26451465. ](http://www.ncbi.nlm.nih.gov/pubmed/26451465)[View Abstract ](http://www.ncbi.nlm.nih.gov/pubmed/26451465)[at](http://www.ncbi.nlm.nih.gov/pubmed/26451465)
[PubMed](http://www.ncbi.nlm.nih.gov/pubmed/26451465)
13. [De Castro J, García R, Garrido P, Isla D, Massuti B, Blanca B, Vázquez J. Therapeutic Potential of Denosumab in Patients With Lung Cancer: Beyond Prevention of Skeletal Complications. Clin Lung Cancer. 2015 Nov;16(6):431-46. doi: 10.1016/j.cllc.2015.06.004. Epub 2015 Jun 25. Review. PubMed PMID: 26264596. ](http://www.ncbi.nlm.nih.gov/pubmed/26264596)[View Abstract at PubMed](http://www.ncbi.nlm.nih.gov/pubmed/26264596)
RESPONSES FOR QUESTIONS 26 THROUGH 31
1. Ultrasound
2. MRI with and without contrast
3. Chest CT scan and whole-body bone scan
4. Positron emission tomography (PET)
5. Presurgical radiation therapy
6. Marginal resection
7. Transverse incisional biopsy centered over the mass
8. Incisional biopsy centered over the mass in line with the long axis of the limb
9. Sentinel node biopsy
10. Core needle biopsy
For each clinical scenario or question below, select the most appropriate evaluation or treatment step listed above.
Osteoblasts produce osteoprotegerin, which stimulates osteoclasts to induce apoptosis by acting as a decoy for RANKL, preventing the binding of RANKL to RANK. Osteoprotegerin also binds to other TNF-related apoptosis-inducing ligands and other TNF members including TNF-a, TNF-B, and CD40 ligand. Denosumab does not bind to any other TNF members.
Breast cancer metastases produce cytokines that induce osteoblasts to express elevated levels of RANKL, stimulating osteoclastogenesis via binding to RANK and activating downstream signaling pathways to osteoclast precursors, causing further bone resorption. Measurements of bone product turnover (including N-telopeptide) decrease during treatment with denosumab.
RECOMMENDED READINGS
12. [Gül G, Sendur MA, Aksoy S, Sever AR, Altundag K. A comprehensive review of denosumab for bone metastasis in patients with solid tumors. Curr Med Res Opin. 2016 Jan;32(1):133-45. doi: 10.1185/03007995.2015.1105795. Epub 2015 Nov 25. PubMed PMID: 26451465. ](http://www.ncbi.nlm.nih.gov/pubmed/26451465)[View Abstract ](http://www.ncbi.nlm.nih.gov/pubmed/26451465)[at](http://www.ncbi.nlm.nih.gov/pubmed/26451465)
[PubMed](http://www.ncbi.nlm.nih.gov/pubmed/26451465)
13. [De Castro J, García R, Garrido P, Isla D, Massuti B, Blanca B, Vázquez J. Therapeutic Potential of Denosumab in Patients With Lung Cancer: Beyond Prevention of Skeletal Complications. Clin Lung Cancer. 2015 Nov;16(6):431-46. doi: 10.1016/j.cllc.2015.06.004. Epub 2015 Jun 25. Review. PubMed PMID: 26264596. ](http://www.ncbi.nlm.nih.gov/pubmed/26264596)[View Abstract at PubMed](http://www.ncbi.nlm.nih.gov/pubmed/26264596)
RESPONSES FOR QUESTIONS 26 THROUGH 31
1. Ultrasound
2. MRI with and without contrast
3. Chest CT scan and whole-body bone scan
4. Positron emission tomography (PET)
5. Presurgical radiation therapy
6. Marginal resection
7. Transverse incisional biopsy centered over the mass
8. Incisional biopsy centered over the mass in line with the long axis of the limb
9. Sentinel node biopsy
10. Core needle biopsy
For each clinical scenario or question below, select the most appropriate evaluation or treatment step listed above.
QUESTION 26
of 100
Figure 26 is the posteroranterior chest radiograph of a 76-year-old man with an atraumatic gradually enlarging mass overlying his left clavicle that has been present for 6 months. There are no changes in overlying skin. His only noteworthy medical history involves facial squamous cell carcinomas that have been successfully removed surgically.

Figure 26 is the posteroranterior chest radiograph of a 76-year-old man with an atraumatic gradually enlarging mass overlying his left clavicle that has been present for 6 months. There are no changes in overlying skin. His only noteworthy medical history involves facial squamous cell carcinomas that have been successfully removed surgically.

1
Ultrasound
2
MRI with and without contrast
3
Chest CT scan and whole-body bone scan
4
Positron emission tomography (PET)
5
Presurgical radiation therapy
- MRI with and without contrast_
QUESTION 27
of 100
A 63-year-old man with right hip pain was followed 8 years ago for an incidental intraosseous lesion in the right periacetabular and ischial region that was isointense with fat on all images. He was discharged from follow-up after 3 years when no change was documented. He began experiencing pain in his hip, and a bone scan showed grade 3 uptake. New MR imaging was obtained, and an axial image at the level of the hip is shown in Figure 27. A PET/CT scan shows dramatic activity in the lesion without any other area of activity.

A 63-year-old man with right hip pain was followed 8 years ago for an incidental intraosseous lesion in the right periacetabular and ischial region that was isointense with fat on all images. He was discharged from follow-up after 3 years when no change was documented. He began experiencing pain in his hip, and a bone scan showed grade 3 uptake. New MR imaging was obtained, and an axial image at the level of the hip is shown in Figure 27. A PET/CT scan shows dramatic activity in the lesion without any other area of activity.

1
Ultrasound
2
MRI with and without contrast
3
Chest CT scan and whole-body bone scan
4
Positron emission tomography (PET)
5
Presurgical radiation therapy
- Core needle biopsy_
QUESTION 28
of 100
Figure 28 is the MR image of a 65-year-old man with an American Joint Committee on Cancer III anterior arm pleomorphic intermediate- to high-grade sarcoma. The patient is now considering treatment options. He underwent a wide excision at an outside hospital 2 years previously. The treating surgeon recommended an amputation, and the patient is now seeking a second opinion. Imaging studies reveal no other sites of disease.


Figure 28 is the MR image of a 65-year-old man with an American Joint Committee on Cancer III anterior arm pleomorphic intermediate- to high-grade sarcoma. The patient is now considering treatment options. He underwent a wide excision at an outside hospital 2 years previously. The treating surgeon recommended an amputation, and the patient is now seeking a second opinion. Imaging studies reveal no other sites of disease.


1
Ultrasound
2
MRI with and without contrast
3
Chest CT scan and whole-body bone scan
4
Positron emission tomography (PET)
5
Presurgical radiation therapy
- Presurgical radiation therapy_
**Question 29 of 100**
Figure 29 is the MR image of a 44-year-old woman who elects surgical treatment of an intramuscular lipoma in her dominant right arm.
1. Ultrasound
2. MRI with and without contrast
3. Chest CT scan and whole-body bone scan
4. Positron emission tomography (PET)
5. Presurgical radiation therapy
6. Marginal resection
7. Transverse incisional biopsy centered over the mass
8. Incisional biopsy centered over the mass in line with the long axis of the limb
9. Sentinel node biopsy
10. Core needle biopsy
_PREFERRED RESPONSE: 6- Marginal resection_
**Question 29 of 100**
Figure 29 is the MR image of a 44-year-old woman who elects surgical treatment of an intramuscular lipoma in her dominant right arm.
1. Ultrasound
2. MRI with and without contrast
3. Chest CT scan and whole-body bone scan
4. Positron emission tomography (PET)
5. Presurgical radiation therapy
6. Marginal resection
7. Transverse incisional biopsy centered over the mass
8. Incisional biopsy centered over the mass in line with the long axis of the limb
9. Sentinel node biopsy
10. Core needle biopsy
_PREFERRED RESPONSE: 6- Marginal resection_
QUESTION 29
of 100
Figure 30 is the MR image of a 29-year-old man with a large and enlarging thigh mass. Needle biopsy findings are inconclusive.

Figure 30 is the MR image of a 29-year-old man with a large and enlarging thigh mass. Needle biopsy findings are inconclusive.

1
Marginal resection
2
Transverse incisional biopsy centered over the mass
3
Incisional biopsy centered over the mass in line with the long axis of the limb
4
Sentinel node biopsy
5
Core needle biopsy

- Incisional biopsy centered over the mass in line with the long axis of the limb_
QUESTION 30
of 100
Figure 31 is the sagittal MR image of a 30-year-old man with a clear-cell sarcoma of the foot. There is no evidence of disease elsewhere after standard staging of a soft-tissue sarcoma.

Figure 31 is the sagittal MR image of a 30-year-old man with a clear-cell sarcoma of the foot. There is no evidence of disease elsewhere after standard staging of a soft-tissue sarcoma.

1
Marginal resection
2
Transverse incisional biopsy centered over the mass
3
Incisional biopsy centered over the mass in line with the long axis of the limb
4
Sentinel node biopsy
5
Core needle biopsy
For patients with rapidly enlarging painless masses, particularly those that are either large or deep, the diagnosis of a soft-tissue sarcoma should be entertained. Masses exceeding 5 cm in largest dimension that are subfascial and heterogenous on MRI are concerning. MRI with and without contrast is the preferred imaging modality for evaluation of soft-tissue sarcomas because it can delineate location of the lesion, involvement of neurovascular structures, intra-articular involvement, and underlying signal alteration in the osseous structures. Most patients can relate the onset of their symptoms to a traumatic event, and the interpretation of an MRI may include a hematoma. Ultrasound is more commonly used to confirm the clinical impression of a cyst and to distinguish cystic from solid masses.
A core needle biopsy can easily be performed in an outpatient setting or with image guidance to aid in the diagnosis. Core needle biopsies preserve the architectural relationship of cells, which is important in the diagnosis of mesenchymal lesions. A core needle biopsy is appropriate for soft-tissue lesions and osseous lesions and should be performed in a multidisciplinary setting with a surgeon performing the resection so unnecessary compartmental contamination is not introduced into the needle tract.
A fine-needle aspiration allows cytologic but not histologic analysis and generally is not favored for the diagnosis of a sarcoma. If an open biopsy is performed, the incision must be oriented in line with the long axis of the extremity to minimize contamination of surrounding structures. Meticulous hemostasis and closure of the tumor pseudocapsule must be achieved to minimize local tissue contamination. An open biopsy is commonly used if an initial needle biopsy is nondiagnostic. Transverse biopsy incisions should not be used.
Presurgical radiation for sarcomas is advantageous to decrease the field of radiation and overall radiation dose, but a significant postsurgical wound-healing complication rate (up to 35%) is associated with presurgical radiation therapy.
Staging of sarcomas is important to help predict prognosis. Not all sarcomas are reliably positive on a PET scan, so the preferred staging studies are CT scan of the chest and whole-body bone scan. Hematogenous spread of sarcomas is the most common route of metastatic disease, which speaks to the value of chest CT scans. Clear-cell sarcomas (in addition to synovial sarcoma, angiosarcoma, epithelioid sarcoma, and rhabdomyosarcoma) tend to involve lymphatic nodal metastatic disease, so sentinel node biopsy is considered when assessing these tumors. Evidence supports efficacy of sentinel node biopsy for clear-cell sarcomas in particular.
RECOMMENDED READINGS
1. Edge SB, Byrd DR, Compton CC, Fritz AG, Greene FL, Trotti A, eds. _AJCC Cancer Staging Manual_. 7th ed. New York, NY: Springer; 2010.
2. [Arbeit JM, Hilaris BS, Brennan MF. Wound complications in the multimodality treatment of extremity and superficial truncal sarcomas. J Clin Oncol. 1987 Mar;5(3):480-8.](http://www.ncbi.nlm.nih.gov/pubmed/3819810)[View Abstract at PubMed](http://www.ncbi.nlm.nih.gov/pubmed/3819810)
3. [Luce EA. The irradiated wound. Surg Clin North Am. 1984 Aug;64(4):821-9. PubMed PMID: 6591499. ](http://www.ncbi.nlm.nih.gov/pubmed/6591499)[View Abstract at PubMed](http://www.ncbi.nlm.nih.gov/pubmed/6591499)
4. [Cheng EY, Dusenbery KE, Winters MR, Thompson RC. Soft tissue sarcomas: preoperative versus postoperative radiotherapy. J Surg Oncol. 1996 Feb;61(2):90-9.](http://www.ncbi.nlm.nih.gov/pubmed/8606553)[View Abstract at PubMed](http://www.ncbi.nlm.nih.gov/pubmed/8606553)
5. [Mankin HJ, Lange TA, Spanier SS. The hazards of biopsy in patients with malignant primary bone and soft-tissue tumors. J Bone Joint Surg Am. 1982 Oct;64(8):1121-7. ](http://www.ncbi.nlm.nih.gov/pubmed/7130225)[View Abstract at PubMed](http://www.ncbi.nlm.nih.gov/pubmed/7130225)
6. Singer S, Nielsen T, Antonescu CR. Molecular biology of soft tissue sarcoma. In: DeVita VT Jr, Lawrence TS, Rosenberg SA, eds. _Cancer: Principles and Practice of Oncology_. 9th ed. Philadelphia, PA: Lippincott Williams & Wilkins; 2011:1522-1532.
7. Singer S, Maki RG, O'Sullivan B. Soft tissue sarcoma. In: DeVita VT Jr, Lawrence TS, Rosenberg SA, eds. _Cancer: Principles and Practice of Oncology_. 9th ed. Philadelphia, PA: Lippincott Williams & Wilkins; 2011:1533-1577.
8. Malawer MM, Helman LJ, O'Sullivan B. Sarcomas of bone. In: DeVita VT Jr, Lawrence TS, Rosenberg SA, eds. _Cancer: Principles and Practice of Oncology_. 9th ed. Philadelphia, PA: Lippincott Williams & Wilkins; 2011:1578-1609.
9. [O'Sullivan B, Davis AM, Turcotte R, Bell R, Catton C, Chabot P, Wunder J, Kandel R, Goddard K, Sadura A, Pater J, Zee B. Preoperative versus postoperative radiotherapy in soft-tissue sarcoma of the limbs: a randomised trial. Lancet. 2002 Jun 29;359(9325):2235-41. ](http://www.ncbi.nlm.nih.gov/pubmed/12103287)[View Abstract at PubMed](http://www.ncbi.nlm.nih.gov/pubmed/12103287)
10. [Andreou D, Boldt H, Werner M, Hamann C, Pink D, Tunn PU. Sentinel node biopsy in soft tissue sarcoma subtypes with a high propensity for regional lymphatic spread--results of a large prospective trial. Ann Oncol. 2013 May;24(5):1400-5. doi: 10.1093/annonc/mds650. Epub 2013 Jan 31. PubMed PMID: 23372051. ](http://www.ncbi.nlm.nih.gov/pubmed/23372051)[View Abstract at PubMed](http://www.ncbi.nlm.nih.gov/pubmed/23372051)
A core needle biopsy can easily be performed in an outpatient setting or with image guidance to aid in the diagnosis. Core needle biopsies preserve the architectural relationship of cells, which is important in the diagnosis of mesenchymal lesions. A core needle biopsy is appropriate for soft-tissue lesions and osseous lesions and should be performed in a multidisciplinary setting with a surgeon performing the resection so unnecessary compartmental contamination is not introduced into the needle tract.
A fine-needle aspiration allows cytologic but not histologic analysis and generally is not favored for the diagnosis of a sarcoma. If an open biopsy is performed, the incision must be oriented in line with the long axis of the extremity to minimize contamination of surrounding structures. Meticulous hemostasis and closure of the tumor pseudocapsule must be achieved to minimize local tissue contamination. An open biopsy is commonly used if an initial needle biopsy is nondiagnostic. Transverse biopsy incisions should not be used.
Presurgical radiation for sarcomas is advantageous to decrease the field of radiation and overall radiation dose, but a significant postsurgical wound-healing complication rate (up to 35%) is associated with presurgical radiation therapy.
Staging of sarcomas is important to help predict prognosis. Not all sarcomas are reliably positive on a PET scan, so the preferred staging studies are CT scan of the chest and whole-body bone scan. Hematogenous spread of sarcomas is the most common route of metastatic disease, which speaks to the value of chest CT scans. Clear-cell sarcomas (in addition to synovial sarcoma, angiosarcoma, epithelioid sarcoma, and rhabdomyosarcoma) tend to involve lymphatic nodal metastatic disease, so sentinel node biopsy is considered when assessing these tumors. Evidence supports efficacy of sentinel node biopsy for clear-cell sarcomas in particular.
RECOMMENDED READINGS
1. Edge SB, Byrd DR, Compton CC, Fritz AG, Greene FL, Trotti A, eds. _AJCC Cancer Staging Manual_. 7th ed. New York, NY: Springer; 2010.
2. [Arbeit JM, Hilaris BS, Brennan MF. Wound complications in the multimodality treatment of extremity and superficial truncal sarcomas. J Clin Oncol. 1987 Mar;5(3):480-8.](http://www.ncbi.nlm.nih.gov/pubmed/3819810)[View Abstract at PubMed](http://www.ncbi.nlm.nih.gov/pubmed/3819810)
3. [Luce EA. The irradiated wound. Surg Clin North Am. 1984 Aug;64(4):821-9. PubMed PMID: 6591499. ](http://www.ncbi.nlm.nih.gov/pubmed/6591499)[View Abstract at PubMed](http://www.ncbi.nlm.nih.gov/pubmed/6591499)
4. [Cheng EY, Dusenbery KE, Winters MR, Thompson RC. Soft tissue sarcomas: preoperative versus postoperative radiotherapy. J Surg Oncol. 1996 Feb;61(2):90-9.](http://www.ncbi.nlm.nih.gov/pubmed/8606553)[View Abstract at PubMed](http://www.ncbi.nlm.nih.gov/pubmed/8606553)
5. [Mankin HJ, Lange TA, Spanier SS. The hazards of biopsy in patients with malignant primary bone and soft-tissue tumors. J Bone Joint Surg Am. 1982 Oct;64(8):1121-7. ](http://www.ncbi.nlm.nih.gov/pubmed/7130225)[View Abstract at PubMed](http://www.ncbi.nlm.nih.gov/pubmed/7130225)
6. Singer S, Nielsen T, Antonescu CR. Molecular biology of soft tissue sarcoma. In: DeVita VT Jr, Lawrence TS, Rosenberg SA, eds. _Cancer: Principles and Practice of Oncology_. 9th ed. Philadelphia, PA: Lippincott Williams & Wilkins; 2011:1522-1532.
7. Singer S, Maki RG, O'Sullivan B. Soft tissue sarcoma. In: DeVita VT Jr, Lawrence TS, Rosenberg SA, eds. _Cancer: Principles and Practice of Oncology_. 9th ed. Philadelphia, PA: Lippincott Williams & Wilkins; 2011:1533-1577.
8. Malawer MM, Helman LJ, O'Sullivan B. Sarcomas of bone. In: DeVita VT Jr, Lawrence TS, Rosenberg SA, eds. _Cancer: Principles and Practice of Oncology_. 9th ed. Philadelphia, PA: Lippincott Williams & Wilkins; 2011:1578-1609.
9. [O'Sullivan B, Davis AM, Turcotte R, Bell R, Catton C, Chabot P, Wunder J, Kandel R, Goddard K, Sadura A, Pater J, Zee B. Preoperative versus postoperative radiotherapy in soft-tissue sarcoma of the limbs: a randomised trial. Lancet. 2002 Jun 29;359(9325):2235-41. ](http://www.ncbi.nlm.nih.gov/pubmed/12103287)[View Abstract at PubMed](http://www.ncbi.nlm.nih.gov/pubmed/12103287)
10. [Andreou D, Boldt H, Werner M, Hamann C, Pink D, Tunn PU. Sentinel node biopsy in soft tissue sarcoma subtypes with a high propensity for regional lymphatic spread--results of a large prospective trial. Ann Oncol. 2013 May;24(5):1400-5. doi: 10.1093/annonc/mds650. Epub 2013 Jan 31. PubMed PMID: 23372051. ](http://www.ncbi.nlm.nih.gov/pubmed/23372051)[View Abstract at PubMed](http://www.ncbi.nlm.nih.gov/pubmed/23372051)
QUESTION 31
of 100
Figures 32a through 32d are the radiographs and MR images of a 13-year-old girl with new posterolateral knee pain following a fall. What is the best next step?




Figures 32a through 32d are the radiographs and MR images of a 13-year-old girl with new posterolateral knee pain following a fall. What is the best next step?




1
Percutaneous biopsy
2
Open curettage and grafting
3
Referral to a musculoskeletal oncologist
4
Observation with follow-up radiographs




This patient has an incidentally noted benign-appearing fibro-osseous lesion of her proximal tibia. The lesion does not correspond to her area of pain, and there is no indication she experienced pain from the lesion prior to the fall. Radiographs and MR imaging findings are consistent with a fibrous cortical defect or nonossifying fibroma. There is no surrounding edema in the bone or soft tissue and no soft-tissue mass, and the lesion has a sclerotic rim around it. These are common lesions in children, and there is no need for a biopsy, curettage, or referral to a tumor specialist. This patient should not be at high risk for pathologic fracture from this lesion. Observation with follow-up radiographs in 3 to 6 months is the treatment of choice.
RECOMMENDED READINGS
11. [Gebhardt MC, Ready JE, Mankin HJ. Tumors about the knee in children. Clin Orthop Relat Res. 1990 Jun;(255):86-110. Review. PubMed PMID: 2189635.](http://www.ncbi.nlm.nih.gov/pubmed/2189635)[View Abstract at PubMed](http://www.ncbi.nlm.nih.gov/pubmed/2189635)
12. [Aboulafia AJ, Kennon RE, Jelinek JS. Benign bone tumors of childhood. J Am Acad Orthop Surg. 1999 Nov-Dec;7(6):377-88. Review. PubMed PMID: 11505926. ](http://www.ncbi.nlm.nih.gov/pubmed/11505926)[View Abstract at PubMed](http://www.ncbi.nlm.nih.gov/pubmed/11505926)
RECOMMENDED READINGS
11. [Gebhardt MC, Ready JE, Mankin HJ. Tumors about the knee in children. Clin Orthop Relat Res. 1990 Jun;(255):86-110. Review. PubMed PMID: 2189635.](http://www.ncbi.nlm.nih.gov/pubmed/2189635)[View Abstract at PubMed](http://www.ncbi.nlm.nih.gov/pubmed/2189635)
12. [Aboulafia AJ, Kennon RE, Jelinek JS. Benign bone tumors of childhood. J Am Acad Orthop Surg. 1999 Nov-Dec;7(6):377-88. Review. PubMed PMID: 11505926. ](http://www.ncbi.nlm.nih.gov/pubmed/11505926)[View Abstract at PubMed](http://www.ncbi.nlm.nih.gov/pubmed/11505926)
QUESTION 32
of 100
Figures 33a through 33d are the radiograph, MR images, and biopsy specimen of a 66-year-old woman with a several-month history of an enlarging thigh mass after “pulling a muscle” while playing softball. Several weeks ago her physician aspirated the cyst, but the result is no change. Treatment of this lesion should include




Figures 33a through 33d are the radiograph, MR images, and biopsy specimen of a 66-year-old woman with a several-month history of an enlarging thigh mass after “pulling a muscle” while playing softball. Several weeks ago her physician aspirated the cyst, but the result is no change. Treatment of this lesion should include




1
embolization.
2
reaspiration and observation.
3
radiation therapy alone.
4
radiation therapy and surgery.




This patient’s imaging and biopsy specimen are consistent with a high-grade undifferentiated pleomorphic sarcoma (UPS). Histologically, UPS is characterized by high cellularity, marked nuclear pleomorphism, abundant mitotic activity (including atypical mitoses), and a spindle cell morphology. Necrosis is common and characteristic of high-grade lesions. Treatment consists of wide surgical excision and, in almost all cases, radiation. Radiation eliminates the need for limb amputation, and there is level I evidence to show that it leads to equivalent rates of survival. Radiation may be delivered either before or after surgery depending on the surgeon’s and multidisciplinary tumor board’s recommendations. There may be a role for presurgical embolization in some cases of high-grade soft-tissue sarcoma, but this is not appropriate as a standalone treatment. Chemotherapy provides limited survival improvement in adults with high-grade soft-tissue sarcomas.
RECOMMENDED READINGS
13. [Bell RS, O'Sullivan B, Davis A, Langer F, Cummings B, Fornasier VL. Functional outcome in patients treated with surgery and irradiation for soft tissue tumours. J Surg Oncol. 1991 Dec;48(4):224-31. PubMed PMID: 1745046. ](http://www.ncbi.nlm.nih.gov/pubmed/1745046)[View Abstract at PubMed](http://www.ncbi.nlm.nih.gov/pubmed/1745046)
14. [O'Sullivan B, Wylie J, Catton C, Gutierrez E, Swallow CJ, Wunder J, Gullane P, Neligan P, Bell R. The local management of soft tissue sarcoma. Semin Radiat Oncol. 1999 Oct;9(4):328-48. Review. PubMed PMID: 10516380. ](http://www.ncbi.nlm.nih.gov/pubmed/10516380)[View Abstract at PubMed](http://www.ncbi.nlm.nih.gov/pubmed/10516380)
RECOMMENDED READINGS
13. [Bell RS, O'Sullivan B, Davis A, Langer F, Cummings B, Fornasier VL. Functional outcome in patients treated with surgery and irradiation for soft tissue tumours. J Surg Oncol. 1991 Dec;48(4):224-31. PubMed PMID: 1745046. ](http://www.ncbi.nlm.nih.gov/pubmed/1745046)[View Abstract at PubMed](http://www.ncbi.nlm.nih.gov/pubmed/1745046)
14. [O'Sullivan B, Wylie J, Catton C, Gutierrez E, Swallow CJ, Wunder J, Gullane P, Neligan P, Bell R. The local management of soft tissue sarcoma. Semin Radiat Oncol. 1999 Oct;9(4):328-48. Review. PubMed PMID: 10516380. ](http://www.ncbi.nlm.nih.gov/pubmed/10516380)[View Abstract at PubMed](http://www.ncbi.nlm.nih.gov/pubmed/10516380)
QUESTION 33
of 100
A 79-year-old woman is seen for follow-up of a right arm posterior compartment high-grade soft-tissue sarcoma after undergoing wide resection of the tumor with preservation of the radial nerve
and minimal stripping of the posterior humeral periosteum. She then received 70 Gy of postsurgical radiation. Local recurrence occurred 4 years later, and she was treated with re-resection and adjuvant doxorubicin and ifosfamide chemotherapy. At that time, she learned she had osteoporosis and was treated with alendronate. She experienced an atraumatic fracture 2 years later without evidence of local recurrence. Which treatment poses highest risk for fracture in this scenario?

A 79-year-old woman is seen for follow-up of a right arm posterior compartment high-grade soft-tissue sarcoma after undergoing wide resection of the tumor with preservation of the radial nerve
and minimal stripping of the posterior humeral periosteum. She then received 70 Gy of postsurgical radiation. Local recurrence occurred 4 years later, and she was treated with re-resection and adjuvant doxorubicin and ifosfamide chemotherapy. At that time, she learned she had osteoporosis and was treated with alendronate. She experienced an atraumatic fracture 2 years later without evidence of local recurrence. Which treatment poses highest risk for fracture in this scenario?

1
Chronic oral bisphosphonate use
2
Doxorubicin and ifosfamide chemotherapy
3
Timing and dose of radiation
4
Surgical periosteal stripping
Although postsurgical radiation is associated with lower rates of wound complication, radiation that is administered after surgery necessitates higher radiation doses and a larger tissue field than radiation administered before surgery. Risk for radiation-associated fracture increases with larger fields and higher doses. Retrospective studies have demonstrated increased fracture risk with postsurgical radiation doses of at least 60 Gy compared with presurgical radiation doses of 50 Gy. The influence of periosteal stripping on fracture risk is controversial. In a series of patients receiving primarily postsurgical radiation, extensive stripping was an accepted risk factor, but it was not found to be a significant risk factor in a more recent analysis of patients receiving lower-dose presurgical radiation. Cytotoxic chemotherapy is detrimental to healing of established fractures but does not correlate with risk for fracture in soft-tissue sarcoma. Chronic bisphosphonate use is associated with atypical fractures, but the location, timing, and radiographic appearance in this scenario are not consistent with this etiology.
RECOMMENDED READINGS
15. Gortzak Y, Lockwood GA, Mahendra A, Wang Y, Chung PW, Catton CN, O'Sullivan B, Deheshi BM, [Wunder JS, Ferguson PC. Prediction of pathologic fracture risk of the femur after combined modality treatment of soft tissue sarcoma of the thigh. Cancer. 2010 Mar 15;116(6):1553-9. doi: 10.1002/cncr.24949. PubMed PMID: 20108335.](http://www.ncbi.nlm.nih.gov/pubmed/20108335)[View Abstract at PubMed](http://www.ncbi.nlm.nih.gov/pubmed/20108335)
16. Haas RL, Delaney TF, O'Sullivan B, Keus RB, Le Pechoux C, Olmi P, Poulsen JP, Seddon B, Wang
[D. Radiotherapy for management of extremity soft tissue sarcomas: why, when, and where? Int J Radiat Oncol Biol Phys. 2012 Nov 1;84(3):572-80. doi: 10.1016/j.ijrobp.2012.01.062. Epub 2012 Apr 18. Review. PubMed PMID: 22520481.](http://www.ncbi.nlm.nih.gov/pubmed/22520481)[View Abstract at PubMed](http://www.ncbi.nlm.nih.gov/pubmed/22520481)
17. [Holt GE, Griffin AM, Pintilie M, Wunder JS, Catton C, O'Sullivan B, Bell RS. Fractures following radiotherapy and limb-salvage surgery for lower extremity soft-tissue sarcomas. A comparison of high-dose and low-dose radiotherapy. J Bone Joint Surg Am. 2005 Feb;87(2):315-9. PubMed PMID: 15687153. ](http://www.ncbi.nlm.nih.gov/pubmed/15687153)[View Abstract at PubMed](http://www.ncbi.nlm.nih.gov/pubmed/15687153)
18. [Helmstedter CS, Goebel M, Zlotecki R, Scarborough MT. Pathologic fractures after surgery and radiation for soft tissue tumors. Clin Orthop Relat Res. 2001 Aug;(389):165-72. PubMed PMID: 11501806. ](http://www.ncbi.nlm.nih.gov/pubmed/11501806)[View Abstract at PubMed](http://www.ncbi.nlm.nih.gov/pubmed/11501806)
CLINICAL SITUATION FOR QUESTIONS 35 THROUGH 37
Figure 35 is the intraoperative finding of a 28-year-old man with a recurrent nontraumatic effusion who undergoes arthroscopy.
RECOMMENDED READINGS
15. Gortzak Y, Lockwood GA, Mahendra A, Wang Y, Chung PW, Catton CN, O'Sullivan B, Deheshi BM, [Wunder JS, Ferguson PC. Prediction of pathologic fracture risk of the femur after combined modality treatment of soft tissue sarcoma of the thigh. Cancer. 2010 Mar 15;116(6):1553-9. doi: 10.1002/cncr.24949. PubMed PMID: 20108335.](http://www.ncbi.nlm.nih.gov/pubmed/20108335)[View Abstract at PubMed](http://www.ncbi.nlm.nih.gov/pubmed/20108335)
16. Haas RL, Delaney TF, O'Sullivan B, Keus RB, Le Pechoux C, Olmi P, Poulsen JP, Seddon B, Wang
[D. Radiotherapy for management of extremity soft tissue sarcomas: why, when, and where? Int J Radiat Oncol Biol Phys. 2012 Nov 1;84(3):572-80. doi: 10.1016/j.ijrobp.2012.01.062. Epub 2012 Apr 18. Review. PubMed PMID: 22520481.](http://www.ncbi.nlm.nih.gov/pubmed/22520481)[View Abstract at PubMed](http://www.ncbi.nlm.nih.gov/pubmed/22520481)
17. [Holt GE, Griffin AM, Pintilie M, Wunder JS, Catton C, O'Sullivan B, Bell RS. Fractures following radiotherapy and limb-salvage surgery for lower extremity soft-tissue sarcomas. A comparison of high-dose and low-dose radiotherapy. J Bone Joint Surg Am. 2005 Feb;87(2):315-9. PubMed PMID: 15687153. ](http://www.ncbi.nlm.nih.gov/pubmed/15687153)[View Abstract at PubMed](http://www.ncbi.nlm.nih.gov/pubmed/15687153)
18. [Helmstedter CS, Goebel M, Zlotecki R, Scarborough MT. Pathologic fractures after surgery and radiation for soft tissue tumors. Clin Orthop Relat Res. 2001 Aug;(389):165-72. PubMed PMID: 11501806. ](http://www.ncbi.nlm.nih.gov/pubmed/11501806)[View Abstract at PubMed](http://www.ncbi.nlm.nih.gov/pubmed/11501806)
CLINICAL SITUATION FOR QUESTIONS 35 THROUGH 37
Figure 35 is the intraoperative finding of a 28-year-old man with a recurrent nontraumatic effusion who undergoes arthroscopy.
QUESTION 34
of 100
A neoplasm that involves rearrangements of 1p13 involving the colony-stimulating factor 1 (CSF1) gene which, when expressed, causes proliferation of neoplastic cells and the recruitment of monocyte-macrophage non-neoplastic cells is
A neoplasm that involves rearrangements of 1p13 involving the colony-stimulating factor 1 (CSF1) gene which, when expressed, causes proliferation of neoplastic cells and the recruitment of monocyte-macrophage non-neoplastic cells is
1
a tenosynovial giant-cell tumor.
2
a nodular fasciitis.
3
an infantile fibrosarcoma.
4
an inflammatory myofibroblastic tumor.
- a tenosynovial giant-cell tumor._
QUESTION 35
of 100
This tumor has been recently treated in phase 1 trials with molecularly targeted therapies including a conformation-specific inhibitor of CSF1 receptor (CSF1R), resulting in at least a 50% reduction of tumor volume in some patients. This type of inhibitor is further defined as
This tumor has been recently treated in phase 1 trials with molecularly targeted therapies including a conformation-specific inhibitor of CSF1 receptor (CSF1R), resulting in at least a 50% reduction of tumor volume in some patients. This type of inhibitor is further defined as
1
a tyrosine kinase inhibitor.
2
a substrate binding synthetic molecule.
3
an anti-CSF1R antibody.
4
an anti-CSF1 antibody
- a substrate binding synthetic molecule._
QUESTION 36
of 100
What is the neoplastic cell of origin for this tumor?
What is the neoplastic cell of origin for this tumor?
1
Lymphocyte
2
Monocyte
3
Macrophage
4
Mononuclear phagocyte
Tenosynovial giant-cell tumors are widely known as pigmented villonodular synovitis (PVNS), although this term is misleading because this tumor type is a clonal neoplasm and does not involve an inflammatory process. It often is shown to have a t(1:2)(p13q37) karyotype resulting in CSF1-COL6A3 gene fusion. There are various amounts of mononuclear cells, osteoclastlike giant cells, foamy histiocytes, hemosiderophages, and chronic inflammatory cells. Local recurrences are common, but CSF1R inhibitors are being investigated in studies involving local control improvement and disease regression.
Targeted therapy trials to assist in control of the diffuse-type tenosynovial giant-cell tumor (formerly called PVNS) involve the use of monoclonal antibodies that inhibit CSF1R activation. CSF1R-expressing mononuclear phagocytes are affected by these monoclonal antibodies.
Infantile fibrosarcoma is associated with the t(12;15)(p13;q25) karyotype and ETV6-NTRK3 gene fusion product. Nodular fasciitis is associated with the t(17;22)(p13;q13.1) karyotype and MYH9-USP6 gene fusion product. Inflammatory myofibroblastic tumor is associated with translocations involving 2p23 resulting in multiple fusion products of ALK with TPM4 (19p13.1), TPM3 (1q21), CLTC (17q23), RANBP2 (2q13), ATIC (2q35), SEC31A (4q21), and CARS (11p15). No
nonpreferred response has a histologic appearance that includes hemosiderin, foamy histiocytes, and osteoclastlike giant cells.
A conformation-specific inhibitor of the juxtamembrane region of CSF1R is a synthetic molecule that is designed to access the autoinhibited state of the receptor through direct interactions with the juxtamembrane residues embedded in the adenosine 5’-triphosphate-binding pocket. It is designed to bind in the regulatory a-helix of the N-terminal lobe of the kinase domain in neoplastic cells of tenosynovial giant-cell tumor that have expression of the CSF1 gene. There is a structural plasticity of the domain of the CSF1R that allows the molecule to directly bind the autoinhibited state of CSF1R.
Another approach involves the development of the anti-CSF1R antibody, emactuzumab, which targets tumor-associated macrophages. A lower percentage of volume reduction has been reported with imatinib, a tyrosine kinase inhibitor. Alkylating agents have not been used in this benign neoplasm.
Tenosynovial giant-cell tumor is characterized by an overexpression of CSF1. CSF1R activation leads to recruitment of CSF1R-expressing cells of the mononuclear phagocyte lineage.
RECOMMENDED READINGS
1. [Cassier PA, Gelderblom H, Stacchiotti S, Thomas D, Maki RG, Kroep JR, van der Graaf WT, Italiano A, Seddon B, Dômont J, Bompas E, Wagner AJ, Blay JY. Efficacy of imatinib mesylate for the treatment of locally advanced and/or metastatic tenosynovial giant cell tumor/pigmented villonodular synovitis. Cancer. 2012 Mar 15;118(6):1649-55. doi: 10.1002/cncr.26409. Epub 2011 Aug 5. PubMed PMID: 21823110. ](http://www.ncbi.nlm.nih.gov/pubmed/21823110)[View Abstract at PubMed](http://www.ncbi.nlm.nih.gov/pubmed/21823110)
2. Ladanyi M, Fletcher JA, Dal Cin P. Cytogenetic and molecular genetic pathology of soft tissue tumors. In: Goldblum JR, Folpe AL, Weis SW, eds. _Enzinger & Weiss’s Soft Tissue Tumors_. 6th ed. Philadelphia, PA: Elsevier Saunders; 2014:76-109.
3. [Staals EL, Ferrari S, Donati DM, Palmerini E. Diffuse-type tenosynovial giant cell tumour: Current treatment concepts and future perspectives. Eur J Cancer. 2016 Aug;63:34-40. doi: 10.1016/j.ejca.2016.04.022. Epub 2016 Jun 5. Review. ](http://www.ncbi.nlm.nih.gov/pubmed/27267143)[View Abstract at PubMed](http://www.ncbi.nlm.nih.gov/pubmed/27267143)
4. [Tap WD, Wainberg ZA, Anthony SP, Ibrahim PN, Zhang C, Healey JH, Chmielowski B, Staddon AP, Cohn AL, Shapiro GI, Keedy VL, Singh AS, Puzanov I, Kwak EL, Wagner AJ, Von Hoff DD, Weiss GJ, Ramanathan RK, Zhang J, Habets G, Zhang Y, Burton EA, Visor G, Sanftner L, Severson P, Nguyen H, Kim MJ, Marimuthu A, Tsang G, Shellooe R, Gee C, West BL, Hirth P, Nolop K, van de Rijn M, Hsu HH, Peterfy C, Lin PS, Tong-Starksen S, Bollag G. Structure-Guided Blockade of CSF1R Kinase in Tenosynovial Giant-Cell Tumor. N Engl J Med. 2015 Jul 30;373(5):428-37. doi:10.1056/NEJMoa1411366. PubMed PMID: 26222558. ](http://www.ncbi.nlm.nih.gov/pubmed/26222558)[View Abstract at PubMed](http://www.ncbi.nlm.nih.gov/pubmed/26222558)
5. [Ries CH, Cannarile MA, Hoves S, Benz J, Wartha K, Runza V, Rey-Giraud F, Pradel LP, Feuerhake F, Klaman I, Jones T, Jucknischke U, Scheiblich S, Kaluza K, Gorr IH, Walz A, Abiraj K, Cassier PA, Sica A, Gomez-Roca C, de Visser KE, Italiano A, Le Tourneau C, Delord JP, Levitsky H, Blay JY, Rüttinger D. Targeting tumor-associated macrophages with anti-CSF-1R antibody reveals a strategy for cancer therapy. Cancer Cell. 2014 Jun 16;25(6):846-59. doi: 10.1016/j.ccr.2014.05.016. Epub 2014 Jun 2. PubMed PMID: 24898549.](http://www.ncbi.nlm.nih.gov/pubmed/24898549)[View Abstract at PubMed](http://www.ncbi.nlm.nih.gov/pubmed/24898549)
Targeted therapy trials to assist in control of the diffuse-type tenosynovial giant-cell tumor (formerly called PVNS) involve the use of monoclonal antibodies that inhibit CSF1R activation. CSF1R-expressing mononuclear phagocytes are affected by these monoclonal antibodies.
Infantile fibrosarcoma is associated with the t(12;15)(p13;q25) karyotype and ETV6-NTRK3 gene fusion product. Nodular fasciitis is associated with the t(17;22)(p13;q13.1) karyotype and MYH9-USP6 gene fusion product. Inflammatory myofibroblastic tumor is associated with translocations involving 2p23 resulting in multiple fusion products of ALK with TPM4 (19p13.1), TPM3 (1q21), CLTC (17q23), RANBP2 (2q13), ATIC (2q35), SEC31A (4q21), and CARS (11p15). No
nonpreferred response has a histologic appearance that includes hemosiderin, foamy histiocytes, and osteoclastlike giant cells.
A conformation-specific inhibitor of the juxtamembrane region of CSF1R is a synthetic molecule that is designed to access the autoinhibited state of the receptor through direct interactions with the juxtamembrane residues embedded in the adenosine 5’-triphosphate-binding pocket. It is designed to bind in the regulatory a-helix of the N-terminal lobe of the kinase domain in neoplastic cells of tenosynovial giant-cell tumor that have expression of the CSF1 gene. There is a structural plasticity of the domain of the CSF1R that allows the molecule to directly bind the autoinhibited state of CSF1R.
Another approach involves the development of the anti-CSF1R antibody, emactuzumab, which targets tumor-associated macrophages. A lower percentage of volume reduction has been reported with imatinib, a tyrosine kinase inhibitor. Alkylating agents have not been used in this benign neoplasm.
Tenosynovial giant-cell tumor is characterized by an overexpression of CSF1. CSF1R activation leads to recruitment of CSF1R-expressing cells of the mononuclear phagocyte lineage.
RECOMMENDED READINGS
1. [Cassier PA, Gelderblom H, Stacchiotti S, Thomas D, Maki RG, Kroep JR, van der Graaf WT, Italiano A, Seddon B, Dômont J, Bompas E, Wagner AJ, Blay JY. Efficacy of imatinib mesylate for the treatment of locally advanced and/or metastatic tenosynovial giant cell tumor/pigmented villonodular synovitis. Cancer. 2012 Mar 15;118(6):1649-55. doi: 10.1002/cncr.26409. Epub 2011 Aug 5. PubMed PMID: 21823110. ](http://www.ncbi.nlm.nih.gov/pubmed/21823110)[View Abstract at PubMed](http://www.ncbi.nlm.nih.gov/pubmed/21823110)
2. Ladanyi M, Fletcher JA, Dal Cin P. Cytogenetic and molecular genetic pathology of soft tissue tumors. In: Goldblum JR, Folpe AL, Weis SW, eds. _Enzinger & Weiss’s Soft Tissue Tumors_. 6th ed. Philadelphia, PA: Elsevier Saunders; 2014:76-109.
3. [Staals EL, Ferrari S, Donati DM, Palmerini E. Diffuse-type tenosynovial giant cell tumour: Current treatment concepts and future perspectives. Eur J Cancer. 2016 Aug;63:34-40. doi: 10.1016/j.ejca.2016.04.022. Epub 2016 Jun 5. Review. ](http://www.ncbi.nlm.nih.gov/pubmed/27267143)[View Abstract at PubMed](http://www.ncbi.nlm.nih.gov/pubmed/27267143)
4. [Tap WD, Wainberg ZA, Anthony SP, Ibrahim PN, Zhang C, Healey JH, Chmielowski B, Staddon AP, Cohn AL, Shapiro GI, Keedy VL, Singh AS, Puzanov I, Kwak EL, Wagner AJ, Von Hoff DD, Weiss GJ, Ramanathan RK, Zhang J, Habets G, Zhang Y, Burton EA, Visor G, Sanftner L, Severson P, Nguyen H, Kim MJ, Marimuthu A, Tsang G, Shellooe R, Gee C, West BL, Hirth P, Nolop K, van de Rijn M, Hsu HH, Peterfy C, Lin PS, Tong-Starksen S, Bollag G. Structure-Guided Blockade of CSF1R Kinase in Tenosynovial Giant-Cell Tumor. N Engl J Med. 2015 Jul 30;373(5):428-37. doi:10.1056/NEJMoa1411366. PubMed PMID: 26222558. ](http://www.ncbi.nlm.nih.gov/pubmed/26222558)[View Abstract at PubMed](http://www.ncbi.nlm.nih.gov/pubmed/26222558)
5. [Ries CH, Cannarile MA, Hoves S, Benz J, Wartha K, Runza V, Rey-Giraud F, Pradel LP, Feuerhake F, Klaman I, Jones T, Jucknischke U, Scheiblich S, Kaluza K, Gorr IH, Walz A, Abiraj K, Cassier PA, Sica A, Gomez-Roca C, de Visser KE, Italiano A, Le Tourneau C, Delord JP, Levitsky H, Blay JY, Rüttinger D. Targeting tumor-associated macrophages with anti-CSF-1R antibody reveals a strategy for cancer therapy. Cancer Cell. 2014 Jun 16;25(6):846-59. doi: 10.1016/j.ccr.2014.05.016. Epub 2014 Jun 2. PubMed PMID: 24898549.](http://www.ncbi.nlm.nih.gov/pubmed/24898549)[View Abstract at PubMed](http://www.ncbi.nlm.nih.gov/pubmed/24898549)
QUESTION 37
of 100
Figures 38a and 38b are the radiographs of a 12-year-old girl with a slowly enlarging mass on her posterior elbow. She has an unremarkable medical history. The mass is nontender, soft, and mobile with respect to the underlying bone. Her elbow motion is supple and unrestricted. What is the most likely cause of this condition?


Figures 38a and 38b are the radiographs of a 12-year-old girl with a slowly enlarging mass on her posterior elbow. She has an unremarkable medical history. The mass is nontender, soft, and mobile with respect to the underlying bone. Her elbow motion is supple and unrestricted. What is the most likely cause of this condition?


1
Inherited abnormality of phosphate metabolism
2
Inherited abnormality of calcium metabolism
3
Renal disease with chronic renal insufficiency
4
Chronic hyperparathyroidism
The history, examination, and radiographs strongly suggest tumoral calcinosis. Inherited forms of tumoral calcinosis are often attributable to a genetic disorder involving phosphate homeostasis. Acquired tumoral calcinosis is usually secondary to chronic renal disease and dialysis with secondary hyperparathyroidism.
RECOMMENDED READINGS
6. Avedian R. Pseudotumors and tumorlike lesions. In: Biermann JS, ed. _Orthopaedic Knowledge Update Musculoskeletal Tumors 3_. Rosemont, IL: American Academy of Orthopaedic Surgeons; 2013:39-51.
7. [Olsen KM, Chew FS. Tumoral calcinosis: pearls, polemics, and alternative possibilities. Radiographics. 2006 May-Jun;26(3):871-85. Review. PubMed PMID: 16702460.](http://www.ncbi.nlm.nih.gov/pubmed/16702460)[View Abstract at PubMed](http://www.ncbi.nlm.nih.gov/pubmed/16702460)
RECOMMENDED READINGS
6. Avedian R. Pseudotumors and tumorlike lesions. In: Biermann JS, ed. _Orthopaedic Knowledge Update Musculoskeletal Tumors 3_. Rosemont, IL: American Academy of Orthopaedic Surgeons; 2013:39-51.
7. [Olsen KM, Chew FS. Tumoral calcinosis: pearls, polemics, and alternative possibilities. Radiographics. 2006 May-Jun;26(3):871-85. Review. PubMed PMID: 16702460.](http://www.ncbi.nlm.nih.gov/pubmed/16702460)[View Abstract at PubMed](http://www.ncbi.nlm.nih.gov/pubmed/16702460)
QUESTION 38
of 100
Figures 39a through 39c are the radiographs and MR image of a 14-year-old boy who has intermittent knee swelling and pain exacerbated by activity. What is the most likely diagnosis?



Figures 39a through 39c are the radiographs and MR image of a 14-year-old boy who has intermittent knee swelling and pain exacerbated by activity. What is the most likely diagnosis?



1
Vascular malformation
2
Synovial chondromatosis
3
Diffuse pigmented villonodular synovitis (PVNS)
4
Lipoma arborescens
This patient’s history does not rule out any of these diagnoses. Imaging shows multifocal areas of ropey vascular malformations with signal voids in the thigh. The MR image shows intra-articular involvement that is often the most symptomatic area in these patients. The radiographs do not show the classic phleboliths seen with venous malformations or the typical calcifications of synovial chondromatosis. Lipoma arborescens would involve an overabundance of fat throughout the joint noted on MRI, and PVNS will typically involve an effusion, diffuse synovial hyperplasia, and multiple focal nodules of disease. The appropriate treatment for intra-articular vascular malformations has not been established. Compression garments should be considered initially, with persistent symptoms warranting arthroscopic or open excision of the vascular malformations with synovectomy.
RECOMMENDED READINGS
8. [Dalmonte P, Granata C, Fulcheri E, Vercellino N, Gregorio S, Magnano G. Intra-articular venous malformations of the knee. J Pediatr Orthop. 2012 Jun;32(4):394-8. doi: 10.1097/BPO.0b013e31824b29ef. PubMed PMID: 22584841.](http://www.ncbi.nlm.nih.gov/pubmed/22584841)[View Abstract at ](http://www.ncbi.nlm.nih.gov/pubmed/22584841)[PubMed](http://www.ncbi.nlm.nih.gov/pubmed/22584841)
9. [Cotten A, Flipo RM, Herbaux B, Gougeon F, Lecomte-Houcke M, Chastanet P. Synovial haemangioma of the knee: a frequently misdiagnosed lesion. Skeletal Radiol. 1995 May;24(4):257-61. PubMed PMID: 7644936.](http://www.ncbi.nlm.nih.gov/pubmed/7644936)[View Abstract at PubMed](http://www.ncbi.nlm.nih.gov/pubmed/7644936)
RECOMMENDED READINGS
8. [Dalmonte P, Granata C, Fulcheri E, Vercellino N, Gregorio S, Magnano G. Intra-articular venous malformations of the knee. J Pediatr Orthop. 2012 Jun;32(4):394-8. doi: 10.1097/BPO.0b013e31824b29ef. PubMed PMID: 22584841.](http://www.ncbi.nlm.nih.gov/pubmed/22584841)[View Abstract at ](http://www.ncbi.nlm.nih.gov/pubmed/22584841)[PubMed](http://www.ncbi.nlm.nih.gov/pubmed/22584841)
9. [Cotten A, Flipo RM, Herbaux B, Gougeon F, Lecomte-Houcke M, Chastanet P. Synovial haemangioma of the knee: a frequently misdiagnosed lesion. Skeletal Radiol. 1995 May;24(4):257-61. PubMed PMID: 7644936.](http://www.ncbi.nlm.nih.gov/pubmed/7644936)[View Abstract at PubMed](http://www.ncbi.nlm.nih.gov/pubmed/7644936)
QUESTION 39
of 100
A 21-year-old man learned he had Ewing sarcoma of the right distal femur at age 13. He underwent treatment with neoadjuvant chemotherapy, surgical resection with distal femoral replacement, and adjuvant chemotherapy. He completed treatment at age 14, and subsequent surveillance imaging has shown no evidence of recurrence. He has noted increasing fatigue during the last 3 months, however, and bleeding when he brushes his teeth. An examination is unremarkable with the exception of bilateral pretibial bruising for which the patient does not recall trauma. Which tests will aid in diagnosis?
A 21-year-old man learned he had Ewing sarcoma of the right distal femur at age 13. He underwent treatment with neoadjuvant chemotherapy, surgical resection with distal femoral replacement, and adjuvant chemotherapy. He completed treatment at age 14, and subsequent surveillance imaging has shown no evidence of recurrence. He has noted increasing fatigue during the last 3 months, however, and bleeding when he brushes his teeth. An examination is unremarkable with the exception of bilateral pretibial bruising for which the patient does not recall trauma. Which tests will aid in diagnosis?
1
Erythrocyte sedimentation rate (ESR) and C-reactive protein (CRP)
2
Serum protein electrophoresis
3
Complete blood count (CBC) with a peripheral smear
4
Platelet aggregation testing and bleeding time
This patient most likely has therapy-associated leukemia, which occurs in approximately 2% of patients who have Ewing sarcoma within 5 years of receiving treatment. Most cases are myelodysplasia or acute myeloid leukemia. Most patients with therapy-associated leukemia
respond poorly to conventional chemotherapies and require allogenic stem cell transplant for cure. Fatigue, gum bleeding, and bruising should raise concern for leukemia in light of his clinical history. A CBC with a peripheral smear will likely reveal an elevated leukocyte count with an abnormal percentage of myeloblasts. ESR and CRP are required to assess for infection of a prosthesis. Fatigue may be associated with chronic infection, but bleeding would be atypical. Platelet aggregation test results may be abnormal for this patient, but this testing is unlikely to reveal a specific diagnosis because drugs and genetic disorders may cause platelet aggregation dysfunction. Serum protein electrophoresis is diagnostic for multiple myeloma, but this patient is the wrong age for this condition and does not have appropriate signs and symptoms. A CBC can demonstrate early findings for leukemia with anemia and platelet suppression despite no blast presence. Of note, 25% of long-term survivors of Ewing sarcoma have findings of cardiotoxicity.
RECOMMENDED READINGS
10. [Bhatia S, Krailo MD, Chen Z, Burden L, Askin FB, Dickman PS, Grier HE, Link MP, Meyers PA, Perlman EJ, Rausen AR, Robison LL, Vietti TJ, Miser JS. Therapy-related myelodysplasia and acute myeloid leukemia after Ewing sarcoma and primitive neuroectodermal tumor of bone: A report from the Children's Oncology Group. Blood. 2007 Jan 1;109(1):46-51. Epub 2006 Sep 19. PubMed PMID: 16985182. ](http://www.ncbi.nlm.nih.gov/pubmed/16985182)[View Abstract at PubMed](http://www.ncbi.nlm.nih.gov/pubmed/16985182)
11. [Hamilton SN, Carlson R, Hasan H, Rassekh SR, Goddard K. Long-term Outcomes and Complications in Pediatric Ewing Sarcoma. Am J Clin Oncol. 2015 Jan 16. [Epub ahead of print] PubMed PMID: 25599318. ](http://www.ncbi.nlm.nih.gov/pubmed/25599318)[View Abstract at PubMed](http://www.ncbi.nlm.nih.gov/pubmed/25599318)
respond poorly to conventional chemotherapies and require allogenic stem cell transplant for cure. Fatigue, gum bleeding, and bruising should raise concern for leukemia in light of his clinical history. A CBC with a peripheral smear will likely reveal an elevated leukocyte count with an abnormal percentage of myeloblasts. ESR and CRP are required to assess for infection of a prosthesis. Fatigue may be associated with chronic infection, but bleeding would be atypical. Platelet aggregation test results may be abnormal for this patient, but this testing is unlikely to reveal a specific diagnosis because drugs and genetic disorders may cause platelet aggregation dysfunction. Serum protein electrophoresis is diagnostic for multiple myeloma, but this patient is the wrong age for this condition and does not have appropriate signs and symptoms. A CBC can demonstrate early findings for leukemia with anemia and platelet suppression despite no blast presence. Of note, 25% of long-term survivors of Ewing sarcoma have findings of cardiotoxicity.
RECOMMENDED READINGS
10. [Bhatia S, Krailo MD, Chen Z, Burden L, Askin FB, Dickman PS, Grier HE, Link MP, Meyers PA, Perlman EJ, Rausen AR, Robison LL, Vietti TJ, Miser JS. Therapy-related myelodysplasia and acute myeloid leukemia after Ewing sarcoma and primitive neuroectodermal tumor of bone: A report from the Children's Oncology Group. Blood. 2007 Jan 1;109(1):46-51. Epub 2006 Sep 19. PubMed PMID: 16985182. ](http://www.ncbi.nlm.nih.gov/pubmed/16985182)[View Abstract at PubMed](http://www.ncbi.nlm.nih.gov/pubmed/16985182)
11. [Hamilton SN, Carlson R, Hasan H, Rassekh SR, Goddard K. Long-term Outcomes and Complications in Pediatric Ewing Sarcoma. Am J Clin Oncol. 2015 Jan 16. [Epub ahead of print] PubMed PMID: 25599318. ](http://www.ncbi.nlm.nih.gov/pubmed/25599318)[View Abstract at PubMed](http://www.ncbi.nlm.nih.gov/pubmed/25599318)
QUESTION 40
of 100
Figures 41a through 41d are the radiograph, MR images, and biopsy specimen of a 35-year-old woman with pain and progressive paresthesias in her left arm. Staging shows no other lesions. Appropriate local control for this condition requires




Figures 41a through 41d are the radiograph, MR images, and biopsy specimen of a 35-year-old woman with pain and progressive paresthesias in her left arm. Staging shows no other lesions. Appropriate local control for this condition requires




1
forequarter amputation.
2
Tikhoff-Linberg limb salvage resection.
3
contaminated wide resection with a postsurgical radiotherapy boost.
4
chemotherapy and radiotherapy alone.
This patient has a pathologic fracture from a high-grade chondrosarcoma with encasement of the axillary contents. Meaningful wide resection necessitates amputation. Radiotherapy and chemotherapy do not have a defined role in the treatment of conventional chondrosarcoma. The resection of the axillary, musculocutaneous, or radial nerve or all 3 nerves is not an indication for a forequarter amputation. If the median or the ulnar nerve is expected to be resected, forequarter amputation should be seriously considered. An absolute indication of a forequarter amputation is encasement of the vascular bundle. Another strong indication is a pathologic fracture.
In 1 study that included both chondrosarcoma and dedifferentiated chondrosarcoma with pathologic fractures involving the proximal femur, the overall 5-year survival rates were 57% and 0%, respectively. In another study, local recurrence was a prelude to distant metastasis, and tumor grade and size and adequacy of the resection trended toward predictors of outcome.
RECOMMENDED READINGS
12. [Pant R, Yasko AW, Lewis VO, Raymond K, Lin PP. Chondrosarcoma of the scapula: long-term oncologic outcome. Cancer. 2005 Jul 1;104(1):149-58. ](http://www.ncbi.nlm.nih.gov/pubmed/15895373)[View Abstract at PubMed](http://www.ncbi.nlm.nih.gov/pubmed/15895373)
13. Bone sarcomas. In: Damron TA, ed. _Orthopaedic Surgery Essentials: Oncology and Basic Science_. Philadelphia, PA: Lippincott Williams and Wilkins; 2008:177-211.
14. [Chandrasekar CR, Grimer RJ, Carter SR, Tillman RM, Abudu AT, Jeys LM. Outcome of pathologic fractures of the proximal femur in nonosteogenic primary bone sarcoma. Eur J Surg Oncol. 2011 Jun;37(6):532-6. doi: 10.1016/j.ejso.2011.02.007. Epub 2011 Mar 4. ](http://www.ncbi.nlm.nih.gov/pubmed/21377313)[View Abstract at PubMed](http://www.ncbi.nlm.nih.gov/pubmed/21377313)
15. [Puri A, Shah M, Agarwal MG, Jambhekar NA, Basappa P. Chondrosarcoma of bone: does the size of the tumor, the presence of a pathologic fracture, or prior intervention have an impact on local control and survival? J Cancer Res Ther. 2009 Jan-Mar;5(1):14-9. ](http://www.ncbi.nlm.nih.gov/pubmed/19293483)[View Abstract at PubMed](http://www.ncbi.nlm.nih.gov/pubmed/19293483)
16. Malawer MM, Springfield D, Eckardt JJ, Peabody TJ. Shoulder girdle and proximal humerus. In: Simon MA, Springfield D, eds. _Surgery for Bone and Soft-Tissue Tumors_. Philadelphia, PA: Lippincott-Raven; 1998:299-321.
In 1 study that included both chondrosarcoma and dedifferentiated chondrosarcoma with pathologic fractures involving the proximal femur, the overall 5-year survival rates were 57% and 0%, respectively. In another study, local recurrence was a prelude to distant metastasis, and tumor grade and size and adequacy of the resection trended toward predictors of outcome.
RECOMMENDED READINGS
12. [Pant R, Yasko AW, Lewis VO, Raymond K, Lin PP. Chondrosarcoma of the scapula: long-term oncologic outcome. Cancer. 2005 Jul 1;104(1):149-58. ](http://www.ncbi.nlm.nih.gov/pubmed/15895373)[View Abstract at PubMed](http://www.ncbi.nlm.nih.gov/pubmed/15895373)
13. Bone sarcomas. In: Damron TA, ed. _Orthopaedic Surgery Essentials: Oncology and Basic Science_. Philadelphia, PA: Lippincott Williams and Wilkins; 2008:177-211.
14. [Chandrasekar CR, Grimer RJ, Carter SR, Tillman RM, Abudu AT, Jeys LM. Outcome of pathologic fractures of the proximal femur in nonosteogenic primary bone sarcoma. Eur J Surg Oncol. 2011 Jun;37(6):532-6. doi: 10.1016/j.ejso.2011.02.007. Epub 2011 Mar 4. ](http://www.ncbi.nlm.nih.gov/pubmed/21377313)[View Abstract at PubMed](http://www.ncbi.nlm.nih.gov/pubmed/21377313)
15. [Puri A, Shah M, Agarwal MG, Jambhekar NA, Basappa P. Chondrosarcoma of bone: does the size of the tumor, the presence of a pathologic fracture, or prior intervention have an impact on local control and survival? J Cancer Res Ther. 2009 Jan-Mar;5(1):14-9. ](http://www.ncbi.nlm.nih.gov/pubmed/19293483)[View Abstract at PubMed](http://www.ncbi.nlm.nih.gov/pubmed/19293483)
16. Malawer MM, Springfield D, Eckardt JJ, Peabody TJ. Shoulder girdle and proximal humerus. In: Simon MA, Springfield D, eds. _Surgery for Bone and Soft-Tissue Tumors_. Philadelphia, PA: Lippincott-Raven; 1998:299-321.
QUESTION 41
of 100
Figures 42a through 42d are the radiograph, CT scans, and biopsy specimen of a 38-year-old man who arrived at the emergency department with urinary retention. He has no other symptoms. What is the most appropriate treatment for this lesion?




Figures 42a through 42d are the radiograph, CT scans, and biopsy specimen of a 38-year-old man who arrived at the emergency department with urinary retention. He has no other symptoms. What is the most appropriate treatment for this lesion?




1
Surgery alone
2
Surgery and radiation therapy
3
Surgery, radiation therapy, and chemotherapy
4
Radiation therapy alone
These images reveal a chondrosarcoma. On radiograph, chondrosarcoma is a fusiform, lucent defect with scalloping of the inner cortex and periosteal reaction. Extension into the soft tissue may be present, as well as punctate or stippled calcification of the cartilage matrix. Histologically, chondrosarcoma is differentiated from benign cartilage tumors by enlarged plump nuclei, multiple cells per lacunae, binucleated cells, and hyperchromic nuclear pleomorphism. Treatment of most chondrosarcomas is surgery only because adjuvant treatments are not effective.
RECOMMENDED READINGS
17. [Weber KL, Pring ME, Sim FH. Treatment and outcome of recurrent pelvic chondrosarcoma. Clin Orthop Relat Res. 2002 Apr;(397):19-28. PubMed PMID: 11953591. ](http://www.ncbi.nlm.nih.gov/pubmed/11953591)[View Abstract at PubMed](http://www.ncbi.nlm.nih.gov/pubmed/11953591)
18. [Rajani R, Gibbs CP. Treatment of Bone Tumors. Surg Pathol Clin. 2012 Mar 1;5(1):301-318. PubMed PMID: 22328909. ](http://www.ncbi.nlm.nih.gov/pubmed/22328909)[View Abstract at PubMed](http://www.ncbi.nlm.nih.gov/pubmed/22328909)
RECOMMENDED READINGS
17. [Weber KL, Pring ME, Sim FH. Treatment and outcome of recurrent pelvic chondrosarcoma. Clin Orthop Relat Res. 2002 Apr;(397):19-28. PubMed PMID: 11953591. ](http://www.ncbi.nlm.nih.gov/pubmed/11953591)[View Abstract at PubMed](http://www.ncbi.nlm.nih.gov/pubmed/11953591)
18. [Rajani R, Gibbs CP. Treatment of Bone Tumors. Surg Pathol Clin. 2012 Mar 1;5(1):301-318. PubMed PMID: 22328909. ](http://www.ncbi.nlm.nih.gov/pubmed/22328909)[View Abstract at PubMed](http://www.ncbi.nlm.nih.gov/pubmed/22328909)
QUESTION 42
of 100
Which treatment regimen for Ewing sarcoma most effectively controls disease?
Which treatment regimen for Ewing sarcoma most effectively controls disease?
1
Chemotherapy alone
2
Chemotherapy plus wide surgical resection
3
Chemotherapy plus radiation therapy
4
Surgery plus radiation therapy
Patients with Ewing sarcoma need chemotherapy to treat micrometastatic disease. Historical outcomes of patients who receive local control alone without chemotherapy are dismal. Chemotherapy alone, however, is not adequate to control local bulky disease. Local control options include radiation therapy or wide surgical resection. Historically, it was believed that surgery should be recommended for expendable bones to minimize morbidity. More recent data support improved outcomes (vs outcomes associated with radiation alone to the primary site of disease) for patients who undergo wide surgical resection; consequently, chemotherapy plus wide surgical resection is the most effective regimen.
RECOMMENDED READINGS
19. [Rodriguez-Galindo C, Spunt SL, Pappo AS. Treatment of Ewing sarcoma family of tumors: current status and outlook for the future. Med Pediatr Oncol. 2003 May;40(5):276-87. Review. Erratum in: Med Pediatr Oncol. 2003 Dec;41(6):594. PubMed PMID: 12652615. ](http://www.ncbi.nlm.nih.gov/pubmed/12652615)[View Abstract at PubMed](http://www.ncbi.nlm.nih.gov/pubmed/12652615)
20. Bacci G, Toni A, Avella M, Manfrini M, Sudanese A, Ciaroni D, Boriani S, Emiliani E, Campanacci
[M. Long-term results in 144 localized Ewing's sarcoma patients treated with combined therapy. Cancer. 1989 Apr 15;63(8):1477-86. PubMed PMID: 2924256. ](http://www.ncbi.nlm.nih.gov/pubmed/2924256)[View Abstract at PubMed](http://www.ncbi.nlm.nih.gov/pubmed/2924256)
21. [Maheshwari AV, Cheng EY. Ewing sarcoma family of tumors. J Am Acad Orthop Surg. 2010 Feb;18(2):94-107. Review. PubMed PMID: 20118326. ](http://www.ncbi.nlm.nih.gov/pubmed/20118326)[View Abstract at PubMed](http://www.ncbi.nlm.nih.gov/pubmed/20118326)
22. Weis L. Ewing’s Sarcoma. In: Simon MA, Springfield D, eds. _Surgery for Bone and Soft Tissue Tumors_. Philadelphia, PA: Lippincott-Raven; 1998:287-298.
23. DuBois SG, Krailo MD, Gebhardt MC, Donaldson SS, Marcus KJ, Dormans J, Shamberger RC, Sailer S, Nicholas RW, Healey JH, Tarbell NJ, Randall RL, Devidas M, Meyer JS, Granowetter L, Womer RB, Bernstein M, Marina N, Grier HE. Comparative evaluation of local control strategies in localized
Ewing sarcoma of bone: a report from the Children's Oncology Group. Cancer. 2015 Feb 1;121(3):467-
[75/. doi: 10.1002/cncr.29065. Epub 2014 Sep 23. PubMed PMID: 25251206. ](http://www.ncbi.nlm.nih.gov/pubmed/25251206)[View Abstract at PubMed](http://www.ncbi.nlm.nih.gov/pubmed/25251206)
RECOMMENDED READINGS
19. [Rodriguez-Galindo C, Spunt SL, Pappo AS. Treatment of Ewing sarcoma family of tumors: current status and outlook for the future. Med Pediatr Oncol. 2003 May;40(5):276-87. Review. Erratum in: Med Pediatr Oncol. 2003 Dec;41(6):594. PubMed PMID: 12652615. ](http://www.ncbi.nlm.nih.gov/pubmed/12652615)[View Abstract at PubMed](http://www.ncbi.nlm.nih.gov/pubmed/12652615)
20. Bacci G, Toni A, Avella M, Manfrini M, Sudanese A, Ciaroni D, Boriani S, Emiliani E, Campanacci
[M. Long-term results in 144 localized Ewing's sarcoma patients treated with combined therapy. Cancer. 1989 Apr 15;63(8):1477-86. PubMed PMID: 2924256. ](http://www.ncbi.nlm.nih.gov/pubmed/2924256)[View Abstract at PubMed](http://www.ncbi.nlm.nih.gov/pubmed/2924256)
21. [Maheshwari AV, Cheng EY. Ewing sarcoma family of tumors. J Am Acad Orthop Surg. 2010 Feb;18(2):94-107. Review. PubMed PMID: 20118326. ](http://www.ncbi.nlm.nih.gov/pubmed/20118326)[View Abstract at PubMed](http://www.ncbi.nlm.nih.gov/pubmed/20118326)
22. Weis L. Ewing’s Sarcoma. In: Simon MA, Springfield D, eds. _Surgery for Bone and Soft Tissue Tumors_. Philadelphia, PA: Lippincott-Raven; 1998:287-298.
23. DuBois SG, Krailo MD, Gebhardt MC, Donaldson SS, Marcus KJ, Dormans J, Shamberger RC, Sailer S, Nicholas RW, Healey JH, Tarbell NJ, Randall RL, Devidas M, Meyer JS, Granowetter L, Womer RB, Bernstein M, Marina N, Grier HE. Comparative evaluation of local control strategies in localized
Ewing sarcoma of bone: a report from the Children's Oncology Group. Cancer. 2015 Feb 1;121(3):467-
[75/. doi: 10.1002/cncr.29065. Epub 2014 Sep 23. PubMed PMID: 25251206. ](http://www.ncbi.nlm.nih.gov/pubmed/25251206)[View Abstract at PubMed](http://www.ncbi.nlm.nih.gov/pubmed/25251206)
QUESTION 43
of 100
Figures 44a through 44c are the clinical photograph and radiographs of a 59-year-old man who has a 4-year history of metastatic renal cell carcinoma to the brain, lungs, and bones. He has been referred for a painful left proximal femur metastasis. Axial MR images are shown in Figures 44d and 44e. Presurgical embolization, en bloc resection, and proximal femur replacement are performed. The resection specimen and a postsurgical radiograph are shown in Figures 44f and 44g. Compared with intramedullary nail fixation, this treatment strategy







Figures 44a through 44c are the clinical photograph and radiographs of a 59-year-old man who has a 4-year history of metastatic renal cell carcinoma to the brain, lungs, and bones. He has been referred for a painful left proximal femur metastasis. Axial MR images are shown in Figures 44d and 44e. Presurgical embolization, en bloc resection, and proximal femur replacement are performed. The resection specimen and a postsurgical radiograph are shown in Figures 44f and 44g. Compared with intramedullary nail fixation, this treatment strategy







1
entails a higher perioperative mortality risk.
2
improves overall survival.
3
poses lower risk for local treatment failure.
4
is associated with less complete pain relief.
Both a retrospective study and retrospective review of the prospectively collected Scandinavian Sarcoma Group database have shown lower rates of revision surgery and local control failure with en bloc resection than with intralesional procedures. Multiple retrospective studies of solitary renal cell metastases have demonstrated an overall survival benefit with en bloc resection; however, these data are not applicable because this patient has multisystem disease. A perioperative mortality difference between resection and nailing procedures has not been demonstrated. Although surgical intervention to treat pathologic fractures improves pain, studies comparing the adequacy of different interventions are limited. In this patient, a nail procedure would necessitate less surgical dissection and shorter surgical time. However, a nail would not address the large soft-tissue mass that likely was a major contributor to this patient’s pain.
RECOMMENDED READINGS
24. [Ratasvuori M, Wedin R, Hansen BH, Keller J, Trovik C, Zaikova O, Bergh P, Kalen A, Laitinen M. Prognostic role of en-bloc resection and late onset of bone metastasis in patients with bone-seeking carcinomas of the kidney, breast, lung, and prostate: SSG study on 672 operated skeletal metastases. J Surg Oncol. 2014 Sep;110(4):360-5. doi: 10.1002/jso.23654. Epub 2014 May 29. PubMed PMID: 24889389. ](http://www.ncbi.nlm.nih.gov/pubmed/24889389)[View Abstract at PubMed](http://www.ncbi.nlm.nih.gov/pubmed/24889389)
25. [Steensma M, Boland PJ, Morris CD, Athanasian E, Healey JH. Endoprosthetic treatment is more durable for pathologic proximal femur fractures. Clin Orthop Relat Res. 2012 Mar;470(3):920-6. doi: 10.1007/s11999-011-2047-z. Epub 2011 Aug 31. PubMed PMID: 21879407. ](http://www.ncbi.nlm.nih.gov/pubmed/21879407)[View Abstract at ](http://www.ncbi.nlm.nih.gov/pubmed/21879407)[PubMed](http://www.ncbi.nlm.nih.gov/pubmed/21879407)
26. Hwang N, Nandra R, Grimer RJ, Carter SR, Tillman RM, Abudu A, Jeys LM. Massive endoprosthetic replacement for bone metastases resulting from renal cell carcinoma: factors influencing patient survival. Eur J Surg Oncol. 2014 Apr;40(4):429-34. doi: 10.1016/j.ejso.2013.08.001. Epub 2013 Sep
[21/. PubMed PMID: 24063967. ](http://www.ncbi.nlm.nih.gov/pubmed/24063967)[View Abstract at PubMed](http://www.ncbi.nlm.nih.gov/pubmed/24063967)
RECOMMENDED READINGS
24. [Ratasvuori M, Wedin R, Hansen BH, Keller J, Trovik C, Zaikova O, Bergh P, Kalen A, Laitinen M. Prognostic role of en-bloc resection and late onset of bone metastasis in patients with bone-seeking carcinomas of the kidney, breast, lung, and prostate: SSG study on 672 operated skeletal metastases. J Surg Oncol. 2014 Sep;110(4):360-5. doi: 10.1002/jso.23654. Epub 2014 May 29. PubMed PMID: 24889389. ](http://www.ncbi.nlm.nih.gov/pubmed/24889389)[View Abstract at PubMed](http://www.ncbi.nlm.nih.gov/pubmed/24889389)
25. [Steensma M, Boland PJ, Morris CD, Athanasian E, Healey JH. Endoprosthetic treatment is more durable for pathologic proximal femur fractures. Clin Orthop Relat Res. 2012 Mar;470(3):920-6. doi: 10.1007/s11999-011-2047-z. Epub 2011 Aug 31. PubMed PMID: 21879407. ](http://www.ncbi.nlm.nih.gov/pubmed/21879407)[View Abstract at ](http://www.ncbi.nlm.nih.gov/pubmed/21879407)[PubMed](http://www.ncbi.nlm.nih.gov/pubmed/21879407)
26. Hwang N, Nandra R, Grimer RJ, Carter SR, Tillman RM, Abudu A, Jeys LM. Massive endoprosthetic replacement for bone metastases resulting from renal cell carcinoma: factors influencing patient survival. Eur J Surg Oncol. 2014 Apr;40(4):429-34. doi: 10.1016/j.ejso.2013.08.001. Epub 2013 Sep
[21/. PubMed PMID: 24063967. ](http://www.ncbi.nlm.nih.gov/pubmed/24063967)[View Abstract at PubMed](http://www.ncbi.nlm.nih.gov/pubmed/24063967)
QUESTION 44
of 100
Figures 45a and 45b are the radiographs of a previously asymptomatic 10-year-old girl who fell off of her bike. Treatment of this lesion should consist of


Figures 45a and 45b are the radiographs of a previously asymptomatic 10-year-old girl who fell off of her bike. Treatment of this lesion should consist of


1
observation.
2
MRI with and without contrast.
3
curettage and bone grafting.
4
open biopsy.


Nonossifying fibroma of bone is a common entity and consists of a solitary eccentric, lytic expanded lesion in the metaphysis of a long bone. Clinically, nonossifying fibromas are asymptomatic and are usually an incidental finding on radiograph. These lesions normally regress spontaneously.
RECOMMENDED READINGS
27. [Mankin HJ, Trahan CA, Fondren G, Mankin CJ. Non-ossifying fibroma, fibrous cortical defect and Jaffe-Campanacci syndrome: a biologic and clinical review. Chir Organi Mov. 2009 May;93(1):1-7. doi: 10.1007/s12306-009-0016-4. Epub 2009 Apr 29. Review. PubMed PMID: 19711155. ](http://www.ncbi.nlm.nih.gov/pubmed/19711155)[View](http://www.ncbi.nlm.nih.gov/pubmed/19711155)
[Abstract at PubMed](http://www.ncbi.nlm.nih.gov/pubmed/19711155)
28. [Smith SE, Kransdorf MJ. Primary musculoskeletal tumors of fibrous origin. Semin Musculoskelet Radiol. 2000;4(1):73-88. Review. PubMed PMID: 11061693. ](http://www.ncbi.nlm.nih.gov/pubmed/11061693)[View Abstract at PubMed](http://www.ncbi.nlm.nih.gov/pubmed/11061693)
RECOMMENDED READINGS
27. [Mankin HJ, Trahan CA, Fondren G, Mankin CJ. Non-ossifying fibroma, fibrous cortical defect and Jaffe-Campanacci syndrome: a biologic and clinical review. Chir Organi Mov. 2009 May;93(1):1-7. doi: 10.1007/s12306-009-0016-4. Epub 2009 Apr 29. Review. PubMed PMID: 19711155. ](http://www.ncbi.nlm.nih.gov/pubmed/19711155)[View](http://www.ncbi.nlm.nih.gov/pubmed/19711155)
[Abstract at PubMed](http://www.ncbi.nlm.nih.gov/pubmed/19711155)
28. [Smith SE, Kransdorf MJ. Primary musculoskeletal tumors of fibrous origin. Semin Musculoskelet Radiol. 2000;4(1):73-88. Review. PubMed PMID: 11061693. ](http://www.ncbi.nlm.nih.gov/pubmed/11061693)[View Abstract at PubMed](http://www.ncbi.nlm.nih.gov/pubmed/11061693)
QUESTION 45
of 100
Figure 46a is the lateral radiograph of a 54-year-old man who has had a painless soft-tissue mass on his right foot that has been growing slowly for about 1 year. MR sequences are shown in Figures 46b through 46e. A biopsy is performed, and a low-power hematoxylin and eosin photomicrograph is seen in Figure 46f. The most appropriate treatment for this lesion is







Figure 46a is the lateral radiograph of a 54-year-old man who has had a painless soft-tissue mass on his right foot that has been growing slowly for about 1 year. MR sequences are shown in Figures 46b through 46e. A biopsy is performed, and a low-power hematoxylin and eosin photomicrograph is seen in Figure 46f. The most appropriate treatment for this lesion is







1
a diet that reduces uric acid production.
2
wide local resection followed by radiotherapy.
3
marginal excision.
4
excision and radiotherapy after the mineralization matures.







This is a giant-cell tumor of the tendon sheath. A solid lesion larger than 1.5 cm in the hand or foot warrants biopsy to rule out malignancy. The 3 most common benign tumors of the foot are ganglion cysts, giant-cell tumors of tendon sheath, and hemangiomas. Radiographs are nonspecific but may reveal extrinsic erosions of bone by a giant-cell tumor of the tendon sheath. MR findings of prominent low-signal intensity (seen with T2 weighting) and “blooming” artifact from the hemosiderin (seen with gradient-echo sequences) are nearly pathognomonic of this diagnosis, as
seen here. Pathology shows hemosiderin-laden macrophages and giant cells as seen in the histology. Uric acid reduction would be indicated for gout and wide local excision for a soft-tissue sarcoma. Observation awaiting mature mineralization would apply to heterotopic ossification.
RECOMMENDED READINGS
29. Murphey MD, Rhee JH, Lewis RB, Fanburg-Smith JC, Flemming DJ, Walker EA. Pigmented villonodular synovitis: radiologic-pathologic correlation. Radiographics. 2008 Sep-Oct;28(5):1493-
[518/. doi: 10.1148/rg.285085134. PubMed PMID: 18794322. ](http://www.ncbi.nlm.nih.gov/pubmed/18794322)[View Abstract at PubMed](http://www.ncbi.nlm.nih.gov/pubmed/18794322)
30. [Ruggieri P, Angelini A, Jorge FD, Maraldi M, Giannini S. Review of foot tumors seen in a university tumor institute. J Foot Ankle Surg. 2014 May-Jun;53(3):282-5. doi: 10.1053/j.jfas.2014.01.015. Review. PubMed PMID: 24751209. ](http://www.ncbi.nlm.nih.gov/pubmed/24751209)[View Abstract at PubMed](http://www.ncbi.nlm.nih.gov/pubmed/24751209)
seen here. Pathology shows hemosiderin-laden macrophages and giant cells as seen in the histology. Uric acid reduction would be indicated for gout and wide local excision for a soft-tissue sarcoma. Observation awaiting mature mineralization would apply to heterotopic ossification.
RECOMMENDED READINGS
29. Murphey MD, Rhee JH, Lewis RB, Fanburg-Smith JC, Flemming DJ, Walker EA. Pigmented villonodular synovitis: radiologic-pathologic correlation. Radiographics. 2008 Sep-Oct;28(5):1493-
[518/. doi: 10.1148/rg.285085134. PubMed PMID: 18794322. ](http://www.ncbi.nlm.nih.gov/pubmed/18794322)[View Abstract at PubMed](http://www.ncbi.nlm.nih.gov/pubmed/18794322)
30. [Ruggieri P, Angelini A, Jorge FD, Maraldi M, Giannini S. Review of foot tumors seen in a university tumor institute. J Foot Ankle Surg. 2014 May-Jun;53(3):282-5. doi: 10.1053/j.jfas.2014.01.015. Review. PubMed PMID: 24751209. ](http://www.ncbi.nlm.nih.gov/pubmed/24751209)[View Abstract at PubMed](http://www.ncbi.nlm.nih.gov/pubmed/24751209)
QUESTION 46
of 100
Figures 47a and 47b are the radiograph and axial CT section of a 73-year-old woman with metastatic lung cancer who has a painful left periacetabular lesion. She is a high-risk surgical candidate because of a prior pneumonectomy and progressive metastatic disease of her remaining lung. Palliative radiation is recommended. Two regimens are being considered: a single fraction of 8 Gy or 15 fractions of a 30-Gy cumulative dose over 3 weeks. Compared to the multifraction regimen, the 8-Gy single fraction is associated with


Figures 47a and 47b are the radiograph and axial CT section of a 73-year-old woman with metastatic lung cancer who has a painful left periacetabular lesion. She is a high-risk surgical candidate because of a prior pneumonectomy and progressive metastatic disease of her remaining lung. Palliative radiation is recommended. Two regimens are being considered: a single fraction of 8 Gy or 15 fractions of a 30-Gy cumulative dose over 3 weeks. Compared to the multifraction regimen, the 8-Gy single fraction is associated with


1
inferior pain relief.
2
higher cost.
3
superior pain relief.
4
equivalent pain relief.
Multiple prospective randomized controlled trials have evaluated single vs multifraction radiation regimens for the treatment of painful bone metastases. All studies have demonstrated equivalent pain relief. Retreatment rates are higher with single-fraction dosing, but it is unknown if this is
because of higher rates of recurrent pain with single fractions or reluctance of radiation oncologists to give additional radiation when multifraction regimens with higher cumulative doses have failed. Single-fraction radiation is less expensive and more convenient for patients. The American Board of Internal Medicine Foundation’s Choosing Wisely® campaign to encourage physician leadership in reducing harmful or inappropriate resource use selected “Don’t recommend more than a single fraction of palliative radiation for an uncomplicated painful bone metastasis” as 1 of the “5 things physicians and patients should question in hospice and palliative medicine.”
RECOMMENDED READINGS
31. [Fischberg D, Bull J, Casarett D, Hanson LC, Klein SM, Rotella J, Smith T, Storey CP Jr, Teno JM, Widera E; HPM Choosing Wisely Task Force. Five things physicians and patients should question in hospice and palliative medicine. J Pain Symptom Manage. 2013 Mar;45(3):595-605. doi: 10.1016/j.jpainsymman.2012.12.002. Epub 2013 Feb 22. ](http://www.ncbi.nlm.nih.gov/pubmed/23434175)[View Abstract at PubMed](http://www.ncbi.nlm.nih.gov/pubmed/23434175)
32. [Dennis K, Makhani L, Zeng L, Lam H, Chow E. Single fraction conventional external beam radiation therapy for bone metastases: a systematic review of randomised controlled trials. Radiother Oncol. 2013 Jan;106(1):5-14. doi: 10.1016/j.radonc.2012.12.009. Epub 2013 Jan 13. Review. PubMed PMID: 23321492. ](http://www.ncbi.nlm.nih.gov/pubmed/23321492)[View Abstract at PubMed](http://www.ncbi.nlm.nih.gov/pubmed/23321492)
33. [Hartsell WF, Konski AA, Lo SS, Hayman JA. Single fraction radiotherapy for bone metastases: clinically effective, time efficient, cost conscious and still underutilized in the United States? Clin Oncol (R Coll Radiol). 2009 Nov;21(9):652-4. doi: 10.1016/j.clon.2009.08.003. Epub 2009 Sep 9. PubMed PMID: 19744843. ](http://www.ncbi.nlm.nih.gov/pubmed/19744843)[View Abstract at PubMed](http://www.ncbi.nlm.nih.gov/pubmed/19744843)
because of higher rates of recurrent pain with single fractions or reluctance of radiation oncologists to give additional radiation when multifraction regimens with higher cumulative doses have failed. Single-fraction radiation is less expensive and more convenient for patients. The American Board of Internal Medicine Foundation’s Choosing Wisely® campaign to encourage physician leadership in reducing harmful or inappropriate resource use selected “Don’t recommend more than a single fraction of palliative radiation for an uncomplicated painful bone metastasis” as 1 of the “5 things physicians and patients should question in hospice and palliative medicine.”
RECOMMENDED READINGS
31. [Fischberg D, Bull J, Casarett D, Hanson LC, Klein SM, Rotella J, Smith T, Storey CP Jr, Teno JM, Widera E; HPM Choosing Wisely Task Force. Five things physicians and patients should question in hospice and palliative medicine. J Pain Symptom Manage. 2013 Mar;45(3):595-605. doi: 10.1016/j.jpainsymman.2012.12.002. Epub 2013 Feb 22. ](http://www.ncbi.nlm.nih.gov/pubmed/23434175)[View Abstract at PubMed](http://www.ncbi.nlm.nih.gov/pubmed/23434175)
32. [Dennis K, Makhani L, Zeng L, Lam H, Chow E. Single fraction conventional external beam radiation therapy for bone metastases: a systematic review of randomised controlled trials. Radiother Oncol. 2013 Jan;106(1):5-14. doi: 10.1016/j.radonc.2012.12.009. Epub 2013 Jan 13. Review. PubMed PMID: 23321492. ](http://www.ncbi.nlm.nih.gov/pubmed/23321492)[View Abstract at PubMed](http://www.ncbi.nlm.nih.gov/pubmed/23321492)
33. [Hartsell WF, Konski AA, Lo SS, Hayman JA. Single fraction radiotherapy for bone metastases: clinically effective, time efficient, cost conscious and still underutilized in the United States? Clin Oncol (R Coll Radiol). 2009 Nov;21(9):652-4. doi: 10.1016/j.clon.2009.08.003. Epub 2009 Sep 9. PubMed PMID: 19744843. ](http://www.ncbi.nlm.nih.gov/pubmed/19744843)[View Abstract at PubMed](http://www.ncbi.nlm.nih.gov/pubmed/19744843)
QUESTION 47
of 100
Figures 48a through 48e are the MR image, radiograph, CT scan, and biopsy specimens of a 14-year-old boy with right shoulder pain without antecedent trauma. What is the most likely diagnosis?






Figures 48a through 48e are the MR image, radiograph, CT scan, and biopsy specimens of a 14-year-old boy with right shoulder pain without antecedent trauma. What is the most likely diagnosis?






1
Unicameral bone cyst
2
Eosinophilic granuloma
3
Chondrosarcoma
4
Chondroblastoma
Imaging reveals a destructive mineralized lesion of the epiphysis and metaphysis in a skeletally immature patient. Epiphyseal lesions include chondroblastoma in skeletally immature patients and giant-cell tumors in skeletally mature patients. The histology confirms the diagnosis with the presence of multinucleated giant cells, “chicken-wire” calcifications, and chondroid islands. Chondrosarcoma would look histologically more aggressive than this and is unusual in children. Unicameral bone cysts do not have mineralization and are typically confined to the metaphysis radiologically. Eosinophilic granuloma can mimic many different lesions radiographically and can occasionally be found in the epiphysis of children, but the histology does not demonstrate classic Langerhans cells.
RECOMMENDED READINGS
34. Wold LE, Unni KK, Sim FH, Sundaram M, Adler C-P, eds. _Atlas of Orthopedic Pathology_. 2nd edition. Philadelphia PA: Saunders; 2003:232:237.
35. [De Mattos CB, Angsanuntsukh C, Arkader A, Dormans JP. Chondroblastoma and chondromyxoid fibroma. J Am Acad Orthop Surg. 2013 Apr;21(4):225-33. doi: 10.5435/JAAOS-21-04-225. Review. PubMed PMID: 23545728.](http://www.ncbi.nlm.nih.gov/pubmed/23545728)[View Abstract at PubMed](http://www.ncbi.nlm.nih.gov/pubmed/23545728)
CLINICAL SITUATION FOR QUESTIONS 49 AND 50
Figure 49 is the radiograph of a 22-year-old woman with pain and snapping about the knee. Her husband does not have this condition.
RECOMMENDED READINGS
34. Wold LE, Unni KK, Sim FH, Sundaram M, Adler C-P, eds. _Atlas of Orthopedic Pathology_. 2nd edition. Philadelphia PA: Saunders; 2003:232:237.
35. [De Mattos CB, Angsanuntsukh C, Arkader A, Dormans JP. Chondroblastoma and chondromyxoid fibroma. J Am Acad Orthop Surg. 2013 Apr;21(4):225-33. doi: 10.5435/JAAOS-21-04-225. Review. PubMed PMID: 23545728.](http://www.ncbi.nlm.nih.gov/pubmed/23545728)[View Abstract at PubMed](http://www.ncbi.nlm.nih.gov/pubmed/23545728)
CLINICAL SITUATION FOR QUESTIONS 49 AND 50
Figure 49 is the radiograph of a 22-year-old woman with pain and snapping about the knee. Her husband does not have this condition.
QUESTION 48
of 100
What is the likelihood of this patient’s children having a similar condition?
What is the likelihood of this patient’s children having a similar condition?
1
No different than the likelihood among the general population
2
25% only if her partner is similarly affected; if not, no different than the population average
3
50%
4
100%
- 50%_
QUESTION 49
of 100
Germline alterations associated with this condition


Germline alterations associated with this condition


1
affect proteins exostosin-1 (EXT1) and exostosin-2 (EXT2).
2
encode the alpha subunit of the stimulatory G-protein-coupled receptor, Gsa.
3
cause neoplastic cells to express vimentin, CD99, and FLI-1.
4
produce the WWTR1-CAMTA1 fusion.
The radiograph reveals multiple osteochondromas consistent with multiple hereditary exostoses (also termed osteochondromatosis). This is inherited in an autosomal-dominant fashion through the EXT1 and EXT2 genes. Thus, the likelihood of this patient’s children being affected is 50% for each child. An autosomal dominant manner with germiline alterations in EXT1 located at 8q24 and EXT2 located at 11p11-p12 occurs in approximately 1 in 50,000 people.
Multiple hereditary exostoses is a disease in a spectrum of diseases caused by alterations in either EXT1 or EXT2. The gene products of EXT1 and EXT2 genes are considered essential for the function of fibroblast growth factor and Indian hedgehog signaling in the normal growth plate and catalyze heparin sulphate polymerization. The G-protein-couple receptor is involved in fibrous dysplasia, the expression of vimentin, and CD99. FLI-1 is associated with Ewing sarcoma, and WWTR1-CAMTA1 fusion is associated with epithelioid hemangioma, which is not related to multiple hereditary exostoses.
RECOMMENDED READINGS
36. Multiple hereditary osteochondromatosis. In: Nielsen GP, Rosenberg AE, eds. _Diagnostic Pathology: Bone_. Manitoba, Canada: Amirsys; 2013:12-15.
37. [Busse-Wicher M, Wicher KB, Kusche-Gullberg M. The exostosin family: proteins with many functions. Matrix Biol. 2014 Apr;35:25-33. doi: 10.1016/j.matbio.2013.10.001. Epub 2013 Oct 12. Review. PubMed PMID: 24128412.](http://www.ncbi.nlm.nih.gov/pubmed/24128412)[View Abstract at PubMed](http://www.ncbi.nlm.nih.gov/pubmed/24128412)
CLINICAL SITUATION FOR QUESTIONS 51 THROUGH 54
Figures 51a and 51b are the radiographs of an 83-year-old active, independent, and healthy woman who has experienced 2 months of right lower thigh and knee pain. Her arthroplasty was previously well functioning, but her pain has increased progressively for several weeks. While exiting a car she “bumped” her knee against the door, felt a “crack,” and developed excruciating pain. She can no longer ambulate and was brought to the hospital
Multiple hereditary exostoses is a disease in a spectrum of diseases caused by alterations in either EXT1 or EXT2. The gene products of EXT1 and EXT2 genes are considered essential for the function of fibroblast growth factor and Indian hedgehog signaling in the normal growth plate and catalyze heparin sulphate polymerization. The G-protein-couple receptor is involved in fibrous dysplasia, the expression of vimentin, and CD99. FLI-1 is associated with Ewing sarcoma, and WWTR1-CAMTA1 fusion is associated with epithelioid hemangioma, which is not related to multiple hereditary exostoses.
RECOMMENDED READINGS
36. Multiple hereditary osteochondromatosis. In: Nielsen GP, Rosenberg AE, eds. _Diagnostic Pathology: Bone_. Manitoba, Canada: Amirsys; 2013:12-15.
37. [Busse-Wicher M, Wicher KB, Kusche-Gullberg M. The exostosin family: proteins with many functions. Matrix Biol. 2014 Apr;35:25-33. doi: 10.1016/j.matbio.2013.10.001. Epub 2013 Oct 12. Review. PubMed PMID: 24128412.](http://www.ncbi.nlm.nih.gov/pubmed/24128412)[View Abstract at PubMed](http://www.ncbi.nlm.nih.gov/pubmed/24128412)
CLINICAL SITUATION FOR QUESTIONS 51 THROUGH 54
Figures 51a and 51b are the radiographs of an 83-year-old active, independent, and healthy woman who has experienced 2 months of right lower thigh and knee pain. Her arthroplasty was previously well functioning, but her pain has increased progressively for several weeks. While exiting a car she “bumped” her knee against the door, felt a “crack,” and developed excruciating pain. She can no longer ambulate and was brought to the hospital
QUESTION 50
of 100
Based on imaging alone, what does this bone lesion most closely resemble?
Based on imaging alone, what does this bone lesion most closely resemble?
1
Multiple myeloma
2
Implant-associated osteolysis
3
Metastatic renal cell carcinoma
4
Enchondroma
- Enchondroma_
QUESTION 51
of 100
Figures 52a through 52c show the biopsy of this lesion. Based on the clinical history, radiograph, and biopsy, which diagnosis is most likely?



Figures 52a through 52c show the biopsy of this lesion. Based on the clinical history, radiograph, and biopsy, which diagnosis is most likely?



1
Enchondroma
2
High-grade osteosarcoma
3
Metastatic renal cell carcinoma
4
Dedifferentiated chondrosarcoma

- Dedifferentiated chondrosarcoma_
QUESTION 52
of 100
Staging for patients with this diagnosis necessitates which study or studies?
Staging for patients with this diagnosis necessitates which study or studies?
1
CT scan of the chest and a bone scan
2
Skeletal survey
3
Bone marrow aspirate
4
Bone marrow biopsy
- CT scan of the chest and a bone scan_
QUESTION 53
of 100
Which local treatment option is most appropriate?
Which local treatment option is most appropriate?
1
Radiation and wide surgical resection
2
Extended curettage with adjuvants
3
Wide surgical resection
4
Revision knee arthroplasty
This patient has a pathologic femur fracture. Her history of antecedent pain in the context of a previously well-functioning implant suggests that a new process such as dedifferentiation of a long-standing lesion may have occurred. The initial radiograph reveals a well-mineralized lesion within the intramedullary canal with punctate calcifications. This by itself suggests an enchondroma or low-grade chondrosarcoma. It is important to note that enchondromas in the long bones rarely cause pathologic fractures. This is not the case when they are present in the hands and feet, where enchondromas frequently have a more aggressive radiologic appearance and pose higher risk. Radiographic findings concerning for malignant dedifferentiation of an enchondroma
include cortical thinning or breach, a soft-tissue mass, or periosteal elevation. The pathologic fracture obscures the ability to identify these hallmarks of malignant degeneration.
Multiple myeloma, renal cell carcinoma, and osteolysis are all typically radiolucent. Implant-associated osteolysis lesions are commonly multiple and periarticular. The histopathology reveals a cartilage tumor. The chondroid tissue appears to be low grade. However, in an adjacent region there is a high-grade component seen both on the low-power view and the second higher-power sample that does not resemble cartilage. This is highly suggestive of a dedifferentiated chondrosarcoma. This component signifies that a portion of the original tumor (low-grade chondrosarcoma), which resembled the tissue of origin, converted into a different cell lineage with more aggressive properties (nearly any type of high-grade sarcoma). Dedifferentiated chondrosarcoma is a highly aggressive malignancy, with average 5-year survivals of less than 50%. As with most sarcomas, the most likely site of metastatic dissemination of chondrosarcoma is pulmonary. Consequently, standard staging entails a high-resolution CT scan of the lungs.
Serum protein electrophoresis and a skeletal survey are used for diagnosis of multiple myeloma. Positron emission tomography/CT fusion scans are used at many centers in the staging of osteosarcoma, but their role in chondrosarcoma staging is an emerging modality that is being investigated. Radiation is not typically used for local treatment of extremity chondrosarcoma. Extended curettage is not appropriate for a high-grade lesion such as this. Revision arthroplasty alone does not address the tumor. Wide resection is the local treatment of choice for high-grade chondrosarcoma; because of the fracture, this patient may require an amputation to achieve wide margins.
RECOMMENDED READINGS
1. [Henderson ER, Pala E, Angelini A, Rimondi E, Ruggieri P. Dedifferentiated peripheral chondrosarcoma: a review of radiologic characteristics. Sarcoma. 2013;2013:505321. doi: 10.1155/2013/505321. Epub 2013 Mar 25. PubMed PMID: 23589702. ](http://www.ncbi.nlm.nih.gov/pubmed/23589702)[View Abstract at PubMed](http://www.ncbi.nlm.nih.gov/pubmed/23589702)
2. [Grimer RJ, Gosheger G, Taminiau A, Biau D, Matejovsky Z, Kollender Y, San-Julian M, Gherlinzoni F, Ferrari C. Dedifferentiated chondrosarcoma: prognostic factors and outcome from a European group. Eur J Cancer. 2007 Sep;43(14):2060-5. Epub 2007 Aug 27. ](http://www.ncbi.nlm.nih.gov/pubmed/17720491)[View Abstract at PubMed](http://www.ncbi.nlm.nih.gov/pubmed/17720491)
3. [Mavrogenis AF, Gambarotti M, Angelini A, Palmerini E, Staals EL, Ruggieri P, Papagelopoulos PJ. Chondrosarcomas revisited. Orthopedics. 2012 Mar 7;35(3):e379-90. doi: 10.3928/01477447-20120222-30. PubMed PMID: 22385450. ](http://www.ncbi.nlm.nih.gov/pubmed/22385450)[View Abstract at PubMed](http://www.ncbi.nlm.nih.gov/pubmed/22385450)
4. [Flemming DJ, Murphey MD. Enchondroma and chondrosarcoma. Semin Musculoskelet Radiol. 2000;4(1):59-71. Review. PubMed PMID: 11061692. ](http://www.ncbi.nlm.nih.gov/pubmed/11061692)[View Abstract at PubMed](http://www.ncbi.nlm.nih.gov/pubmed/11061692)
include cortical thinning or breach, a soft-tissue mass, or periosteal elevation. The pathologic fracture obscures the ability to identify these hallmarks of malignant degeneration.
Multiple myeloma, renal cell carcinoma, and osteolysis are all typically radiolucent. Implant-associated osteolysis lesions are commonly multiple and periarticular. The histopathology reveals a cartilage tumor. The chondroid tissue appears to be low grade. However, in an adjacent region there is a high-grade component seen both on the low-power view and the second higher-power sample that does not resemble cartilage. This is highly suggestive of a dedifferentiated chondrosarcoma. This component signifies that a portion of the original tumor (low-grade chondrosarcoma), which resembled the tissue of origin, converted into a different cell lineage with more aggressive properties (nearly any type of high-grade sarcoma). Dedifferentiated chondrosarcoma is a highly aggressive malignancy, with average 5-year survivals of less than 50%. As with most sarcomas, the most likely site of metastatic dissemination of chondrosarcoma is pulmonary. Consequently, standard staging entails a high-resolution CT scan of the lungs.
Serum protein electrophoresis and a skeletal survey are used for diagnosis of multiple myeloma. Positron emission tomography/CT fusion scans are used at many centers in the staging of osteosarcoma, but their role in chondrosarcoma staging is an emerging modality that is being investigated. Radiation is not typically used for local treatment of extremity chondrosarcoma. Extended curettage is not appropriate for a high-grade lesion such as this. Revision arthroplasty alone does not address the tumor. Wide resection is the local treatment of choice for high-grade chondrosarcoma; because of the fracture, this patient may require an amputation to achieve wide margins.
RECOMMENDED READINGS
1. [Henderson ER, Pala E, Angelini A, Rimondi E, Ruggieri P. Dedifferentiated peripheral chondrosarcoma: a review of radiologic characteristics. Sarcoma. 2013;2013:505321. doi: 10.1155/2013/505321. Epub 2013 Mar 25. PubMed PMID: 23589702. ](http://www.ncbi.nlm.nih.gov/pubmed/23589702)[View Abstract at PubMed](http://www.ncbi.nlm.nih.gov/pubmed/23589702)
2. [Grimer RJ, Gosheger G, Taminiau A, Biau D, Matejovsky Z, Kollender Y, San-Julian M, Gherlinzoni F, Ferrari C. Dedifferentiated chondrosarcoma: prognostic factors and outcome from a European group. Eur J Cancer. 2007 Sep;43(14):2060-5. Epub 2007 Aug 27. ](http://www.ncbi.nlm.nih.gov/pubmed/17720491)[View Abstract at PubMed](http://www.ncbi.nlm.nih.gov/pubmed/17720491)
3. [Mavrogenis AF, Gambarotti M, Angelini A, Palmerini E, Staals EL, Ruggieri P, Papagelopoulos PJ. Chondrosarcomas revisited. Orthopedics. 2012 Mar 7;35(3):e379-90. doi: 10.3928/01477447-20120222-30. PubMed PMID: 22385450. ](http://www.ncbi.nlm.nih.gov/pubmed/22385450)[View Abstract at PubMed](http://www.ncbi.nlm.nih.gov/pubmed/22385450)
4. [Flemming DJ, Murphey MD. Enchondroma and chondrosarcoma. Semin Musculoskelet Radiol. 2000;4(1):59-71. Review. PubMed PMID: 11061692. ](http://www.ncbi.nlm.nih.gov/pubmed/11061692)[View Abstract at PubMed](http://www.ncbi.nlm.nih.gov/pubmed/11061692)
QUESTION 54
of 100
Figures 55a through 55d are the MR images, intraoperative photograph, and biopsy specimen of a 33-year-old man with progressive knee pain and recurrent effusions. What is the most likely diagnosis?




Figures 55a through 55d are the MR images, intraoperative photograph, and biopsy specimen of a 33-year-old man with progressive knee pain and recurrent effusions. What is the most likely diagnosis?




1
Lipoma arborescens
2
Synovial osteochondromatosis
3
Pigmented villonodular synovitis (PVNS)
4
Intra-articular hemangioma
MR imaging and gross and microscopic specimens are consistent with PVNS. PVNS is a locally aggressive synovial tumor with 2 forms: diffuse and nodular. Nodular PVNS occurs most commonly in the hands, and diffuse is most common in the knee. Upon gross examination, the diffuse form of PVNS is a tan mass of villi and folds of synovium. Microscopically, PVNS is characterized by synovial cell hyperplasia on the surface and below the synovium. Lipoma arborescens would have imaging consistent with fat. Synovial chondromatosis would show synovium laden with cartilage tissue, and intra-articular hemangioma would show predominant vascular channels.
RECOMMENDED READINGS
5. [Ottaviani S, Ayral X, Dougados M, Gossec L. Pigmented villonodular synovitis: a retrospective single-center study of 122 cases and review of the literature. Semin Arthritis Rheum. 2011 Jun;40(6):539-46. doi: 10.1016/j.semarthrit.2010.07.005. Epub 2010 Sep 29. Review. PubMed PMID: 20884045. ](http://www.ncbi.nlm.nih.gov/pubmed/20884045)[View Abstract at PubMed](http://www.ncbi.nlm.nih.gov/pubmed/20884045)
6. [Bravo SM, Winalski CS, Weissman BN. Pigmented villonodular synovitis. Radiol Clin North Am. 1996 Mar;34(2):311-26, x-xi. Review. PubMed PMID: 8633118.](http://www.ncbi.nlm.nih.gov/pubmed/8633118)[View Abstract at PubMed](http://www.ncbi.nlm.nih.gov/pubmed/8633118)
RECOMMENDED READINGS
5. [Ottaviani S, Ayral X, Dougados M, Gossec L. Pigmented villonodular synovitis: a retrospective single-center study of 122 cases and review of the literature. Semin Arthritis Rheum. 2011 Jun;40(6):539-46. doi: 10.1016/j.semarthrit.2010.07.005. Epub 2010 Sep 29. Review. PubMed PMID: 20884045. ](http://www.ncbi.nlm.nih.gov/pubmed/20884045)[View Abstract at PubMed](http://www.ncbi.nlm.nih.gov/pubmed/20884045)
6. [Bravo SM, Winalski CS, Weissman BN. Pigmented villonodular synovitis. Radiol Clin North Am. 1996 Mar;34(2):311-26, x-xi. Review. PubMed PMID: 8633118.](http://www.ncbi.nlm.nih.gov/pubmed/8633118)[View Abstract at PubMed](http://www.ncbi.nlm.nih.gov/pubmed/8633118)
QUESTION 55
of 100
A disadvantage associated with presurgical (vs postsurgical) radiation therapy for soft-tissue sarcoma is a
A disadvantage associated with presurgical (vs postsurgical) radiation therapy for soft-tissue sarcoma is a
1
larger radiation field.
2
lack of formation of a “pseudocapsule” to facilitate resection.
3
higher local recurrence rate.
4
higher wound complication rate.
Radiation therapy is used for soft-tissue sarcoma treatment to facilitate resection of tumors that are close to adjacent structures and to diminish risk for local recurrence. The disadvantages of radiation therapy for soft-tissue sarcoma include patient inconvenience, risk for secondary malignancy, and higher wound complication rates. The advantages of presurgical (neoadjuvant) radiation therapy include a smaller radiation field, formation of a “pseudocapsule” to facilitate a planned close-margin resection, tumor shrinkage, and lower local recurrence rates. The main disadvantage of presurgical radiation therapy is the much higher risk for wound healing complications (as demonstrated in numerous studies).
RECOMMENDED READINGS
7. [O'Sullivan B, Davis AM, Turcotte R, Bell R, Catton C, Chabot P, Wunder J, Kandel R, Goddard K, Sadura A, Pater J, Zee B. Preoperative versus postoperative radiotherapy in soft-tissue sarcoma of the limbs: a randomised trial. Lancet. 2002 Jun 29;359(9325):2235-41. ](http://www.ncbi.nlm.nih.gov/pubmed/12103287)[View Abstract at PubMed](http://www.ncbi.nlm.nih.gov/pubmed/12103287)
8. [Zagars GK, Ballo MT, Pisters PW, Pollock RE, Patel SR, Benjamin RS. Preoperative vs. postoperative radiation therapy for soft tissue sarcoma: a retrospective comparative evaluation of disease outcome. Int J Radiat Oncol Biol Phys. 2003 Jun 1;56(2):482-8. ](http://www.ncbi.nlm.nih.gov/pubmed/12738324)[View Abstract at PubMed](http://www.ncbi.nlm.nih.gov/pubmed/12738324)
9. [Peat BG, Bell RS, Davis A, O'Sullivan B, Mahoney J, Manktelow RT, Bowen V, Catton C, Fornasier VL, Langer F. Wound-healing complications after soft-tissue sarcoma surgery. Plast Reconstr Surg. 1994 Apr;93(5):980-7. PubMed PMID: 8134491. ](http://www.ncbi.nlm.nih.gov/pubmed/8134491)[View Abstract at PubMed](http://www.ncbi.nlm.nih.gov/pubmed/8134491)
RECOMMENDED READINGS
7. [O'Sullivan B, Davis AM, Turcotte R, Bell R, Catton C, Chabot P, Wunder J, Kandel R, Goddard K, Sadura A, Pater J, Zee B. Preoperative versus postoperative radiotherapy in soft-tissue sarcoma of the limbs: a randomised trial. Lancet. 2002 Jun 29;359(9325):2235-41. ](http://www.ncbi.nlm.nih.gov/pubmed/12103287)[View Abstract at PubMed](http://www.ncbi.nlm.nih.gov/pubmed/12103287)
8. [Zagars GK, Ballo MT, Pisters PW, Pollock RE, Patel SR, Benjamin RS. Preoperative vs. postoperative radiation therapy for soft tissue sarcoma: a retrospective comparative evaluation of disease outcome. Int J Radiat Oncol Biol Phys. 2003 Jun 1;56(2):482-8. ](http://www.ncbi.nlm.nih.gov/pubmed/12738324)[View Abstract at PubMed](http://www.ncbi.nlm.nih.gov/pubmed/12738324)
9. [Peat BG, Bell RS, Davis A, O'Sullivan B, Mahoney J, Manktelow RT, Bowen V, Catton C, Fornasier VL, Langer F. Wound-healing complications after soft-tissue sarcoma surgery. Plast Reconstr Surg. 1994 Apr;93(5):980-7. PubMed PMID: 8134491. ](http://www.ncbi.nlm.nih.gov/pubmed/8134491)[View Abstract at PubMed](http://www.ncbi.nlm.nih.gov/pubmed/8134491)
QUESTION 56
of 100
Figures 57a and 57b are the close-up femur radiographs of a 73-year-old man with nonsmall-cell carcinoma of the lung with visceral metastases. He has localized thigh pain at rest and with any
range of motion of the ipsilateral hip or knee. A bone scan shows multiple areas of increased uptake. Other femur images in 2 views show no other lesions. The medical oncologist predicts a survival of 3 months. What is the best next step?


Figures 57a and 57b are the close-up femur radiographs of a 73-year-old man with nonsmall-cell carcinoma of the lung with visceral metastases. He has localized thigh pain at rest and with any
range of motion of the ipsilateral hip or knee. A bone scan shows multiple areas of increased uptake. Other femur images in 2 views show no other lesions. The medical oncologist predicts a survival of 3 months. What is the best next step?


1
Needle biopsy of the femur to confirm the diagnosis
2
Cephalomedullary femur nailing
3
Palliative radiation only
4
Curettage and cementation with plate fixation of the involved femur
A needle biopsy is not needed to confirm a diagnosis of metastatic disease when other sites of disease are present. Cephalomedullary nailing offers a percutaneous option to prophylactically stabilize the impending fracture and to assist in nursing and palliative care. Palliative radiation can be added, but risk for fracture (even with complete bedrest) is nearly 100% according to Mirels’ criteria. An open procedure offers no benefit to intramedullary nail placement.
Recently, CT-based structural rigidity analysis has proven more accurate than Mirels’ scoring for metastatic femoral lesion fracture prediction, but this analysis is unnecessary when the likelihood of progression to fracture is so marked.
RECOMMENDED READINGS
10. [Damron TA, Nazarian A, Entezari V, Brown C, Grant W, Calderon N, Zurakowski D, Terek RM, Anderson ME, Cheng EY, Aboulafia AJ, Gebhardt MC, Snyder BD. CT-based Structural Rigidity Analysis Is More Accurate Than Mirels Scoring for Fracture Prediction in Metastatic Femoral Lesions. Clin Orthop Relat Res. 2016 Mar;474(3):643-51. doi: 10.1007/s11999-015-4453-0. PubMed PMID: 26169800. ](http://www.ncbi.nlm.nih.gov/pubmed/26169800)[View Abstract at PubMed](http://www.ncbi.nlm.nih.gov/pubmed/26169800)
11. [Mirels H. Metastatic disease in long bones. A proposed scoring system for diagnosing impending pathologic fractures. Clin Orthop Relat Res. 1989 Dec;(249):256-64. PubMed PMID: 2684463. ](http://www.ncbi.nlm.nih.gov/pubmed/2684463)[View](http://www.ncbi.nlm.nih.gov/pubmed/2684463)[ ](http://www.ncbi.nlm.nih.gov/pubmed/2684463)[Abstract at PubMed](http://www.ncbi.nlm.nih.gov/pubmed/2684463)
12. [Ward WG, Holsenbeck S, Dorey FJ, Spang J, Howe D. Metastatic disease of the femur: surgical treatment. Clin Orthop Relat Res. 2003 Oct;(415 Suppl):S230-44. PubMed PMID: 14600615.](http://www.ncbi.nlm.nih.gov/pubmed/14600615)[View](http://www.ncbi.nlm.nih.gov/pubmed/14600615)[ ](http://www.ncbi.nlm.nih.gov/pubmed/14600615)[Abstract at PubMed](http://www.ncbi.nlm.nih.gov/pubmed/14600615)
Recently, CT-based structural rigidity analysis has proven more accurate than Mirels’ scoring for metastatic femoral lesion fracture prediction, but this analysis is unnecessary when the likelihood of progression to fracture is so marked.
RECOMMENDED READINGS
10. [Damron TA, Nazarian A, Entezari V, Brown C, Grant W, Calderon N, Zurakowski D, Terek RM, Anderson ME, Cheng EY, Aboulafia AJ, Gebhardt MC, Snyder BD. CT-based Structural Rigidity Analysis Is More Accurate Than Mirels Scoring for Fracture Prediction in Metastatic Femoral Lesions. Clin Orthop Relat Res. 2016 Mar;474(3):643-51. doi: 10.1007/s11999-015-4453-0. PubMed PMID: 26169800. ](http://www.ncbi.nlm.nih.gov/pubmed/26169800)[View Abstract at PubMed](http://www.ncbi.nlm.nih.gov/pubmed/26169800)
11. [Mirels H. Metastatic disease in long bones. A proposed scoring system for diagnosing impending pathologic fractures. Clin Orthop Relat Res. 1989 Dec;(249):256-64. PubMed PMID: 2684463. ](http://www.ncbi.nlm.nih.gov/pubmed/2684463)[View](http://www.ncbi.nlm.nih.gov/pubmed/2684463)[ ](http://www.ncbi.nlm.nih.gov/pubmed/2684463)[Abstract at PubMed](http://www.ncbi.nlm.nih.gov/pubmed/2684463)
12. [Ward WG, Holsenbeck S, Dorey FJ, Spang J, Howe D. Metastatic disease of the femur: surgical treatment. Clin Orthop Relat Res. 2003 Oct;(415 Suppl):S230-44. PubMed PMID: 14600615.](http://www.ncbi.nlm.nih.gov/pubmed/14600615)[View](http://www.ncbi.nlm.nih.gov/pubmed/14600615)[ ](http://www.ncbi.nlm.nih.gov/pubmed/14600615)[Abstract at PubMed](http://www.ncbi.nlm.nih.gov/pubmed/14600615)
QUESTION 57
of 100
Figures 58a through 58c are the radiograph, MR image, and sagittal CT scan of a 13-year-old boy with a 5-month history of a left hip injury. He has no current pain, but substantial, progressive limitations in hip flexion are present. What is the most likely diagnosis?







Figures 58a through 58c are the radiograph, MR image, and sagittal CT scan of a 13-year-old boy with a 5-month history of a left hip injury. He has no current pain, but substantial, progressive limitations in hip flexion are present. What is the most likely diagnosis?







1
Extraskeletal osteosarcoma
2
Myositis ossificans
3
Chondrosarcoma
4
Pelvic osteosarcoma
This patient has a mineralized mass in the soft tissues in the rectus femoris origin. The clinical history favors an avulsion injury with subsequent myositis ossificans, and the imaging is consistent with an ossified soft-tissue mass. Extraskeletal osteosarcoma is a rare soft-tissue sarcoma and is generally seen in adults. Chondrosarcoma is also generally seen in adults and would have a more chondroid matrix as opposed to mature-looking bone on a CT scan. Pelvic osteosarcoma could have this appearance on radiograph, but the CT scan and MR image confirm this is a soft-tissue process with mature mineralization.
RECOMMENDED READINGS
13. Tyler P, Saifuddin A. The imaging of myositis ossificans. Semin Musculoskelet Radiol. 2010 Jun;14(2):201-16. doi: 10.1055/s-0030-1253161. Epub 2010 May 18. Review. PubMed PMID:
[20486028/. ](http://www.ncbi.nlm.nih.gov/pubmed/20486028)[View Abstract at PubMed](http://www.ncbi.nlm.nih.gov/pubmed/20486028)
14. [Colman MW, Lozano-Calderon S, Raskin KA, Hornicek FJ, Gebhardt M. Non-neoplastic soft tissue masses that mimic sarcoma. Orthop Clin North Am. 2014 Apr;45(2):245-55. doi: 10.1016/j.ocl.2013.12.006. Epub 2014 Feb 1. Review. ](http://www.ncbi.nlm.nih.gov/pubmed/24684918)[View Abstract at PubMed](http://www.ncbi.nlm.nih.gov/pubmed/24684918)
CLINICAL SITUATION FOR QUESTIONS 59 THROUGH 61
Figures 59a through 59d are the CT scans and biopsy specimen of a 68-year-old man with progressive radicular symptoms in his left lower extremity. Four years previously he underwent treatment of colorectal cancer with surgery, chemotherapy, and radiotherapy.
RECOMMENDED READINGS
13. Tyler P, Saifuddin A. The imaging of myositis ossificans. Semin Musculoskelet Radiol. 2010 Jun;14(2):201-16. doi: 10.1055/s-0030-1253161. Epub 2010 May 18. Review. PubMed PMID:
[20486028/. ](http://www.ncbi.nlm.nih.gov/pubmed/20486028)[View Abstract at PubMed](http://www.ncbi.nlm.nih.gov/pubmed/20486028)
14. [Colman MW, Lozano-Calderon S, Raskin KA, Hornicek FJ, Gebhardt M. Non-neoplastic soft tissue masses that mimic sarcoma. Orthop Clin North Am. 2014 Apr;45(2):245-55. doi: 10.1016/j.ocl.2013.12.006. Epub 2014 Feb 1. Review. ](http://www.ncbi.nlm.nih.gov/pubmed/24684918)[View Abstract at PubMed](http://www.ncbi.nlm.nih.gov/pubmed/24684918)
CLINICAL SITUATION FOR QUESTIONS 59 THROUGH 61
Figures 59a through 59d are the CT scans and biopsy specimen of a 68-year-old man with progressive radicular symptoms in his left lower extremity. Four years previously he underwent treatment of colorectal cancer with surgery, chemotherapy, and radiotherapy.
QUESTION 58
of 100
What is the diagnosis?
What is the diagnosis?
1
Radiation-associated insufficiency fracture
2
Postradiation osteosarcoma
3
Postradiation sclerosis
4
Metastatic colorectal cancer
/- Postradiation osteosarcoma_
QUESTION 59
of 100
The best treatment is
The best treatment is
1
chemotherapy and wide surgical resection.
2
bisphosphonate treatment with or without sacroplasty.
3
gabapentin or similar pharmacologic therapy.
4
radiation therapy.
- chemotherapy and wide surgical resection._
QUESTION 60
of 100
The prognosis for this condition is
The prognosis for this condition is
1
influenced by the latent time to presentation.
2
generally favorable.
3
variable, with periodic flares and remissions.
4
relatively poor.
This patient has postradiation osteosarcoma of the sacrum after undergoing treatment for pelvic cancer. Examinees should discern that this is a postradiation sarcoma by the imaging findings of an osteoblastic tumor with extraosseous extension arising in the expected radiation field for a patient who was treated with radiation for colorectal cancer 5 years earlier. The histology demonstrates a high-grade sarcoma.
Postradiation sarcomas are treated with chemotherapy and margin-negative surgical resection, but they are associated with a relatively poor prognosis likely attributable to the advanced age of most affected patients and the frequent axial location of these tumors, which can delay diagnosis and make it difficult to obtain an appropriate margin of resection. The imaging reveals a tumor, not an insufficiency fracture or postradiation changes, and the histology shows a sarcoma, not colorectal cancer.
RECOMMENDED READINGS
15. [Mavrogenis AF, Pala E, Guerra G, Ruggieri P. Post-radiation sarcomas. Clinical outcome of 52 Patients. J Surg Oncol. 2012 May;105(6):570-6. doi: 10.1002/jso.22122. Epub 2011 Oct 19. PubMed PMID: 22012601.](http://www.ncbi.nlm.nih.gov/pubmed/22012601)[View Abstract at PubMed](http://www.ncbi.nlm.nih.gov/pubmed/22012601)
16. [Patel SR. Radiation-induced sarcoma. Curr Treat Options Oncol. 2000 Aug;1(3):258-61. Review. PubMed PMID: 12057168.](http://www.ncbi.nlm.nih.gov/pubmed/12057168)[View Abstract at PubMed](http://www.ncbi.nlm.nih.gov/pubmed/12057168)
Postradiation sarcomas are treated with chemotherapy and margin-negative surgical resection, but they are associated with a relatively poor prognosis likely attributable to the advanced age of most affected patients and the frequent axial location of these tumors, which can delay diagnosis and make it difficult to obtain an appropriate margin of resection. The imaging reveals a tumor, not an insufficiency fracture or postradiation changes, and the histology shows a sarcoma, not colorectal cancer.
RECOMMENDED READINGS
15. [Mavrogenis AF, Pala E, Guerra G, Ruggieri P. Post-radiation sarcomas. Clinical outcome of 52 Patients. J Surg Oncol. 2012 May;105(6):570-6. doi: 10.1002/jso.22122. Epub 2011 Oct 19. PubMed PMID: 22012601.](http://www.ncbi.nlm.nih.gov/pubmed/22012601)[View Abstract at PubMed](http://www.ncbi.nlm.nih.gov/pubmed/22012601)
16. [Patel SR. Radiation-induced sarcoma. Curr Treat Options Oncol. 2000 Aug;1(3):258-61. Review. PubMed PMID: 12057168.](http://www.ncbi.nlm.nih.gov/pubmed/12057168)[View Abstract at PubMed](http://www.ncbi.nlm.nih.gov/pubmed/12057168)
QUESTION 61
of 100
Figures 62a and 62b are the radiographs of a 69-year-old woman who is seen for follow-up of a right arm posterior compartment high-grade soft-tissue sarcoma. She previously underwent wide resection of the tumor with preservation of the radial. She experienced an atraumatic fracture 2 years after completion of all treatment. There is no evidence of recurrence on MR imaging. The patient desires treatment because of pain and instability at the fracture site. What is the most reliable treatment option?


Figures 62a and 62b are the radiographs of a 69-year-old woman who is seen for follow-up of a right arm posterior compartment high-grade soft-tissue sarcoma. She previously underwent wide resection of the tumor with preservation of the radial. She experienced an atraumatic fracture 2 years after completion of all treatment. There is no evidence of recurrence on MR imaging. The patient desires treatment because of pain and instability at the fracture site. What is the most reliable treatment option?


1
Injection of platelet-rich plasma and transcutaneous electrical stimulation
2
Debridement of the nonunion site, plate fixation of the fracture, and autologous bone grafting
3
Cemented long-stem proximal humerus replacement
4
Intramedullary humeral nail with bone morphogenetic protein-2 application
Cemented long-stem proximal humerus replacement is not dependent upon bone healing and will protect the remaining humeral diaphysis against subsequent fracture. Multiple studies have demonstrated high failure rates with attempted fixation of radiation-associated fractures. The radiated bone has low capacity for healing regardless of the fixation technique. Although bone graft, platelet-rich plasma, growth factors, and electrical stimulation may have efficacy for other delayed unions and nonunions, their efficacy has not been reliably demonstrated for radiation-associated fractures.
RECOMMENDED READINGS
17. [Cannon CP, Lin PP, Lewis VO, Yasko AW. Management of radiation-associated fractures. J Am Acad Orthop Surg. 2008 Sep;16(9):541-9. Review. PubMed PMID: 18768711.](http://www.ncbi.nlm.nih.gov/pubmed/18768711)[View Abstract at PubMed](http://www.ncbi.nlm.nih.gov/pubmed/18768711)
18. [Nicholls F, Janic K, Filomeno P, Willett T, Grynpas M, Ferguson P. Effects of radiation and surgery on healing of femoral fractures in a rat model. J Orthop Res. 2013 Aug;31(8):1323-31. doi: 10.1002/jor.22351. Epub 2013 Apr 19. PubMed PMID: 23606416. ](http://www.ncbi.nlm.nih.gov/pubmed/23606416)[View Abstract at PubMed](http://www.ncbi.nlm.nih.gov/pubmed/23606416)
19. Sternheim A, Saidi K, Lochab J, O'Donnell PW, Eward WC, Griffin A, Wunder JS, Ferguson P. Internal fixation of radiation-induced pathological fractures of the femur has a high rate of failure. Bone Joint
[J. 2013 Aug;95-B(8):1144-8. doi: 10.1302/0301-620X.95B8.31832. PubMed PMID: 23908434. ](http://www.ncbi.nlm.nih.gov/pubmed/23908434)[View](http://www.ncbi.nlm.nih.gov/pubmed/23908434)
[Abstract at PubMed](http://www.ncbi.nlm.nih.gov/pubmed/23908434)
RECOMMENDED READINGS
17. [Cannon CP, Lin PP, Lewis VO, Yasko AW. Management of radiation-associated fractures. J Am Acad Orthop Surg. 2008 Sep;16(9):541-9. Review. PubMed PMID: 18768711.](http://www.ncbi.nlm.nih.gov/pubmed/18768711)[View Abstract at PubMed](http://www.ncbi.nlm.nih.gov/pubmed/18768711)
18. [Nicholls F, Janic K, Filomeno P, Willett T, Grynpas M, Ferguson P. Effects of radiation and surgery on healing of femoral fractures in a rat model. J Orthop Res. 2013 Aug;31(8):1323-31. doi: 10.1002/jor.22351. Epub 2013 Apr 19. PubMed PMID: 23606416. ](http://www.ncbi.nlm.nih.gov/pubmed/23606416)[View Abstract at PubMed](http://www.ncbi.nlm.nih.gov/pubmed/23606416)
19. Sternheim A, Saidi K, Lochab J, O'Donnell PW, Eward WC, Griffin A, Wunder JS, Ferguson P. Internal fixation of radiation-induced pathological fractures of the femur has a high rate of failure. Bone Joint
[J. 2013 Aug;95-B(8):1144-8. doi: 10.1302/0301-620X.95B8.31832. PubMed PMID: 23908434. ](http://www.ncbi.nlm.nih.gov/pubmed/23908434)[View](http://www.ncbi.nlm.nih.gov/pubmed/23908434)
[Abstract at PubMed](http://www.ncbi.nlm.nih.gov/pubmed/23908434)
QUESTION 62
of 100
Figures 63a through 63d are the radiograph, CT scan, MR image, and biopsy specimen of a 20-year-old rower who has a several-month history of low-back pain. He has lost 10 pounds, but has no other constitutional symptoms. There is no bowel or bladder incontinence, and he does not have neurologic symptoms. Which medication can be used to treat this condition?




Figures 63a through 63d are the radiograph, CT scan, MR image, and biopsy specimen of a 20-year-old rower who has a several-month history of low-back pain. He has lost 10 pounds, but has no other constitutional symptoms. There is no bowel or bladder incontinence, and he does not have neurologic symptoms. Which medication can be used to treat this condition?




1
Methotrexate
2
Nonsteroidal anti-inflammatory drugs (NSAIDs)
3
Denosumab
4
Adriamycin
Giant-cell tumor of bone (GCTB) is characterized by numerous multinucleated osteoclast-type giant cells. Giant cells are known to express receptor activator of nuclear factor ?B ligand (RANKL) and are responsible for the aggressive osteolytic nature of tumors. Denosumab is a human monoclonal antibody that targets and binds with high specificity to RANKL. Although generally benign, GCTB may be associated with multiple local recurrences, multicentricity, pulmonary metastases, or lesions that cannot be removed surgically without causing substantial morbidity. In a recent phase 2 study, denosumab administered to patients with surgically salvageable and unsalvageable GCTB was well tolerated and associated with inhibited disease progression (99%) and a reduced requirement for surgery. Methotrexate and adriamycin are common chemotherapeutic drugs used in the treatment of osteosarcoma of bone, but they have shown no efficacy in the treatment of GCTB. NSAIDs are useful for treating pain associated with osteoid osteomas, but they have no effect on GCTB.
RECOMMENDED READINGS
20. [Xu SF, Adams B, Yu XC, Xu M. Denosumab and giant cell tumour of bone-a review and future management considerations. Curr Oncol. 2013 Oct;20(5):e442-7. doi: 10.3747/co.20.1497. Review. PubMed PMID: 24155640.](http://www.ncbi.nlm.nih.gov/pubmed/24155640)[View Abstract at PubMed](http://www.ncbi.nlm.nih.gov/pubmed/24155640)
21. [Chawla S, Henshaw R, Seeger L, Choy E, Blay JY, Ferrari S, Kroep J, Grimer R, Reichardt P, Rutkowski P, Schuetze S, Skubitz K, Staddon A, Thomas D, Qian Y, Jacobs I. Safety and efficacy of denosumab for adults and skeletally mature adolescents with giant cell tumour of bone: interim analysis of an open-label, parallel-group, phase 2 study. Lancet Oncol. 2013 Aug;14(9):901-8. doi: 10.1016/S1470-2045(13)70277-8. Epub 2013 Jul 16.](http://www.ncbi.nlm.nih.gov/pubmed/23867211)[View Abstract at PubMed](http://www.ncbi.nlm.nih.gov/pubmed/23867211)
22. Balke M, Hardes J. Denosumab: a breakthrough in treatment of giant-cell tumour of bone? Lancet Oncol. 2010 Mar;11(3):218-9. doi: 10.1016/S1470-2045(10)70027-9. Epub 2010 Feb 10. PubMed
[PMID: 20149737.](http://www.ncbi.nlm.nih.gov/pubmed/20149737)[View Abstract at PubMed](http://www.ncbi.nlm.nih.gov/pubmed/20149737)
RECOMMENDED READINGS
20. [Xu SF, Adams B, Yu XC, Xu M. Denosumab and giant cell tumour of bone-a review and future management considerations. Curr Oncol. 2013 Oct;20(5):e442-7. doi: 10.3747/co.20.1497. Review. PubMed PMID: 24155640.](http://www.ncbi.nlm.nih.gov/pubmed/24155640)[View Abstract at PubMed](http://www.ncbi.nlm.nih.gov/pubmed/24155640)
21. [Chawla S, Henshaw R, Seeger L, Choy E, Blay JY, Ferrari S, Kroep J, Grimer R, Reichardt P, Rutkowski P, Schuetze S, Skubitz K, Staddon A, Thomas D, Qian Y, Jacobs I. Safety and efficacy of denosumab for adults and skeletally mature adolescents with giant cell tumour of bone: interim analysis of an open-label, parallel-group, phase 2 study. Lancet Oncol. 2013 Aug;14(9):901-8. doi: 10.1016/S1470-2045(13)70277-8. Epub 2013 Jul 16.](http://www.ncbi.nlm.nih.gov/pubmed/23867211)[View Abstract at PubMed](http://www.ncbi.nlm.nih.gov/pubmed/23867211)
22. Balke M, Hardes J. Denosumab: a breakthrough in treatment of giant-cell tumour of bone? Lancet Oncol. 2010 Mar;11(3):218-9. doi: 10.1016/S1470-2045(10)70027-9. Epub 2010 Feb 10. PubMed
[PMID: 20149737.](http://www.ncbi.nlm.nih.gov/pubmed/20149737)[View Abstract at PubMed](http://www.ncbi.nlm.nih.gov/pubmed/20149737)
QUESTION 63
of 100
Which blastic metastases to bone are most common?
Which blastic metastases to bone are most common?
1
Breast and prostate carcinomas
2
Renal cell and thyroid carcinomas
3
Cervical and bladder carcinomas
4
Lung and liver carcinomas
Breast and prostate bone metastases are often blastic but may be lucent or mixed. The other responses are predominantly lucent. Algorithms to detect spinal metastases have been developed because the spine and pelvis are the most common locations for metastases.
RECOMMENDED READINGS
23. Hammon M, Dankerl P, Tsymbal A, Wels M, Kelm M, May M, Suehling M, Uder M, Cavallaro A. Automatic detection of lytic and blastic thoracolumbar spine metastases on computed tomography. Eur Radiol. 2013 Jul;23(7):1862-70. doi: 10.1007/s00330-013-2774-5. Epub 2013 Feb 9. PubMed PMID:
[23397381/. ](http://www.ncbi.nlm.nih.gov/pubmed/23397381)[View Abstract at PubMed](http://www.ncbi.nlm.nih.gov/pubmed/23397381)
24. Nielsen GP, Rosenberg AE. _Diagnostic Pathology Bone_. Manitoba, Canada: Amirsys; 2013:14.1-14.7.
RECOMMENDED READINGS
23. Hammon M, Dankerl P, Tsymbal A, Wels M, Kelm M, May M, Suehling M, Uder M, Cavallaro A. Automatic detection of lytic and blastic thoracolumbar spine metastases on computed tomography. Eur Radiol. 2013 Jul;23(7):1862-70. doi: 10.1007/s00330-013-2774-5. Epub 2013 Feb 9. PubMed PMID:
[23397381/. ](http://www.ncbi.nlm.nih.gov/pubmed/23397381)[View Abstract at PubMed](http://www.ncbi.nlm.nih.gov/pubmed/23397381)
24. Nielsen GP, Rosenberg AE. _Diagnostic Pathology Bone_. Manitoba, Canada: Amirsys; 2013:14.1-14.7.
QUESTION 64
of 100
Figures 65a and 65b are the axial and coronal MR images of a 72-year-old woman who underwent a right knee arthroplasty 14 years ago. She has been referred by her primary care provider for evaluation and management of a right medial knee mass. What is the next best step?


Figures 65a and 65b are the axial and coronal MR images of a 72-year-old woman who underwent a right knee arthroplasty 14 years ago. She has been referred by her primary care provider for evaluation and management of a right medial knee mass. What is the next best step?


1
Open surgical biopsy
2
Bone scan
3
Right knee radiographs
4
Staging CT scan of chest
The MR images reveal metal artifact from the knee arthroplasty and a large mass medial to the joint line that has a relatively dark signal. Because this patient had knee arthroplasty 14 years ago, a large amount of polyethylene debris may have caused a pseudotumor mass. A radiograph would reveal evidence of radiographic wear/failure and is the best next step. If the patient needs revision knee arthroplasty, a biopsy with frozen section could be performed at the same time. Open biopsy might be appropriate, but further information for pathologists regarding potential polyethylene
wear would be helpful. Embarking upon a staging workup at this point is unnecessary and is not cost effective.
RECOMMENDED READINGS
25. [Mavrogenis AF, Nomikos GN, Sakellariou VI, Karaliotas GI, Kontovazenitis P, Papagelopoulos PJ. Wear debris pseudotumor following total knee arthroplasty: a case report. J Med Case Rep. 2009 Nov 29;3:9304. doi: 10.1186/1752-1947-3-9304. PubMed PMID: 20062793. ](http://www.ncbi.nlm.nih.gov/pubmed/20062793)[View Abstract at PubMed](http://www.ncbi.nlm.nih.gov/pubmed/20062793)
26. [Chavda DV, Garvin KL. Failure of a polyethylene total knee component presenting as a thigh mass. Report of a rare complication of total knee arthroplasty. Clin Orthop Relat Res. 1994 Jun;(303):211-6. PubMed PMID: 8194236. ](http://www.ncbi.nlm.nih.gov/pubmed/8194236)[View Abstract at PubMed](http://www.ncbi.nlm.nih.gov/pubmed/8194236)
27. [Naudie DD, Ammeen DJ, Engh GA, Rorabeck CH. Wear and osteolysis around total knee arthroplasty. J Am Acad Orthop Surg. 2007 Jan;15(1):53-64. Review. ](http://www.ncbi.nlm.nih.gov/pubmed/17213382)[View Abstract at PubMed](http://www.ncbi.nlm.nih.gov/pubmed/17213382)
wear would be helpful. Embarking upon a staging workup at this point is unnecessary and is not cost effective.
RECOMMENDED READINGS
25. [Mavrogenis AF, Nomikos GN, Sakellariou VI, Karaliotas GI, Kontovazenitis P, Papagelopoulos PJ. Wear debris pseudotumor following total knee arthroplasty: a case report. J Med Case Rep. 2009 Nov 29;3:9304. doi: 10.1186/1752-1947-3-9304. PubMed PMID: 20062793. ](http://www.ncbi.nlm.nih.gov/pubmed/20062793)[View Abstract at PubMed](http://www.ncbi.nlm.nih.gov/pubmed/20062793)
26. [Chavda DV, Garvin KL. Failure of a polyethylene total knee component presenting as a thigh mass. Report of a rare complication of total knee arthroplasty. Clin Orthop Relat Res. 1994 Jun;(303):211-6. PubMed PMID: 8194236. ](http://www.ncbi.nlm.nih.gov/pubmed/8194236)[View Abstract at PubMed](http://www.ncbi.nlm.nih.gov/pubmed/8194236)
27. [Naudie DD, Ammeen DJ, Engh GA, Rorabeck CH. Wear and osteolysis around total knee arthroplasty. J Am Acad Orthop Surg. 2007 Jan;15(1):53-64. Review. ](http://www.ncbi.nlm.nih.gov/pubmed/17213382)[View Abstract at PubMed](http://www.ncbi.nlm.nih.gov/pubmed/17213382)
QUESTION 65
of 100
Figures 66a and 66b are the clinical photographs of an 86-year-old man with a high-grade undifferentiated pleomorphic sarcoma of the right thigh. He is pictured during preparations for wide surgical excision. What is a favorable prognostic factor?


Figures 66a and 66b are the clinical photographs of an 86-year-old man with a high-grade undifferentiated pleomorphic sarcoma of the right thigh. He is pictured during preparations for wide surgical excision. What is a favorable prognostic factor?


1
Superficial location with ulceration
2
Appendicular, lower extremity location
3
Histological evidence of extensive necrosis
4
Local inflammatory reaction to tumor
Improved survival is found in patients with soft-tissue sarcoma involving the extremities (appendicular) rather than the torso (axial) or head and neck. Although the superficial location above the fascia is associated with improved survival, malignant ulceration or fungation is an independent risk factor for poor outcome. Areas of extensive necrosis are routinely found in high-
grade undifferentiated pleomorphic sarcomas and do not suggest a favorable prognosis. Local inflammatory reactions to malignant ulceration do not improve survival.
RECOMMENDED READINGS
28. [Potter BK, Adams SC, Qadir R, Pitcher JD, Temple HT. Fungating soft-tissue sarcomas. Treatment implications and prognostic importance of malignant ulceration. J Bone Joint Surg Am. 2009 Mar 1;91(3):567-74. doi: 10.2106/JBJS.H.00071. PubMed PMID: 19255216. ](http://www.ncbi.nlm.nih.gov/pubmed/19255216)[View Abstract at PubMed](http://www.ncbi.nlm.nih.gov/pubmed/19255216)
29. [Brennan MF, Antonescu CR, Moraco N, Singer S. Lessons learned from the study of 10,000 patients with soft tissue sarcoma. Ann Surg. 2014 Sep;260(3):416-21; discussion 421-2. doi: 10.1097/SLA.0000000000000869. PubMed PMID: 25115417. ](http://www.ncbi.nlm.nih.gov/pubmed/25115417)[View Abstract at PubMed](http://www.ncbi.nlm.nih.gov/pubmed/25115417)
grade undifferentiated pleomorphic sarcomas and do not suggest a favorable prognosis. Local inflammatory reactions to malignant ulceration do not improve survival.
RECOMMENDED READINGS
28. [Potter BK, Adams SC, Qadir R, Pitcher JD, Temple HT. Fungating soft-tissue sarcomas. Treatment implications and prognostic importance of malignant ulceration. J Bone Joint Surg Am. 2009 Mar 1;91(3):567-74. doi: 10.2106/JBJS.H.00071. PubMed PMID: 19255216. ](http://www.ncbi.nlm.nih.gov/pubmed/19255216)[View Abstract at PubMed](http://www.ncbi.nlm.nih.gov/pubmed/19255216)
29. [Brennan MF, Antonescu CR, Moraco N, Singer S. Lessons learned from the study of 10,000 patients with soft tissue sarcoma. Ann Surg. 2014 Sep;260(3):416-21; discussion 421-2. doi: 10.1097/SLA.0000000000000869. PubMed PMID: 25115417. ](http://www.ncbi.nlm.nih.gov/pubmed/25115417)[View Abstract at PubMed](http://www.ncbi.nlm.nih.gov/pubmed/25115417)
QUESTION 66
of 100
Figures 67a and 67b are the fused positron emission tomography/CT scans of a calf lesion at groin level in a 36-year-old woman with a soft-tissue mass. Her biopsy specimen is shown in Figure 67c. Staging studies reveal no other lesions. Using the American Joint Committee on Cancer (AJCC) staging system, the stage is most likely



Figures 67a and 67b are the fused positron emission tomography/CT scans of a calf lesion at groin level in a 36-year-old woman with a soft-tissue mass. Her biopsy specimen is shown in Figure 67c. Staging studies reveal no other lesions. Using the American Joint Committee on Cancer (AJCC) staging system, the stage is most likely



1
IA (G1 T2b N0 M0).
2
IIB (G1 T2b N0 M0).
3
III (G3 T2b N1 M0).
4
IV (G3 T2b N1 M1).
This patient has a high-grade subcutaneous angiosarcoma (G3 lesion) with subfascial extension as seen in Figure 67a and nodal metastases as seen in Figure 67b (N1 [1 regional lymph node]). Because there are no other lesions identified, there are no distant metastases. Tumor size is difficult to determine without a full imaging study, but all responses are T2b (tumors >5 cm with deep extension). This is a stage III tumor according to the AJCC system.
RECOMMENDED READINGS
30. Edge SB, Byrd DR, Compton CC, Fritz AG, Greene FL, Trotti A, eds. _AJCC Cancer Staging Manual_. 7th ed. New York, NY: Springer; 2010, chapter 20.
31. Young RJ, Brown NJ, Reed MW, Hughes D, Woll PJ. Angiosarcoma. Lancet Oncol. 2010 Oct;11(10):983-91. doi: 10.1016/S1470-2045(10)70023-1. Epub 2010 May 25. Review. PubMed
[PMID: 20537949. ](http://www.ncbi.nlm.nih.gov/pubmed/20537949)[View Abstract at PubMed](http://www.ncbi.nlm.nih.gov/pubmed/20537949)
32. [National Cancer Institute: Adult Soft Tissue Sarcoma Treatment.](http://www.cancer.gov/cancertopics/pdq/treatment/adult-soft-tissue-sarcoma/Health%20Professional%20/%20page3)[http://www.cancer.gov/cancertopics/pdq/treatment/adult-soft-tissue-sarcoma/Health](http://www.cancer.gov/cancertopics/pdq/treatment/adult-soft-tissue-sarcoma/Health%20Professional%20/%20page3)[ ](http://www.cancer.gov/cancertopics/pdq/treatment/adult-soft-tissue-sarcoma/Health%20Professional%20/%20page3)Professional / page3 _(Accessed September 26, 2016)_.
RECOMMENDED READINGS
30. Edge SB, Byrd DR, Compton CC, Fritz AG, Greene FL, Trotti A, eds. _AJCC Cancer Staging Manual_. 7th ed. New York, NY: Springer; 2010, chapter 20.
31. Young RJ, Brown NJ, Reed MW, Hughes D, Woll PJ. Angiosarcoma. Lancet Oncol. 2010 Oct;11(10):983-91. doi: 10.1016/S1470-2045(10)70023-1. Epub 2010 May 25. Review. PubMed
[PMID: 20537949. ](http://www.ncbi.nlm.nih.gov/pubmed/20537949)[View Abstract at PubMed](http://www.ncbi.nlm.nih.gov/pubmed/20537949)
32. [National Cancer Institute: Adult Soft Tissue Sarcoma Treatment.](http://www.cancer.gov/cancertopics/pdq/treatment/adult-soft-tissue-sarcoma/Health%20Professional%20/%20page3)[http://www.cancer.gov/cancertopics/pdq/treatment/adult-soft-tissue-sarcoma/Health](http://www.cancer.gov/cancertopics/pdq/treatment/adult-soft-tissue-sarcoma/Health%20Professional%20/%20page3)[ ](http://www.cancer.gov/cancertopics/pdq/treatment/adult-soft-tissue-sarcoma/Health%20Professional%20/%20page3)Professional / page3 _(Accessed September 26, 2016)_.
QUESTION 67
of 100
Figure 68a is the clinical photograph of a 59-year-old woman who has had a long-standing fungating ulcer on her left lower leg. She states that the ulcer began as a small reddened area and gradually enlarged during the last 4 years. Anteroposterior (AP) and lateral radiographs of her left leg are shown in Figures 68b and 68c. A whole-body bone scan is shown in Figure 68d. An axial T1-weighted MR image is shown in Figure 68e. A CT scan of the pelvis at the level of the groin is shown in Figure 68f. A histologic specimen is shown in Figure 68g. Based on the clinical, radiographic, and histologic information, the diagnosis is










Figure 68a is the clinical photograph of a 59-year-old woman who has had a long-standing fungating ulcer on her left lower leg. She states that the ulcer began as a small reddened area and gradually enlarged during the last 4 years. Anteroposterior (AP) and lateral radiographs of her left leg are shown in Figures 68b and 68c. A whole-body bone scan is shown in Figure 68d. An axial T1-weighted MR image is shown in Figure 68e. A CT scan of the pelvis at the level of the groin is shown in Figure 68f. A histologic specimen is shown in Figure 68g. Based on the clinical, radiographic, and histologic information, the diagnosis is










1
poorly differentiated squamous carcinoma.
2
dermatofibrosarcoma protuberans.
3
melanoma.
4
locally advanced osteomyelitis.
The clinical photograph reveals a large ulcerated lesion of the anterior leg. The AP and lateral radiographs reveal the soft-tissue abnormality, and the bone scan reveals increased metabolic activity of the underlying tibia. T1-weighted MR imaging reveals the lesion wrapping around the anterior tibia with loss of subcutaneous tissue. A CT scan of the pelvis reveals an inguinal lymph node. The histology reveals nests of polyhedral cells surrounded by reactive fibrosis. The diagnosis is poorly differentiated squamous cell carcinoma, and the patient has the characteristic findings of a long-standing squamous cell carcinoma with poor differentiation and likely regional lymph node metastasis. The history of a small reddened area does not suggest any of the other diagnoses. Although keratin pearls are not shown in this histologic field, nests of polyhedral cells indicate squamous cell carcinoma. A small subset of patients with squamous cell carcinoma will have advanced disease. Size and differentiation, as well as type of surgical procedure and margins of resection, are of prognostic significance. Sentinel node evaluation for patients at high risk has been suggested, including evaluations for lesions that are larger in size and with poor differentiation, perineural invasion, or compromised immunologic states. The nonpreferred responses are not associated with the clinical presentation of squamous cell carcinoma. Squamous cell carcinomas are keratin positive on immunohistochemistry.
RECOMMENDED READINGS
33. [Kwon S, Dong ZM, Wu PC. Sentinel lymph node biopsy for high-risk cutaneous squamous cell carcinoma: clinical experience and review of literature. World J Surg Oncol. 2011 Jul 19;9:80. doi: 10.1186/1477-7819-9-80. Review. PubMed PMID: 21771334.](http://www.ncbi.nlm.nih.gov/pubmed/21771334)[View Abstract at PubMed](http://www.ncbi.nlm.nih.gov/pubmed/21771334)
34. [North JH Jr, Spellman JE, Driscoll D, Velez A, Kraybill WG, Petrelli NJ. Advanced cutaneous squamous cell carcinoma of the trunk and extremity: analysis of prognostic factors. J Surg Oncol. 1997 Mar;64(3):212-7. PubMed PMID: 9121152.](http://www.ncbi.nlm.nih.gov/pubmed/9121152)[View Abstract at PubMed](http://www.ncbi.nlm.nih.gov/pubmed/9121152)
CLINICAL SITUATION FOR QUESTIONS 69 AND 70
Figure 69a is the radiograph of a 39-year-old woman with metastatic lung cancer who underwent a prophylactic right intramedullary nail procedure. There were no intraoperative or immediate postsurgical problems. Ten hours after surgery, the patient became increasingly confused and agitated. An examination was notable for altered mentation, tachycardia, and new-onset hypoxemia. Chest radiographs were obtained before surgery (Figure 69b) and immediately after symptom onset (Figure 69c).
RECOMMENDED READINGS
33. [Kwon S, Dong ZM, Wu PC. Sentinel lymph node biopsy for high-risk cutaneous squamous cell carcinoma: clinical experience and review of literature. World J Surg Oncol. 2011 Jul 19;9:80. doi: 10.1186/1477-7819-9-80. Review. PubMed PMID: 21771334.](http://www.ncbi.nlm.nih.gov/pubmed/21771334)[View Abstract at PubMed](http://www.ncbi.nlm.nih.gov/pubmed/21771334)
34. [North JH Jr, Spellman JE, Driscoll D, Velez A, Kraybill WG, Petrelli NJ. Advanced cutaneous squamous cell carcinoma of the trunk and extremity: analysis of prognostic factors. J Surg Oncol. 1997 Mar;64(3):212-7. PubMed PMID: 9121152.](http://www.ncbi.nlm.nih.gov/pubmed/9121152)[View Abstract at PubMed](http://www.ncbi.nlm.nih.gov/pubmed/9121152)
CLINICAL SITUATION FOR QUESTIONS 69 AND 70
Figure 69a is the radiograph of a 39-year-old woman with metastatic lung cancer who underwent a prophylactic right intramedullary nail procedure. There were no intraoperative or immediate postsurgical problems. Ten hours after surgery, the patient became increasingly confused and agitated. An examination was notable for altered mentation, tachycardia, and new-onset hypoxemia. Chest radiographs were obtained before surgery (Figure 69b) and immediately after symptom onset (Figure 69c).
QUESTION 68
of 100
Which treatment will most likely improve this patient’s condition?
Which treatment will most likely improve this patient’s condition?
1
Broad-spectrum intravenous antibiotics
2
High-dose corticosteroids
3
Resuscitation and oxygen
4
Anticoagulation with heparin
- Resuscitation and oxygen_
QUESTION 69
of 100
Which prophylactic measures may decrease risk for this postsurgical complication?
Which prophylactic measures may decrease risk for this postsurgical complication?
1
Distal femoral venting, perioperative hydration, and oxygenation
2
Presurgical antibiotics and antibiotic redosing
3
Perioperative normothermia with a forced-air warming device
4
Neuraxial or regional anesthesia
This patient’s history, examination, and imaging findings are most consistent with fat embolism syndrome (FES). Classic findings of FES are mental status changes, hypoxemia, and petechial rash developing after intramedullary instrumentation procedures. FES is more common after closed femoral nailing for cancer treatment than after traumatic fractures. Patients with preexisting cardiopulmonary dysfunction are at increased risk. FES remains a clinical diagnosis, although a
high-resolution CT scan may distinguish fat emboli from thrombi, and diffusion-weighted brain MRI may demonstrate fat emboli. Aggressive supportive care including as-needed mechanical ventilation and fluid resuscitation remains the primary treatment. A 2009 meta-analysis suggested that prophylactic steroids reduce the incidence and severity of FES, but evidence supporting the use of corticosteroids for established FES is anecdotal.
FES prophylaxis generally consists of intraoperative hydration and oxygenation. Some authors suggest that distal femoral venting is beneficial to decrease intramedullary pressure and subsequent fat embolism. Broad-spectrum antibiotics would be an appropriate treatment for aspiration pneumonia. This patient has diffuse bilateral infiltrates as opposed to a focal infiltrate. Furthermore, the mental status changes are more consistent with FES than pneumonia. Anticoagulation would be the treatment of choice for pulmonary embolism. The timing after surgery is more consistent with FES, as are the changes in mental status.
RECOMMENDED READINGS
35. [Bederman SS, Bhandari M, McKee MD, Schemitsch EH. Do corticosteroids reduce the risk of fat embolism syndrome in patients with long-bone fractures? A meta-analysis. Can J Surg. 2009 Oct;52(5):386-93. Review. PubMed PMID: 19865573.](http://www.ncbi.nlm.nih.gov/pubmed/19865573)[View Abstract at PubMed](http://www.ncbi.nlm.nih.gov/pubmed/19865573)
36. [Georgopoulos D, Bouros D. Fat embolism syndrome: clinical examination is still the preferable diagnostic method. Chest. 2003 Apr;123(4):982-3. PubMed PMID: 12684280. ](http://www.ncbi.nlm.nih.gov/pubmed/12684280)[View Abstract at](http://www.ncbi.nlm.nih.gov/pubmed/12684280)[ ](http://www.ncbi.nlm.nih.gov/pubmed/12684280)[PubMed](http://www.ncbi.nlm.nih.gov/pubmed/12684280)
37. [Kosova E, Bergmark B, Piazza G. Fat embolism syndrome. Circulation. 2015 Jan 20;131(3):317-20. doi: 10.1161/CIRCULATIONAHA.114.010835. PubMed PMID: 25601951. ](http://www.ncbi.nlm.nih.gov/pubmed/25601951)[View Abstract at ](http://www.ncbi.nlm.nih.gov/pubmed/25601951)[PubMed](http://www.ncbi.nlm.nih.gov/pubmed/25601951)
38. [Martin R, Leighton RK, Petrie D, Ikejiani C, Smyth B. Effect of proximal and distal venting during intramedullary nailing. Clin Orthop Relat Res. 1996 Nov;(332):80-9. PubMed PMID: 8913148. ](http://www.ncbi.nlm.nih.gov/pubmed/8913148)[View](http://www.ncbi.nlm.nih.gov/pubmed/8913148)[ ](http://www.ncbi.nlm.nih.gov/pubmed/8913148)[Abstract at PubMed](http://www.ncbi.nlm.nih.gov/pubmed/8913148)
high-resolution CT scan may distinguish fat emboli from thrombi, and diffusion-weighted brain MRI may demonstrate fat emboli. Aggressive supportive care including as-needed mechanical ventilation and fluid resuscitation remains the primary treatment. A 2009 meta-analysis suggested that prophylactic steroids reduce the incidence and severity of FES, but evidence supporting the use of corticosteroids for established FES is anecdotal.
FES prophylaxis generally consists of intraoperative hydration and oxygenation. Some authors suggest that distal femoral venting is beneficial to decrease intramedullary pressure and subsequent fat embolism. Broad-spectrum antibiotics would be an appropriate treatment for aspiration pneumonia. This patient has diffuse bilateral infiltrates as opposed to a focal infiltrate. Furthermore, the mental status changes are more consistent with FES than pneumonia. Anticoagulation would be the treatment of choice for pulmonary embolism. The timing after surgery is more consistent with FES, as are the changes in mental status.
RECOMMENDED READINGS
35. [Bederman SS, Bhandari M, McKee MD, Schemitsch EH. Do corticosteroids reduce the risk of fat embolism syndrome in patients with long-bone fractures? A meta-analysis. Can J Surg. 2009 Oct;52(5):386-93. Review. PubMed PMID: 19865573.](http://www.ncbi.nlm.nih.gov/pubmed/19865573)[View Abstract at PubMed](http://www.ncbi.nlm.nih.gov/pubmed/19865573)
36. [Georgopoulos D, Bouros D. Fat embolism syndrome: clinical examination is still the preferable diagnostic method. Chest. 2003 Apr;123(4):982-3. PubMed PMID: 12684280. ](http://www.ncbi.nlm.nih.gov/pubmed/12684280)[View Abstract at](http://www.ncbi.nlm.nih.gov/pubmed/12684280)[ ](http://www.ncbi.nlm.nih.gov/pubmed/12684280)[PubMed](http://www.ncbi.nlm.nih.gov/pubmed/12684280)
37. [Kosova E, Bergmark B, Piazza G. Fat embolism syndrome. Circulation. 2015 Jan 20;131(3):317-20. doi: 10.1161/CIRCULATIONAHA.114.010835. PubMed PMID: 25601951. ](http://www.ncbi.nlm.nih.gov/pubmed/25601951)[View Abstract at ](http://www.ncbi.nlm.nih.gov/pubmed/25601951)[PubMed](http://www.ncbi.nlm.nih.gov/pubmed/25601951)
38. [Martin R, Leighton RK, Petrie D, Ikejiani C, Smyth B. Effect of proximal and distal venting during intramedullary nailing. Clin Orthop Relat Res. 1996 Nov;(332):80-9. PubMed PMID: 8913148. ](http://www.ncbi.nlm.nih.gov/pubmed/8913148)[View](http://www.ncbi.nlm.nih.gov/pubmed/8913148)[ ](http://www.ncbi.nlm.nih.gov/pubmed/8913148)[Abstract at PubMed](http://www.ncbi.nlm.nih.gov/pubmed/8913148)
QUESTION 70
of 100
Figures 71a through 71d are the radiographs, MR images, and biopsy specimen of a 15-year-old boy with a several-month history of right hip pain with no history of injury. This condition is associated with increased activity of which gene product?




Figures 71a through 71d are the radiographs, MR images, and biopsy specimen of a 15-year-old boy with a several-month history of right hip pain with no history of injury. This condition is associated with increased activity of which gene product?




1
FGFR3
2
Ga stimulatory protein
3
COMP
4
EXT-1
Fibrous dysplasia is a common benign skeletal lesion that may involve 1 bone (monostotic) or multiple bones (polyostotic) and occurs throughout the skeleton with a predilection for the long bones. The radiographic features of fibrous dysplasia typically illustrate a grayish “ground-glass” pattern that is similar to the density of cancellous bone. The key histologic features of fibrous dysplasia are trabeculae of immature bone, with no osteoblastic rimming, contained within a bland fibrous stroma of dysplastic spindle-shaped cells without any cellular features of malignancy. The etiology of fibrous dysplasia has been linked to an activating mutation in the gene that encodes the a subunit of stimulatory G protein located at 20q13.2-13.3. This leads to a constitutive activation of adenylate cyclase and increased cyclic adenosine monophosphate formation. FGFR3 mutations are associated with achondroplasia. COMP mutations are associated with pseudoachondroplasia and multiple-epiphyseal dysplasia. EXT-1 mutations are associated with multiple hereditary exostosis.
RECOMMENDED READINGS
39. [DiCaprio MR, Enneking WF. Fibrous dysplasia. Pathophysiology, evaluation, and treatment. J Bone Joint Surg Am. 2005 Aug;87(8):1848-64. Review. PubMed PMID: 16085630. ](http://www.ncbi.nlm.nih.gov/pubmed/16085630)[View Abstract at](http://www.ncbi.nlm.nih.gov/pubmed/16085630)[ ](http://www.ncbi.nlm.nih.gov/pubmed/16085630)[PubMed](http://www.ncbi.nlm.nih.gov/pubmed/16085630)
40. [Chapurlat RD, Orcel P. Fibrous dysplasia of bone and McCune-Albright syndrome. Best Pract Res Clin Rheumatol. 2008 Mar;22(1):55-69. doi: 10.1016/j.berh.2007.11.004. Review. PubMed PMID: 18328981. ](http://www.ncbi.nlm.nih.gov/pubmed/18328981)[View Abstract at PubMed](http://www.ncbi.nlm.nih.gov/pubmed/18328981)
41. Ippolito E, Valentini MB, Lala R, De Maio F, Sorge R, Farsetti P. Changing Pattern of Femoral Deformity During Growth in Polyostotic Fibrous Dysplasia of the Bone: An Analysis of 46 Cases. J Pediatr Orthop. 2016 Jul-Aug;36(5):488-93. doi: 10.1097/BPO.0000000000000473. PubMed PMID:
[25887818/. ](http://www.ncbi.nlm.nih.gov/pubmed/25887818)[View Abstract at PubMed](http://www.ncbi.nlm.nih.gov/pubmed/25887818)
42. [Leet AI, Collins MT. Current approach to fibrous dysplasia of bone and McCune-Albright syndrome. J Child Orthop. 2007 Mar;1(1):3-17. doi: 10.1007/s11832-007-0006-8. Epub 2007 Feb 23. PubMed PMID: 19308500. ](http://www.ncbi.nlm.nih.gov/pubmed/19308500)[View Abstract at PubMed](http://www.ncbi.nlm.nih.gov/pubmed/19308500)
RECOMMENDED READINGS
39. [DiCaprio MR, Enneking WF. Fibrous dysplasia. Pathophysiology, evaluation, and treatment. J Bone Joint Surg Am. 2005 Aug;87(8):1848-64. Review. PubMed PMID: 16085630. ](http://www.ncbi.nlm.nih.gov/pubmed/16085630)[View Abstract at](http://www.ncbi.nlm.nih.gov/pubmed/16085630)[ ](http://www.ncbi.nlm.nih.gov/pubmed/16085630)[PubMed](http://www.ncbi.nlm.nih.gov/pubmed/16085630)
40. [Chapurlat RD, Orcel P. Fibrous dysplasia of bone and McCune-Albright syndrome. Best Pract Res Clin Rheumatol. 2008 Mar;22(1):55-69. doi: 10.1016/j.berh.2007.11.004. Review. PubMed PMID: 18328981. ](http://www.ncbi.nlm.nih.gov/pubmed/18328981)[View Abstract at PubMed](http://www.ncbi.nlm.nih.gov/pubmed/18328981)
41. Ippolito E, Valentini MB, Lala R, De Maio F, Sorge R, Farsetti P. Changing Pattern of Femoral Deformity During Growth in Polyostotic Fibrous Dysplasia of the Bone: An Analysis of 46 Cases. J Pediatr Orthop. 2016 Jul-Aug;36(5):488-93. doi: 10.1097/BPO.0000000000000473. PubMed PMID:
[25887818/. ](http://www.ncbi.nlm.nih.gov/pubmed/25887818)[View Abstract at PubMed](http://www.ncbi.nlm.nih.gov/pubmed/25887818)
42. [Leet AI, Collins MT. Current approach to fibrous dysplasia of bone and McCune-Albright syndrome. J Child Orthop. 2007 Mar;1(1):3-17. doi: 10.1007/s11832-007-0006-8. Epub 2007 Feb 23. PubMed PMID: 19308500. ](http://www.ncbi.nlm.nih.gov/pubmed/19308500)[View Abstract at PubMed](http://www.ncbi.nlm.nih.gov/pubmed/19308500)
QUESTION 71
of 100
Figures 72a through 72d are the radiograph, MR images, and biopsy specimen of a 42-year-old man with an insidious onset of left hip pain. Further imaging reveals no other lesions. What is the most appropriate initial treatment?




Figures 72a through 72d are the radiograph, MR images, and biopsy specimen of a 42-year-old man with an insidious onset of left hip pain. Further imaging reveals no other lesions. What is the most appropriate initial treatment?




1
Bisphosphonate or denosumab and observation with cementoplasty for refractory pain
2
Chemotherapy and wide surgical resection
3
Wide surgical resection alone
4
Extended intralesional curettage and grafting
This patient has a localized pelvic chondrosarcoma. Treatment is wide surgical resection. There is no defined role for chemotherapy or radiotherapy in the setting of conventional chondrosarcoma. Additionally, while intralesional treatment may be used for select low-grade extremity chondrosarcomas, it is not indicated for axial lesions. Treatment involving less than a wide surgical margin correlates with local recurrence.
RECOMMENDED READINGS
43. [Pring ME, Weber KL, Unni KK, Sim FH. Chondrosarcoma of the pelvis. A review of sixty-four cases. J Bone Joint Surg Am. 2001 Nov;83-A(11):1630-42. Review. PubMed PMID: 11701784. ](http://www.ncbi.nlm.nih.gov/pubmed/11701784)[View](http://www.ncbi.nlm.nih.gov/pubmed/11701784)[ ](http://www.ncbi.nlm.nih.gov/pubmed/11701784)[Abstract at PubMed](http://www.ncbi.nlm.nih.gov/pubmed/11701784)
44. [Mavrogenis AF, Angelini A, Drago G, Merlino B, Ruggieri P. Survival analysis of patients with chondrosarcomas of the pelvis. J Surg Oncol. 2013 Jul;108(1):19-27. doi: 10.1002/jso.23351. Epub 2013 May 16. PubMed PMID: 23681650.](http://www.ncbi.nlm.nih.gov/pubmed/23681650)[View Abstract at PubMed](http://www.ncbi.nlm.nih.gov/pubmed/23681650)
RECOMMENDED READINGS
43. [Pring ME, Weber KL, Unni KK, Sim FH. Chondrosarcoma of the pelvis. A review of sixty-four cases. J Bone Joint Surg Am. 2001 Nov;83-A(11):1630-42. Review. PubMed PMID: 11701784. ](http://www.ncbi.nlm.nih.gov/pubmed/11701784)[View](http://www.ncbi.nlm.nih.gov/pubmed/11701784)[ ](http://www.ncbi.nlm.nih.gov/pubmed/11701784)[Abstract at PubMed](http://www.ncbi.nlm.nih.gov/pubmed/11701784)
44. [Mavrogenis AF, Angelini A, Drago G, Merlino B, Ruggieri P. Survival analysis of patients with chondrosarcomas of the pelvis. J Surg Oncol. 2013 Jul;108(1):19-27. doi: 10.1002/jso.23351. Epub 2013 May 16. PubMed PMID: 23681650.](http://www.ncbi.nlm.nih.gov/pubmed/23681650)[View Abstract at PubMed](http://www.ncbi.nlm.nih.gov/pubmed/23681650)
QUESTION 72
of 100
Figures 73a through 73c are the radiographs of a 68-year-old woman with a pathologic left femur fracture. A clinical examination demonstrates a large soft-tissue mass at the fracture site. CT scans of the chest, abdomen, and pelvis reveal numerous enlarged lymph nodes. Frozen section analysis at open biopsy reveals relapsed lymphoma. What is the most appropriate treatment?



Figures 73a through 73c are the radiographs of a 68-year-old woman with a pathologic left femur fracture. A clinical examination demonstrates a large soft-tissue mass at the fracture site. CT scans of the chest, abdomen, and pelvis reveal numerous enlarged lymph nodes. Frozen section analysis at open biopsy reveals relapsed lymphoma. What is the most appropriate treatment?



1
Antegrade reconstruction nail
2
Antegrade reconstruction nail and distal femur plate fixation
3
Retrograde femoral nail
4
Retrograde femoral nail and proximal femur plate fixation
Retrograde femoral nail fixation is mechanically advantageous for this fracture because it permits fixation distal to that which can be achieved with an antegrade nail. Most modern retrograde nail systems permit placement of multiple distal interlock screws that can be locked in a fixed-angle construct. Lytic bone destruction extends to the femoral condyles, making antegrade femoral nail fixation comparatively unsuitable. Classic orthopaedic oncology principles advise fixation of the entire bone whenever feasible. Evidence indicates that new distant metastasis within a fixated femur is a rare event, and efforts to protect the “whole bone” may not be warranted, especially if they entail additional risk. This argument is stronger regarding lymphoma-associated fractures (vs the more common carcinoma-associated fractures) because chemotherapy and radiation may be used to treat lymphoma with curative rather than palliative intent. Combined plate and nail fixation is not preferred in this scenario. Plate fixation alone or augmented with cement is a viable option
for this this fracture; however, the presence of a large soft tissue would likely necessitate extensive tumor debulking to appropriately place the plate.
RECOMMENDED READINGS
45. [Scholl BM, Jaffe KA. Oncologic uses of the retrograde femoral nail. Clin Orthop Relat Res. 2002 Jan;(394):219-26. PubMed PMID: 11795737.](http://www.ncbi.nlm.nih.gov/pubmed/11795737)[View Abstract at PubMed](http://www.ncbi.nlm.nih.gov/pubmed/11795737)
46. [Alvi HM, Damron TA. Prophylactic stabilization for bone metastases, myeloma, or lymphoma: do we need to protect the entire bone? Clin Orthop Relat Res. 2013 Mar;471(3):706-14. doi: 10.1007/s11999-012-2656-1. Epub 2012 Oct 27. PubMed PMID: 23104043.](http://www.ncbi.nlm.nih.gov/pubmed/23104043)[View Abstract at PubMed](http://www.ncbi.nlm.nih.gov/pubmed/23104043)
47. [Xing Z, Moon BS, Satcher RL, Lin PP, Lewis VO. A long femoral stem is not always required in hip arthroplasty for patients with proximal femur metastases. Clin Orthop Relat Res. 2013 May;471(5):1622-7. doi: 10.1007/s11999-013-2790-4. Epub 2013 Jan 30. ](http://www.ncbi.nlm.nih.gov/pubmed/23361930)[View Abstract at PubMed](http://www.ncbi.nlm.nih.gov/pubmed/23361930)
for this this fracture; however, the presence of a large soft tissue would likely necessitate extensive tumor debulking to appropriately place the plate.
RECOMMENDED READINGS
45. [Scholl BM, Jaffe KA. Oncologic uses of the retrograde femoral nail. Clin Orthop Relat Res. 2002 Jan;(394):219-26. PubMed PMID: 11795737.](http://www.ncbi.nlm.nih.gov/pubmed/11795737)[View Abstract at PubMed](http://www.ncbi.nlm.nih.gov/pubmed/11795737)
46. [Alvi HM, Damron TA. Prophylactic stabilization for bone metastases, myeloma, or lymphoma: do we need to protect the entire bone? Clin Orthop Relat Res. 2013 Mar;471(3):706-14. doi: 10.1007/s11999-012-2656-1. Epub 2012 Oct 27. PubMed PMID: 23104043.](http://www.ncbi.nlm.nih.gov/pubmed/23104043)[View Abstract at PubMed](http://www.ncbi.nlm.nih.gov/pubmed/23104043)
47. [Xing Z, Moon BS, Satcher RL, Lin PP, Lewis VO. A long femoral stem is not always required in hip arthroplasty for patients with proximal femur metastases. Clin Orthop Relat Res. 2013 May;471(5):1622-7. doi: 10.1007/s11999-013-2790-4. Epub 2013 Jan 30. ](http://www.ncbi.nlm.nih.gov/pubmed/23361930)[View Abstract at PubMed](http://www.ncbi.nlm.nih.gov/pubmed/23361930)
QUESTION 73
of 100
Survival estimation in guiding surgical decision-making in metastatic spine disease includes scores that include
Survival estimation in guiding surgical decision-making in metastatic spine disease includes scores that include
1
visceral metastases, multiple bone metastases, and tumor types with poorer prognosis.
2
body mass index, lower hemoglobin levels, older age, and visceral metastases.
3
peripheral vascular disease, diabetes, and visceral metastases.
4
disease confined to only adjacent vertebrae.
The modified Bauer and 6 other scoring systems have been used as accurate measures with which to establish the prognosis of metastatic spine disease. The modified Bauer scoring system assigns 1 point for no visceral metastases; 1 point if the diagnosis is not lung cancer; 1 point if the primary tumor is breast, kidney, lymphoma, or multiple myeloma; and 1 point if the tumor is a solitary skeletal metastasis. If the score totals 0 to 1, the recommendation is supportive care and no surgery. If the prognostic score is 2, short-term palliative surgery with a dorsal approach is performed. If the score is 3 to 4, middle-term local control with both ventral and dorsal approaches is suggested. The decision for or against surgery should not be based alone on any prognostic score but should take symptoms and neurological compromise into account.
RECOMMENDED READINGS
48. Arana E, Kovacs FM, Royuela A, Asenjo B, Pérez-Ramírez U, Zamora J; Spanish Back Pain Research Network Task Force for the improvement of inter-disciplinary management of spinal metastasis. Agreement in the assessment of metastatic spine disease using scoring systems. Radiother Oncol. 2015 Apr;115(1):135-40. doi: 10.1016/j.radonc.2015.03.016. Epub 2015 Apr 10. PubMed PMID: 25869337.
[View Abstract at PubMed](http://www.ncbi.nlm.nih.gov/pubmed/25869337)
49. Janssen SJ, van der Heijden AS, van Dijke M, Ready JE, Raskin KA, Ferrone ML, Hornicek FJ, Schwab JH. 2015 Marshall Urist Young Investigator Award: Prognostication in Patients With Long Bone Metastases: Does a Boosting Algorithm Improve Survival Estimates? Clin Orthop Relat Res. 2015 Oct;473(10):3112-21. doi: 10.1007/s11999-015-4446-z. Epub 2015 Jul 9. PubMed PMID: 26155769.
[View Abstract at PubMed](http://www.ncbi.nlm.nih.gov/pubmed/26155769)
50. Leithner A, Radl R, Gruber G, Hochegger M, Leithner K, Welkerling H, Rehak P, Windhager R. Predictive value of seven preoperative prognostic scoring systems for spinal metastases. Eur Spine J. 2008 Nov;17(11):1488-95. doi: 10.1007/s00586-008-0763-1. Epub 2008 Sep 12. PubMed PMID:
[18787846.](http://www.ncbi.nlm.nih.gov/pubmed/18787846)[View Abstract at PubMed](http://www.ncbi.nlm.nih.gov/pubmed/18787846)
RECOMMENDED READINGS
48. Arana E, Kovacs FM, Royuela A, Asenjo B, Pérez-Ramírez U, Zamora J; Spanish Back Pain Research Network Task Force for the improvement of inter-disciplinary management of spinal metastasis. Agreement in the assessment of metastatic spine disease using scoring systems. Radiother Oncol. 2015 Apr;115(1):135-40. doi: 10.1016/j.radonc.2015.03.016. Epub 2015 Apr 10. PubMed PMID: 25869337.
[View Abstract at PubMed](http://www.ncbi.nlm.nih.gov/pubmed/25869337)
49. Janssen SJ, van der Heijden AS, van Dijke M, Ready JE, Raskin KA, Ferrone ML, Hornicek FJ, Schwab JH. 2015 Marshall Urist Young Investigator Award: Prognostication in Patients With Long Bone Metastases: Does a Boosting Algorithm Improve Survival Estimates? Clin Orthop Relat Res. 2015 Oct;473(10):3112-21. doi: 10.1007/s11999-015-4446-z. Epub 2015 Jul 9. PubMed PMID: 26155769.
[View Abstract at PubMed](http://www.ncbi.nlm.nih.gov/pubmed/26155769)
50. Leithner A, Radl R, Gruber G, Hochegger M, Leithner K, Welkerling H, Rehak P, Windhager R. Predictive value of seven preoperative prognostic scoring systems for spinal metastases. Eur Spine J. 2008 Nov;17(11):1488-95. doi: 10.1007/s00586-008-0763-1. Epub 2008 Sep 12. PubMed PMID:
[18787846.](http://www.ncbi.nlm.nih.gov/pubmed/18787846)[View Abstract at PubMed](http://www.ncbi.nlm.nih.gov/pubmed/18787846)
QUESTION 74
of 100
A 52-year-old woman with a medical history that includes type 1 diabetes mellitus and rheumatoid arthritis has a painless right thigh mass that increased in size during the preceding year. Ultrasound was “consistent with lipoma,” and the patient underwent uneventful resection. Final pathology revealed high-grade undifferentiated sarcoma. Figures 75a and 75b are the clinical photograph and postresection MR image. The treatment rendered prior to referral to a sarcoma center most likely will result in increased


A 52-year-old woman with a medical history that includes type 1 diabetes mellitus and rheumatoid arthritis has a painless right thigh mass that increased in size during the preceding year. Ultrasound was “consistent with lipoma,” and the patient underwent uneventful resection. Final pathology revealed high-grade undifferentiated sarcoma. Figures 75a and 75b are the clinical photograph and postresection MR image. The treatment rendered prior to referral to a sarcoma center most likely will result in increased


1
likelihood for amputation.
2
likelihood for flap coverage.
3
overall mortality.
4
need for radiation therapy.
This patient had an unplanned resection of a high-grade soft-tissue sarcoma. The MR image shows that the unplanned resection extended deep to the fascia. Errors in this case include failure to obtain cross-sectional imaging of a tumor deep to the fascia prior to resection and use of a transverse incision. Flap coverage for unplanned soft-tissue sarcoma resection can increase the complexity of soft-tissue reconstruction. Radiation therapy would have been indicated for a high-grade soft-
tissue sarcoma deep to the fascia regardless of the biopsy technique. Overall, mortality does not correlate with errors in biopsy technique. Although many studies demonstrate increased local recurrence risk is associated with unplanned resection, amputation is not indicated in most cases. Radiation therapy and wide re-resection with salvage of the involved limb is the treatment of choice.
RECOMMENDED READINGS
51. [Jones DA, Shideman C, Yuan J, Dusenbery K, Carlos Manivel J, Ogilvie C, Clohisy DR, Cheng EY, Shanley R, Chinsoo Cho L. Management of Unplanned Excision for Soft-Tissue Sarcoma With Preoperative Radiotherapy Followed by Definitive Resection. Am J Clin Oncol. 2014 May 29. [Epub ahead of print] PubMed PMID: 24879470.](http://www.ncbi.nlm.nih.gov/pubmed/24879470)[View Abstract at PubMed](http://www.ncbi.nlm.nih.gov/pubmed/24879470)
52. [Pretell-Mazzini J, Barton MD Jr, Conway SA, Temple HT. Unplanned excision of soft-tissue sarcomas: current concepts for management and prognosis. J Bone Joint Surg Am. 2015 Apr 1;97(7):597-603. doi: 10.2106/JBJS.N.00649. Review. PubMed PMID: 25834085.](http://www.ncbi.nlm.nih.gov/pubmed/25834085)[View Abstract at PubMed](http://www.ncbi.nlm.nih.gov/pubmed/25834085)
53. [Qureshi YA, Huddy JR, Miller JD, Strauss DC, Thomas JM, Hayes AJ. Unplanned excision of soft tissue sarcoma results in increased rates of local recurrence despite full further oncological treatment. Ann Surg Oncol. 2012 Mar;19(3):871-7. doi: 10.1245/s10434-011-1876-z. Epub 2011 Jul 27. PubMed PMID: 21792512.](http://www.ncbi.nlm.nih.gov/pubmed/21792512)[View Abstract at PubMed](http://www.ncbi.nlm.nih.gov/pubmed/21792512)
tissue sarcoma deep to the fascia regardless of the biopsy technique. Overall, mortality does not correlate with errors in biopsy technique. Although many studies demonstrate increased local recurrence risk is associated with unplanned resection, amputation is not indicated in most cases. Radiation therapy and wide re-resection with salvage of the involved limb is the treatment of choice.
RECOMMENDED READINGS
51. [Jones DA, Shideman C, Yuan J, Dusenbery K, Carlos Manivel J, Ogilvie C, Clohisy DR, Cheng EY, Shanley R, Chinsoo Cho L. Management of Unplanned Excision for Soft-Tissue Sarcoma With Preoperative Radiotherapy Followed by Definitive Resection. Am J Clin Oncol. 2014 May 29. [Epub ahead of print] PubMed PMID: 24879470.](http://www.ncbi.nlm.nih.gov/pubmed/24879470)[View Abstract at PubMed](http://www.ncbi.nlm.nih.gov/pubmed/24879470)
52. [Pretell-Mazzini J, Barton MD Jr, Conway SA, Temple HT. Unplanned excision of soft-tissue sarcomas: current concepts for management and prognosis. J Bone Joint Surg Am. 2015 Apr 1;97(7):597-603. doi: 10.2106/JBJS.N.00649. Review. PubMed PMID: 25834085.](http://www.ncbi.nlm.nih.gov/pubmed/25834085)[View Abstract at PubMed](http://www.ncbi.nlm.nih.gov/pubmed/25834085)
53. [Qureshi YA, Huddy JR, Miller JD, Strauss DC, Thomas JM, Hayes AJ. Unplanned excision of soft tissue sarcoma results in increased rates of local recurrence despite full further oncological treatment. Ann Surg Oncol. 2012 Mar;19(3):871-7. doi: 10.1245/s10434-011-1876-z. Epub 2011 Jul 27. PubMed PMID: 21792512.](http://www.ncbi.nlm.nih.gov/pubmed/21792512)[View Abstract at PubMed](http://www.ncbi.nlm.nih.gov/pubmed/21792512)
QUESTION 75
of 100
A 16-year-old boy with a high-grade conventional osteosarcoma of the right proximal tibia has completed neoadjuvant chemotherapy. A restaging radiograph and MR image are shown in Figures 76a and 76b. Wide resection with limb salvage is planned. Which muscle will provide the primary protective margin for the tibial nerve and popliteal vessels?


A 16-year-old boy with a high-grade conventional osteosarcoma of the right proximal tibia has completed neoadjuvant chemotherapy. A restaging radiograph and MR image are shown in Figures 76a and 76b. Wide resection with limb salvage is planned. Which muscle will provide the primary protective margin for the tibial nerve and popliteal vessels?


1
Soleus
2
Popliteus
3
Medial gastrocnemius
4
Lateral gastrocnemius
The popliteus muscle originates from the posterior aspect of the proximal tibia and serves as the primary barrier to tumor encroachment upon the tibial nerve and popliteal vessels. The medial and lateral heads of the gastrocnemius lie superficial to the neurovascular bundle. A portion of the soleus originates from the lateral proximal tibia, forming part of the soleal arch through which the neurovascular bundle passes; however, the majority of the soleus is superficial to the neurovascular structures.
RECOMMENDED READINGS
54. [Hudson TM, Springfield DS, Schiebler M. Popliteus muscle as a barrier to tumor spread: computed tomography and angiography. J Comput Assist Tomogr. 1984 Jun;8(3):498-501. PubMed PMID: 6586755.](http://www.ncbi.nlm.nih.gov/pubmed/6586755)[View Abstract at PubMed](http://www.ncbi.nlm.nih.gov/pubmed/6586755)
55. [Jadhav SP, More SR, Riascos RF, Lemos DF, Swischuk LE. Comprehensive review of the anatomy, function, and imaging of the popliteus and associated pathologic conditions. Radiographics. 2014 Mar-Apr;34(2):496-513. doi: 10.1148/rg.342125082. Review. PubMed PMID: 24617694. ](http://www.ncbi.nlm.nih.gov/pubmed/24617694)[View Abstract at](http://www.ncbi.nlm.nih.gov/pubmed/24617694)[ ](http://www.ncbi.nlm.nih.gov/pubmed/24617694)[PubMed](http://www.ncbi.nlm.nih.gov/pubmed/24617694)
56. Cabanela M, Mendoza SA, Sanches-Sotelo J, translation eds. _Llusá M, Meri M, Ruano D. Surgical Atlas of the Musculoskeletal System_. Rosemont, IL: American Academy of Orthopaedic Surgeons; 2008.
RECOMMENDED READINGS
54. [Hudson TM, Springfield DS, Schiebler M. Popliteus muscle as a barrier to tumor spread: computed tomography and angiography. J Comput Assist Tomogr. 1984 Jun;8(3):498-501. PubMed PMID: 6586755.](http://www.ncbi.nlm.nih.gov/pubmed/6586755)[View Abstract at PubMed](http://www.ncbi.nlm.nih.gov/pubmed/6586755)
55. [Jadhav SP, More SR, Riascos RF, Lemos DF, Swischuk LE. Comprehensive review of the anatomy, function, and imaging of the popliteus and associated pathologic conditions. Radiographics. 2014 Mar-Apr;34(2):496-513. doi: 10.1148/rg.342125082. Review. PubMed PMID: 24617694. ](http://www.ncbi.nlm.nih.gov/pubmed/24617694)[View Abstract at](http://www.ncbi.nlm.nih.gov/pubmed/24617694)[ ](http://www.ncbi.nlm.nih.gov/pubmed/24617694)[PubMed](http://www.ncbi.nlm.nih.gov/pubmed/24617694)
56. Cabanela M, Mendoza SA, Sanches-Sotelo J, translation eds. _Llusá M, Meri M, Ruano D. Surgical Atlas of the Musculoskeletal System_. Rosemont, IL: American Academy of Orthopaedic Surgeons; 2008.
QUESTION 76
of 100
Figures 77a and 77b are the recent knee radiographs of a 53-year-old man whose history includes tobacco use and secondary polycythemia. He is now experiencing bilateral knee pain, knee swelling, and increasing discomfort with ambulation. All efforts at nonsurgical treatment have failed. What is the most reasonable next treatment option?







Figures 77a and 77b are the recent knee radiographs of a 53-year-old man whose history includes tobacco use and secondary polycythemia. He is now experiencing bilateral knee pain, knee swelling, and increasing discomfort with ambulation. All efforts at nonsurgical treatment have failed. What is the most reasonable next treatment option?







1
Core biopsy
2
Knee arthroplasty with postsurgical radiation therapy
3
Knee arthroplasty
4
Debridement with intravenous antibiotics
The radiographs reveal bilateral bone infarcts with subchondral collapse. The images are diagnostic for bone infarct. Other hematological conditions are associated with multiple bone infarcts, including sickle-cell disease, hemophilia, aplastic anemia, thalassemia, and acute lymphoblastic leukemia. Postsurgical radiation therapy is considered for Paget disease, but the radiographic appearance is not consistent with that diagnosis.
RECOMMENDED READINGS
57. [Lotke PA, Ecker ML. Osteonecrosis of the knee. J Bone Joint Surg Am. 1988 Mar;70(3):470-3. Review. PubMed PMID: 3279040.](http://www.ncbi.nlm.nih.gov/pubmed/3279040)[View Abstract at PubMed](http://www.ncbi.nlm.nih.gov/pubmed/3279040)
58. [Sorich MM, Cherian JJ, McElroy MJ, Banerjee S, Jones LC, Minniti CP, Mont MA. Osteonecrosis of the Hip in Hematologic Disease: A Review of Conditions and Treatment Options. J Long Term Eff Med Implants. 2015;25(4):253-68. PubMed PMID: 26852634.](http://www.ncbi.nlm.nih.gov/pubmed/26852634)[View Abstract at PubMed](http://www.ncbi.nlm.nih.gov/pubmed/26852634)
59. Karim AR, Cherian JJ, Jauregui JJ, Pierce T, Mont MA. Osteonecrosis of the knee: review. Ann Transl Med. 2015 Jan;3(1):6. doi: 10.3978/j.issn.2305-5839.2014.11.13. Review. PubMed PMID: 25705638.
[View Abstract at PubMed](http://www.ncbi.nlm.nih.gov/pubmed/25705638)
CLINICAL SITUATION FOR QUESTIONS 78 AND 79
Figures 78a through 78d are the radiograph, CT scans, and biopsy specimen of a 45-year-old man with a history of treatment for localized low-grade pelvic chondrosarcoma with limb salvage. He now has recurrent pain about his hip.
RECOMMENDED READINGS
57. [Lotke PA, Ecker ML. Osteonecrosis of the knee. J Bone Joint Surg Am. 1988 Mar;70(3):470-3. Review. PubMed PMID: 3279040.](http://www.ncbi.nlm.nih.gov/pubmed/3279040)[View Abstract at PubMed](http://www.ncbi.nlm.nih.gov/pubmed/3279040)
58. [Sorich MM, Cherian JJ, McElroy MJ, Banerjee S, Jones LC, Minniti CP, Mont MA. Osteonecrosis of the Hip in Hematologic Disease: A Review of Conditions and Treatment Options. J Long Term Eff Med Implants. 2015;25(4):253-68. PubMed PMID: 26852634.](http://www.ncbi.nlm.nih.gov/pubmed/26852634)[View Abstract at PubMed](http://www.ncbi.nlm.nih.gov/pubmed/26852634)
59. Karim AR, Cherian JJ, Jauregui JJ, Pierce T, Mont MA. Osteonecrosis of the knee: review. Ann Transl Med. 2015 Jan;3(1):6. doi: 10.3978/j.issn.2305-5839.2014.11.13. Review. PubMed PMID: 25705638.
[View Abstract at PubMed](http://www.ncbi.nlm.nih.gov/pubmed/25705638)
CLINICAL SITUATION FOR QUESTIONS 78 AND 79
Figures 78a through 78d are the radiograph, CT scans, and biopsy specimen of a 45-year-old man with a history of treatment for localized low-grade pelvic chondrosarcoma with limb salvage. He now has recurrent pain about his hip.
QUESTION 77
of 100
This patient should be told that
This patient should be told that
1
he has developed a prosthetic joint infection with purulence on biopsy.
2
he has developed a metal-on-metal pseudotumor reaction.
3
the tumor has recurred with transformation to a higher grade.
4
the tumor has recurred in a similar manner.
- the tumor has recurred with transformation to a higher grade._
QUESTION 78
of 100
Definitive treatment for this tumor likely will necessitate
Definitive treatment for this tumor likely will necessitate
1
irrigation and debridement with single vs 2-stage prosthetic exchange and i.v. antibiotics.
2
chemotherapy and radiotherapy.
3
hemipelvectomy.
4
revision to a metal-on-highly crosslinked polyethylene construct.
This patient has a recurrent tumor after limb salvage resection for low-grade chondrosarcoma. In addition to recurrence, the biopsy specimen shows transformation to a higher-grade chondrosarcoma (but not a dedifferentiated chondrosarcoma). There is no evidence of infection or a metal-on-metal–related pseudotumor.
Treatment that results in the highest likelihood of cure involves wide/radical resection of the area and frequent conversion to external hemipelvectomy. There is no defined role for chemotherapy or radiotherapy in the treatment of conventional chondrosarcoma, even when it is high grade.
RECOMMENDED READINGS
60. [Pring ME, Weber KL, Unni KK, Sim FH. Chondrosarcoma of the pelvis. A review of sixty-four cases. J Bone Joint Surg Am. 2001 Nov;83-A(11):1630-42. Review. PubMed PMID: 11701784. ](http://www.ncbi.nlm.nih.gov/pubmed/11701784)[View](http://www.ncbi.nlm.nih.gov/pubmed/11701784)[ ](http://www.ncbi.nlm.nih.gov/pubmed/11701784)[Abstract at PubMed](http://www.ncbi.nlm.nih.gov/pubmed/11701784)
61. [Mavrogenis AF, Angelini A, Drago G, Merlino B, Ruggieri P. Survival analysis of patients with chondrosarcomas of the pelvis. J Surg Oncol. 2013 Jul;108(1):19-27. doi: 10.1002/jso.23351. Epub 2013 May 16. PubMed PMID: 23681650. ](http://www.ncbi.nlm.nih.gov/pubmed/23681650)[View Abstract at PubMed](http://www.ncbi.nlm.nih.gov/pubmed/23681650)
62. [Weber KL, Pring ME, Sim FH. Treatment and outcome of recurrent pelvic chondrosarcoma. Clin Orthop Relat Res. 2002 Apr;(397):19-28. PubMed PMID: 11953591. ](http://www.ncbi.nlm.nih.gov/pubmed/11953591)[View Abstract at PubMed](http://www.ncbi.nlm.nih.gov/pubmed/11953591)
Treatment that results in the highest likelihood of cure involves wide/radical resection of the area and frequent conversion to external hemipelvectomy. There is no defined role for chemotherapy or radiotherapy in the treatment of conventional chondrosarcoma, even when it is high grade.
RECOMMENDED READINGS
60. [Pring ME, Weber KL, Unni KK, Sim FH. Chondrosarcoma of the pelvis. A review of sixty-four cases. J Bone Joint Surg Am. 2001 Nov;83-A(11):1630-42. Review. PubMed PMID: 11701784. ](http://www.ncbi.nlm.nih.gov/pubmed/11701784)[View](http://www.ncbi.nlm.nih.gov/pubmed/11701784)[ ](http://www.ncbi.nlm.nih.gov/pubmed/11701784)[Abstract at PubMed](http://www.ncbi.nlm.nih.gov/pubmed/11701784)
61. [Mavrogenis AF, Angelini A, Drago G, Merlino B, Ruggieri P. Survival analysis of patients with chondrosarcomas of the pelvis. J Surg Oncol. 2013 Jul;108(1):19-27. doi: 10.1002/jso.23351. Epub 2013 May 16. PubMed PMID: 23681650. ](http://www.ncbi.nlm.nih.gov/pubmed/23681650)[View Abstract at PubMed](http://www.ncbi.nlm.nih.gov/pubmed/23681650)
62. [Weber KL, Pring ME, Sim FH. Treatment and outcome of recurrent pelvic chondrosarcoma. Clin Orthop Relat Res. 2002 Apr;(397):19-28. PubMed PMID: 11953591. ](http://www.ncbi.nlm.nih.gov/pubmed/11953591)[View Abstract at PubMed](http://www.ncbi.nlm.nih.gov/pubmed/11953591)
QUESTION 79
of 100
Figure 80a is the radiograph of a 5-year-old girl who has experienced 8 weeks of shoulder pain that is mostly relieved with nonsteroidal anti-inflammatory drugs. Her MR images are shown in Figures 80b through 80f. Histology is shown in Figures 80g through 80i. The most likely diagnosis is










Figure 80a is the radiograph of a 5-year-old girl who has experienced 8 weeks of shoulder pain that is mostly relieved with nonsteroidal anti-inflammatory drugs. Her MR images are shown in Figures 80b through 80f. Histology is shown in Figures 80g through 80i. The most likely diagnosis is










1
aneurysmal bone cyst.
2
Ewing sarcoma.
3
giant-cell tumor.
4
osteoblastoma.
The combination of immature woven bone with osteoblastic rimming surrounded by a vascular fibrous bland stroma seen in Figure 80i and scattered giant cells within the lesion seen in Figure 80h should arouse suspicion for osteoblastoma. Osteoblastoma most often is diagnosed in adolescents and young adults, with 75% of patients younger than 25 years of age at diagnosis. Within tubular bones, osteoblastoma most often arises in the metadiaphyseal region, but it is more commonly seen in the spine within the posterior elements and flat bones. The lesion is well defined on radiographs, with lucent to mixed-lucent and blastic areas. MR imaging findings reveal low to intermediate–signal intensity on T1-weighted images and intermediate to high–signal intensity on T2-weighted images. Neoplastic woven bone can be seen in Figure 80g, and osteoclasts are shown in Figures 80h and 80i. Although the bone is expansile in appearance on radiologic studies, there are no large vascular lakes on histology to support the diagnosis of an aneurysmal bone cyst. Although there are areas of woven bone as in fibrous dysplasia, the appearance of osteoblastic rimming rules against this diagnosis. The location and histology of the tumor are inconsistent with giant-cell tumor of bone, the latter being a metaepiphyseal tumor histologically comprising giant cells within a background of stromal cells having nuclei identical to those of the giant cells. Ewing sarcoma would be a diagnostic consideration for a destructive scapular lesion in a 5-year-old, but the histology does not demonstrate the small, round blue-cell morphology of an Ewing sarcoma.
RECOMMENDED READINGS
63. Mirra JB. _Bone Tumors. Clinical, Radiologic, and Pathologic Correlations_. Philadelphia, PA: Lea & Febiger; 1989:391-418.
64. Nielsen GP, Rosenberg AE. _Diagnostic Pathology: Bone_. Manitoba, Canada: Amirsys; 2013:1-27.
RECOMMENDED READINGS
63. Mirra JB. _Bone Tumors. Clinical, Radiologic, and Pathologic Correlations_. Philadelphia, PA: Lea & Febiger; 1989:391-418.
64. Nielsen GP, Rosenberg AE. _Diagnostic Pathology: Bone_. Manitoba, Canada: Amirsys; 2013:1-27.
QUESTION 80
of 100
A 32-year-old man underwent distal femur resection and endoprosthetic replacement at age 15 for high-grade conventional osteosarcoma. He was treated with neoadjuvant and adjuvant cisplatin, doxorubicin, and methotrexate. There has been no evidence of recurrent osteosarcoma, and he has been otherwise active and well. He is scheduled to undergo exchange of the polyethylene liner and bushings in his prosthesis because of wear that has caused recurrent effusions and a sensation of instability. Which study is most important to assess his perioperative medical risk?
A 32-year-old man underwent distal femur resection and endoprosthetic replacement at age 15 for high-grade conventional osteosarcoma. He was treated with neoadjuvant and adjuvant cisplatin, doxorubicin, and methotrexate. There has been no evidence of recurrent osteosarcoma, and he has been otherwise active and well. He is scheduled to undergo exchange of the polyethylene liner and bushings in his prosthesis because of wear that has caused recurrent effusions and a sensation of instability. Which study is most important to assess his perioperative medical risk?
1
Pulmonary function tests
2
24-hour creatinine clearance
3
Hepatic transaminases
4
Echocardiogram
This patient was treated with doxorubicin, an anthracycline chemotherapy agent that causes cardiomyopathy in a dose-dependent fashion. Patients with osteosarcoma frequently undergo noninvasive cardiac testing with an echocardiogram or radionuclide angiography prior to anthracycline treatment. Cardiac toxicity is the typical cumulative dose-limiting effect of these agents. Posttreatment cardiac surveillance testing with an echocardiogram or radionuclide angiography is recommended for childhood cancer survivors treated with anthracyclines. Renal toxicity is a common adverse effect of cisplatin but usually manifests acutely. Similarly, methotrexate may cause acute hepatic toxicity that manifests acutely. In contrast, congestive heart failure attributable to doxorubicin cardiotoxicity frequently manifests late, with patients typically experiencing no or minimal symptoms until substantial cardiac dysfunction has occurred. Areflexia and peripheral neuropathy are also common side effects associated with these chemotherapeutic agents.
RECOMMENDED READINGS
65. Armenian SH, Hudson MM, Mulder RL, Chen MH, Constine LS, Dwyer M, Nathan PC, Tissing WJ, Shankar S, Sieswerda E, Skinner R, Steinberger J, van Dalen EC, van der Pal H, Wallace WH, Levitt G, Kremer LC; International Late Effects of Childhood Cancer Guideline Harmonization Group. Recommendations for cardiomyopathy surveillance for survivors of childhood cancer: a report from the International Late Effects of Childhood Cancer Guideline Harmonization Group. Lancet Oncol. 2015 Mar;16(3):e123-36. doi: 10.1016/S1470-2045(14)70409-7. Review. PubMed PMID: 25752563.
[View Abstract at PubMed](http://www.ncbi.nlm.nih.gov/pubmed/25752563)
66. [Longhi A, Ferrari S, Tamburini A, Luksch R, Fagioli F, Bacci G, Ferrari C. Late effects of chemotherapy and radiotherapy in osteosarcoma and Ewing sarcoma patients: the Italian Sarcoma Group Experience (1983-2006). Cancer. 2012 Oct 15;118(20):5050-9. doi: 10.1002/cncr.27493. Epub 2012 Mar 13. PubMed PMID: 22415578.](http://www.ncbi.nlm.nih.gov/pubmed/22415578)[View Abstract at PubMed](http://www.ncbi.nlm.nih.gov/pubmed/22415578)
RECOMMENDED READINGS
65. Armenian SH, Hudson MM, Mulder RL, Chen MH, Constine LS, Dwyer M, Nathan PC, Tissing WJ, Shankar S, Sieswerda E, Skinner R, Steinberger J, van Dalen EC, van der Pal H, Wallace WH, Levitt G, Kremer LC; International Late Effects of Childhood Cancer Guideline Harmonization Group. Recommendations for cardiomyopathy surveillance for survivors of childhood cancer: a report from the International Late Effects of Childhood Cancer Guideline Harmonization Group. Lancet Oncol. 2015 Mar;16(3):e123-36. doi: 10.1016/S1470-2045(14)70409-7. Review. PubMed PMID: 25752563.
[View Abstract at PubMed](http://www.ncbi.nlm.nih.gov/pubmed/25752563)
66. [Longhi A, Ferrari S, Tamburini A, Luksch R, Fagioli F, Bacci G, Ferrari C. Late effects of chemotherapy and radiotherapy in osteosarcoma and Ewing sarcoma patients: the Italian Sarcoma Group Experience (1983-2006). Cancer. 2012 Oct 15;118(20):5050-9. doi: 10.1002/cncr.27493. Epub 2012 Mar 13. PubMed PMID: 22415578.](http://www.ncbi.nlm.nih.gov/pubmed/22415578)[View Abstract at PubMed](http://www.ncbi.nlm.nih.gov/pubmed/22415578)
QUESTION 81
of 100
Figures 82a and 82b are the histopathology of an otherwise healthy 50-year-old man who had a growing mass marginally excised from his shoulder with local anesthetic and no presurgical imaging. The mass includes the deep fascia and muscle and is larger than 5 cm. Postsurgical MR imaging was obtained, and T2 and T1+C images are shown in Figures 82c and 82d. What is the best local treatment option?










Figures 82a and 82b are the histopathology of an otherwise healthy 50-year-old man who had a growing mass marginally excised from his shoulder with local anesthetic and no presurgical imaging. The mass includes the deep fascia and muscle and is larger than 5 cm. Postsurgical MR imaging was obtained, and T2 and T1+C images are shown in Figures 82c and 82d. What is the best local treatment option?










1
Observation
2
Radiation only
3
Chemotherapy only
4
Reexcision and radiation
The misdiagnosis of a soft-tissue mass is fairly common. However, in this scenario, the first indication that the presumed diagnosis was incorrect is supported by rapid growth over a short time period. Generally, lipomas and many other benign soft-tissue masses grow slowly over years rather than weeks or months. On MRI, a lipoma classically demonstrates homogenous high-signal intensity on a T1 sequence and fairly low-signal intensity on a T2 sequence. No imaging was done
before surgery, but a high-grade sarcoma generally shows a heterogenous signal on T1 and T2 sequences that is distinctly different than the pattern of a lipoma. The histopathology is consistent with a high-grade sarcoma; a spindle-cell tumor with hypercellularity, anaplasia, and pleomorphism. Mitotic figures are also noted, suggesting rapid turnover and growth. This is a high-grade sarcoma that is treated with wide surgical excision, and observation is not recommended. External beam radiation is often used as an adjuvant either before or after surgery to help decrease the local recurrence rate. Radiation alone would not be sufficient treatment. The use of chemotherapy is controversial. In the setting of a “whoops” or unintended resection of a high-grade soft-tissue sarcoma, reexcision of the tumor bed with radiation is generally indicated. The radiation is used to eliminate microscopic contamination. However, evidence supports surgery alone for superficial (subcutaneous) sarcomas.
RECOMMENDED READINGS
67. [Mankin HJ, Mankin CJ, Simon MA. The hazards of the biopsy, revisited. Members of the Musculoskeletal Tumor Society. J Bone Joint Surg Am. 1996 May;78(5):656-63. PubMed PMID: 8642021.](http://www.ncbi.nlm.nih.gov/pubmed/8642021)[View Abstract at PubMed](http://www.ncbi.nlm.nih.gov/pubmed/8642021)
68. Noria S, Davis A, Kandel R, Levesque J, O'Sullivan B, Wunder J, Bell R. Residual disease following unplanned excision of soft-tissue sarcoma of an extremity. J Bone Joint Surg Am. 1996 May;78(5):650-
[5/. PubMed PMID: 8642020.](http://www.ncbi.nlm.nih.gov/pubmed/8642020)[View Abstract at PubMed](http://www.ncbi.nlm.nih.gov/pubmed/8642020)
69. [Gibbs CP, Peabody TD, Mundt AJ, Montag AG, Simon MA. Oncological outcomes of operative treatment of subcutaneous soft-tissue sarcomas of the extremities. J Bone Joint Surg Am. 1997 Jun;79(6):888-97. PubMed PMID: 9199387.](http://www.ncbi.nlm.nih.gov/pubmed/9199387)[View Abstract at PubMed](http://www.ncbi.nlm.nih.gov/pubmed/9199387)
CLINICAL SITUATION FOR QUESTIONS 83 THROUGH 86
Figures 83a through 83d are the prefracture and postfracture radiographs of a previously healthy 19-year-old man who learned he had a high-grade conventional osteosarcoma of his left distal femur after undergoing open biopsy of a large left thigh mass. Staging study findings were negative for evidence of metastases, and he began neoadjuvant chemotherapy. Despite use of a hinged knee brace and weight bearing limitations with crutches, he experienced a sudden increase in pain while rising from bed between his first and second cycles of chemotherapy.
before surgery, but a high-grade sarcoma generally shows a heterogenous signal on T1 and T2 sequences that is distinctly different than the pattern of a lipoma. The histopathology is consistent with a high-grade sarcoma; a spindle-cell tumor with hypercellularity, anaplasia, and pleomorphism. Mitotic figures are also noted, suggesting rapid turnover and growth. This is a high-grade sarcoma that is treated with wide surgical excision, and observation is not recommended. External beam radiation is often used as an adjuvant either before or after surgery to help decrease the local recurrence rate. Radiation alone would not be sufficient treatment. The use of chemotherapy is controversial. In the setting of a “whoops” or unintended resection of a high-grade soft-tissue sarcoma, reexcision of the tumor bed with radiation is generally indicated. The radiation is used to eliminate microscopic contamination. However, evidence supports surgery alone for superficial (subcutaneous) sarcomas.
RECOMMENDED READINGS
67. [Mankin HJ, Mankin CJ, Simon MA. The hazards of the biopsy, revisited. Members of the Musculoskeletal Tumor Society. J Bone Joint Surg Am. 1996 May;78(5):656-63. PubMed PMID: 8642021.](http://www.ncbi.nlm.nih.gov/pubmed/8642021)[View Abstract at PubMed](http://www.ncbi.nlm.nih.gov/pubmed/8642021)
68. Noria S, Davis A, Kandel R, Levesque J, O'Sullivan B, Wunder J, Bell R. Residual disease following unplanned excision of soft-tissue sarcoma of an extremity. J Bone Joint Surg Am. 1996 May;78(5):650-
[5/. PubMed PMID: 8642020.](http://www.ncbi.nlm.nih.gov/pubmed/8642020)[View Abstract at PubMed](http://www.ncbi.nlm.nih.gov/pubmed/8642020)
69. [Gibbs CP, Peabody TD, Mundt AJ, Montag AG, Simon MA. Oncological outcomes of operative treatment of subcutaneous soft-tissue sarcomas of the extremities. J Bone Joint Surg Am. 1997 Jun;79(6):888-97. PubMed PMID: 9199387.](http://www.ncbi.nlm.nih.gov/pubmed/9199387)[View Abstract at PubMed](http://www.ncbi.nlm.nih.gov/pubmed/9199387)
CLINICAL SITUATION FOR QUESTIONS 83 THROUGH 86
Figures 83a through 83d are the prefracture and postfracture radiographs of a previously healthy 19-year-old man who learned he had a high-grade conventional osteosarcoma of his left distal femur after undergoing open biopsy of a large left thigh mass. Staging study findings were negative for evidence of metastases, and he began neoadjuvant chemotherapy. Despite use of a hinged knee brace and weight bearing limitations with crutches, he experienced a sudden increase in pain while rising from bed between his first and second cycles of chemotherapy.
QUESTION 82
of 100
The optimal initial treatment of this pathologic fracture is
The optimal initial treatment of this pathologic fracture is
1
spanning external fixation with continuation of neoadjuvant chemotherapy.
2
above-knee amputation with postsurgical adjuvant chemotherapy determined by the histologic findings from the specimen.
3
cast immobilization of the fracture with continuation of neoadjuvant chemotherapy.
4
immediate limb-sparing resection and endoprosthetic reconstruction with adjuvant chemotherapy determined by histologic findings from the specimen.
- cast immobilization of the fracture with continuation of neoadjuvant chemotherapy._
QUESTION 83
of 100
A series of axial T1-weighted MR images is shown in Figure 84. The postfracture MRI reveals tissue contamination by fracture hematoma. Based upon the MRI findings, which aspect of limb-sparing resection and reconstruction will be most challenging?
A series of axial T1-weighted MR images is shown in Figure 84. The postfracture MRI reveals tissue contamination by fracture hematoma. Based upon the MRI findings, which aspect of limb-sparing resection and reconstruction will be most challenging?
1
Preserving sciatic, tibial, and common peroneal nerve function
2
Obtaining adequate fixation of the distal femur component
3
Soft-tissue coverage of the endoprosthesis
4
En bloc extra-articular resection of the knee joint
- En bloc extra-articular resection of the knee joint_
QUESTION 84
of 100
The patient ultimately undergoes rotationplasty. What is the most likely etiology of early limb loss after rotationplasty for sarcoma?
The patient ultimately undergoes rotationplasty. What is the most likely etiology of early limb loss after rotationplasty for sarcoma?
1
Vascular compromise
2
Wound infection
3
Local recurrence
4
Fixation failure
- Vascular compromise_
QUESTION 85
of 100
When compared to patients who undergo endoprosthetic reconstruction, patients who undergo rotationplasty are more likely to
When compared to patients who undergo endoprosthetic reconstruction, patients who undergo rotationplasty are more likely to
1
have difficulty obtaining gainful employment.
2
participate in high-impact exercise and sports.
3
require revision surgery at some point in their lifetime.
4
experience problems with psychosocial adjustment.
Debate exists regarding the prognostic significance of pathologic fractures with respect to both overall survival and local recurrence, with most older studies indicating that fracture increases these risks and more recent research suggesting that risks are not increased as much as previously believed. This patient’s fracture is minimally displaced and amenable to cast immobilization. Healing of osteosarcoma pathologic femur fractures treated with casting and neoadjuvant chemotherapy has been well documented. Acute amputation was historically the standard treatment and remains an option for markedly displaced fractures with severe contamination. However, this scenario remains amenable to limb salvage. Spanning external fixation is suboptimal because the femoral canal will be breached proximally, creating a potential site of infection or a fracture stress riser if a stemmed endoprosthesis is to be used. Immediate limb-sparing resection is not advised because there will be higher risk for contamination from the acute hematoma, which will likely resolve with casting and chemotherapy.
The MRI series reveals extensive contamination of the knee joint by fracture hematoma. Such contamination precludes the more commonly performed intra-articular resection. Extra-articular resection, although technically feasible, is more difficult and frequently less functional than intra-articular resection. The MRI reveals that the sciatic nerve and its branches are distant from the fracture hematoma and tumor. Femoral fixation is not challenging in this patient because the tumor is quite distal. Soft-tissue coverage should be adequate because no subcutaneous contamination is shown on MRI.
Rotationplasty is a reasonable alternative to extra-articular resection and amputation among adults. Only the major nerves need to be free of tumor because even contaminated vessels can be resected with subsequent anastomosis after rotation and shortening. Vascular compromise is the most common cause of early limb loss after rotationplasty because both anastomosed and rotated vessels are at risk for thrombosis. Local recurrence is typically a later complication. Wound infections and fixation failures may occur but rarely result in acute limb loss.
Patients who undergo rotationplasty function at a level comparable to those who undergo below-knee amputation. High-impact activities are not discouraged for patients who undergo rotationplasty because there are no concerns about prosthetic wear or loosening. Psychosocial and occupational impairment are not worse among patients who undergo rotationplasty vs other forms of reconstruction. Revision surgery is less common with rotationplasty because there are fewer late infections, and concerns about prosthetic wear and loosening are eliminated.
RECOMMENDED READINGS
70. Salunke AA, Chen Y, Tan JH, Chen X, Khin LW, Puhaindran ME. Does a pathological fracture affect the prognosis in patients with osteosarcoma of the extremities? a systematic review and meta-analysis.
Bone Joint J. 2014 Oct;96-B(10):1396-403. doi: 10.1302/0301-620X.96B10.34370. Review. PubMed
[PMID: 25274928 ](http://www.ncbi.nlm.nih.gov/pubmed/25274928)[View Abstract at PubMed](http://www.ncbi.nlm.nih.gov/pubmed/25274928)
71. [Scully SP, Ghert MA, Zurakowski D, Thompson RC, Gebhardt MC. Pathologic fracture in osteosarcoma : prognostic importance and treatment implications. J Bone Joint Surg Am. 2002 Jan;84-A(1):49-57. Erratum in: J Bone Joint Surg Am 2002 Apr;84-A(4):622. ](http://www.ncbi.nlm.nih.gov/pubmed/11792779)[View Abstract at PubMed](http://www.ncbi.nlm.nih.gov/pubmed/11792779)
72. [Zwolak P, Kühnel SP, Fuchs B. Extraarticular knee resection for sarcomas with preservation of the extensor mechanism: surgical technique and review of cases. Clin Orthop Relat Res. 2011 Jan;469(1):251-6. doi: 10.1007/s11999-010-1359-8. Epub 2010 Apr 24. ](http://www.ncbi.nlm.nih.gov/pubmed/20419485)[View Abstract at PubMed](http://www.ncbi.nlm.nih.gov/pubmed/20419485)
73. Sawamura C, Hornicek FJ, Gebhardt MC. Complications and risk factors for failure of rotationplasty: review of 25 patients. Clin Orthop Relat Res. 2008 Jun;466(6):1302-8. doi: 10.1007/s11999-008-0231-
[6/. Epub 2008 Apr 11. PubMed PMID: 18404295.](http://www.ncbi.nlm.nih.gov/pubmed/18404295)[View Abstract at PubMed](http://www.ncbi.nlm.nih.gov/pubmed/18404295)
74. [Agarwal M, Puri A, Anchan C, Shah M, Jambhekar N. Rotationplasty for bone tumors: is there still a role? Clin Orthop Relat Res. 2007 Jun;459:76-81. PubMed PMID: 17414168.](http://www.ncbi.nlm.nih.gov/pubmed/17414168)[View Abstract at ](http://www.ncbi.nlm.nih.gov/pubmed/17414168)[PubMed](http://www.ncbi.nlm.nih.gov/pubmed/17414168)
75. [Teall T, Barrera M, Barr R, Silva M, Greenberg M. Psychological resilience in adolescent and young adult survivors of lower extremity bone tumors. Pediatr Blood Cancer. 2013 Jul;60(7):1223-30. doi: 10.1002/pbc.24441. Epub 2012 Dec 19. PubMed PMID: 23255460.](http://www.ncbi.nlm.nih.gov/pubmed/23255460)[View Abstract at PubMed](http://www.ncbi.nlm.nih.gov/pubmed/23255460)
76. [Hillmann A, Weist R, Fromme A, Völker K, Rosenbaum D. Sports activities and endurance capacity of bone tumor patients after rotationplasty. Arch Phys Med Rehabil. 2007 Jul;88(7):885-90. PubMed PMID: 17601469. ](http://www.ncbi.nlm.nih.gov/pubmed/17601469)[View Abstract at PubMed](http://www.ncbi.nlm.nih.gov/pubmed/17601469)
The MRI series reveals extensive contamination of the knee joint by fracture hematoma. Such contamination precludes the more commonly performed intra-articular resection. Extra-articular resection, although technically feasible, is more difficult and frequently less functional than intra-articular resection. The MRI reveals that the sciatic nerve and its branches are distant from the fracture hematoma and tumor. Femoral fixation is not challenging in this patient because the tumor is quite distal. Soft-tissue coverage should be adequate because no subcutaneous contamination is shown on MRI.
Rotationplasty is a reasonable alternative to extra-articular resection and amputation among adults. Only the major nerves need to be free of tumor because even contaminated vessels can be resected with subsequent anastomosis after rotation and shortening. Vascular compromise is the most common cause of early limb loss after rotationplasty because both anastomosed and rotated vessels are at risk for thrombosis. Local recurrence is typically a later complication. Wound infections and fixation failures may occur but rarely result in acute limb loss.
Patients who undergo rotationplasty function at a level comparable to those who undergo below-knee amputation. High-impact activities are not discouraged for patients who undergo rotationplasty because there are no concerns about prosthetic wear or loosening. Psychosocial and occupational impairment are not worse among patients who undergo rotationplasty vs other forms of reconstruction. Revision surgery is less common with rotationplasty because there are fewer late infections, and concerns about prosthetic wear and loosening are eliminated.
RECOMMENDED READINGS
70. Salunke AA, Chen Y, Tan JH, Chen X, Khin LW, Puhaindran ME. Does a pathological fracture affect the prognosis in patients with osteosarcoma of the extremities? a systematic review and meta-analysis.
Bone Joint J. 2014 Oct;96-B(10):1396-403. doi: 10.1302/0301-620X.96B10.34370. Review. PubMed
[PMID: 25274928 ](http://www.ncbi.nlm.nih.gov/pubmed/25274928)[View Abstract at PubMed](http://www.ncbi.nlm.nih.gov/pubmed/25274928)
71. [Scully SP, Ghert MA, Zurakowski D, Thompson RC, Gebhardt MC. Pathologic fracture in osteosarcoma : prognostic importance and treatment implications. J Bone Joint Surg Am. 2002 Jan;84-A(1):49-57. Erratum in: J Bone Joint Surg Am 2002 Apr;84-A(4):622. ](http://www.ncbi.nlm.nih.gov/pubmed/11792779)[View Abstract at PubMed](http://www.ncbi.nlm.nih.gov/pubmed/11792779)
72. [Zwolak P, Kühnel SP, Fuchs B. Extraarticular knee resection for sarcomas with preservation of the extensor mechanism: surgical technique and review of cases. Clin Orthop Relat Res. 2011 Jan;469(1):251-6. doi: 10.1007/s11999-010-1359-8. Epub 2010 Apr 24. ](http://www.ncbi.nlm.nih.gov/pubmed/20419485)[View Abstract at PubMed](http://www.ncbi.nlm.nih.gov/pubmed/20419485)
73. Sawamura C, Hornicek FJ, Gebhardt MC. Complications and risk factors for failure of rotationplasty: review of 25 patients. Clin Orthop Relat Res. 2008 Jun;466(6):1302-8. doi: 10.1007/s11999-008-0231-
[6/. Epub 2008 Apr 11. PubMed PMID: 18404295.](http://www.ncbi.nlm.nih.gov/pubmed/18404295)[View Abstract at PubMed](http://www.ncbi.nlm.nih.gov/pubmed/18404295)
74. [Agarwal M, Puri A, Anchan C, Shah M, Jambhekar N. Rotationplasty for bone tumors: is there still a role? Clin Orthop Relat Res. 2007 Jun;459:76-81. PubMed PMID: 17414168.](http://www.ncbi.nlm.nih.gov/pubmed/17414168)[View Abstract at ](http://www.ncbi.nlm.nih.gov/pubmed/17414168)[PubMed](http://www.ncbi.nlm.nih.gov/pubmed/17414168)
75. [Teall T, Barrera M, Barr R, Silva M, Greenberg M. Psychological resilience in adolescent and young adult survivors of lower extremity bone tumors. Pediatr Blood Cancer. 2013 Jul;60(7):1223-30. doi: 10.1002/pbc.24441. Epub 2012 Dec 19. PubMed PMID: 23255460.](http://www.ncbi.nlm.nih.gov/pubmed/23255460)[View Abstract at PubMed](http://www.ncbi.nlm.nih.gov/pubmed/23255460)
76. [Hillmann A, Weist R, Fromme A, Völker K, Rosenbaum D. Sports activities and endurance capacity of bone tumor patients after rotationplasty. Arch Phys Med Rehabil. 2007 Jul;88(7):885-90. PubMed PMID: 17601469. ](http://www.ncbi.nlm.nih.gov/pubmed/17601469)[View Abstract at PubMed](http://www.ncbi.nlm.nih.gov/pubmed/17601469)
QUESTION 86
of 100
Figures 87a through 87d are radiographs of both knees of a 75-year-old man who is experiencing bilateral knee pain and stiffness. The gross appearance of the lesions in the suprapatellar pouch is seen in Figure 87e. The histologic finding that would best determine this process is osteoarthritic in nature and not neoplastic is the absence of





Figures 87a through 87d are radiographs of both knees of a 75-year-old man who is experiencing bilateral knee pain and stiffness. The gross appearance of the lesions in the suprapatellar pouch is seen in Figure 87e. The histologic finding that would best determine this process is osteoarthritic in nature and not neoplastic is the absence of





1
chondrocyte cloning.
2
synovial metaplasia.
3
cords of eosinophilic cells in myxoid stroma.
4
multinucleated giant cells.
The radiographic appearance is typical for loose bodies caused by osteoarthritis. The process is bilateral, which is not characteristic of synovial chondromatosis. The characteristic histologic finding in synovial chondromatosis is synovial metaplasia, the cartilaginous change of the synovial membrane. Chondrocyte cloning is a finding in chondrosarcoma. Cords of eosinophilic cell in myxoid stroma are characteristic for extraskeletal chondrosarcoma.
Histologic evaluation is not necessary to rule out synovial chondromatosis because of the characteristic radiographic findings, although it is not unreasonable to document the specimens removed with a pathology consultation. In synovial chondromatosis, bone morphogenetic proteins are thought to be involved in the pathogenesis of the disease.
RECOMMENDED READINGS
77. Blitzer CM, Scarano KA. Arthroscopic Management of Synovial Osteochondromatosis of the Hip. Orthopedics. 2015 Jun;38(6):e536-8. doi: 10.3928/01477447-20150603-91. PubMed PMID:
[26091229.](http://www.ncbi.nlm.nih.gov/pubmed/26091229)[View Abstract at PubMed](http://www.ncbi.nlm.nih.gov/pubmed/26091229)
78. [Crotty JM, Monu JU, Pope TL Jr. Synovial osteochondromatosis. Radiol Clin North Am. 1996 Mar;34(2):327-42, xi. Review. PubMed PMID: 8633119.](http://www.ncbi.nlm.nih.gov/pubmed/8633119)[View Abstract at PubMed](http://www.ncbi.nlm.nih.gov/pubmed/8633119)
79. [Nakanishi S, Sakamoto K, Yoshitake H, Kino K, Amagasa T, Yamaguchi A. Bone morphogenetic proteins are involved in the pathobiology of synovial chondromatosis. Biochem Biophys Res Commun. 2009 Feb 20;379(4):914-9. doi: 10.1016/j.bbrc.2008.12.170. Epub 2009 Jan 10. Erratum in: Biochem Biophys Res Commun. 2009 Jun 19;384(1):134. Sskamoto, Kei [corrected to Sakamoto, Kei]. PubMed PMID: 19138670. ](http://www.ncbi.nlm.nih.gov/pubmed/19138670)[View Abstract at PubMed](http://www.ncbi.nlm.nih.gov/pubmed/19138670)
Histologic evaluation is not necessary to rule out synovial chondromatosis because of the characteristic radiographic findings, although it is not unreasonable to document the specimens removed with a pathology consultation. In synovial chondromatosis, bone morphogenetic proteins are thought to be involved in the pathogenesis of the disease.
RECOMMENDED READINGS
77. Blitzer CM, Scarano KA. Arthroscopic Management of Synovial Osteochondromatosis of the Hip. Orthopedics. 2015 Jun;38(6):e536-8. doi: 10.3928/01477447-20150603-91. PubMed PMID:
[26091229.](http://www.ncbi.nlm.nih.gov/pubmed/26091229)[View Abstract at PubMed](http://www.ncbi.nlm.nih.gov/pubmed/26091229)
78. [Crotty JM, Monu JU, Pope TL Jr. Synovial osteochondromatosis. Radiol Clin North Am. 1996 Mar;34(2):327-42, xi. Review. PubMed PMID: 8633119.](http://www.ncbi.nlm.nih.gov/pubmed/8633119)[View Abstract at PubMed](http://www.ncbi.nlm.nih.gov/pubmed/8633119)
79. [Nakanishi S, Sakamoto K, Yoshitake H, Kino K, Amagasa T, Yamaguchi A. Bone morphogenetic proteins are involved in the pathobiology of synovial chondromatosis. Biochem Biophys Res Commun. 2009 Feb 20;379(4):914-9. doi: 10.1016/j.bbrc.2008.12.170. Epub 2009 Jan 10. Erratum in: Biochem Biophys Res Commun. 2009 Jun 19;384(1):134. Sskamoto, Kei [corrected to Sakamoto, Kei]. PubMed PMID: 19138670. ](http://www.ncbi.nlm.nih.gov/pubmed/19138670)[View Abstract at PubMed](http://www.ncbi.nlm.nih.gov/pubmed/19138670)
QUESTION 87
of 100
Figures 88a through 88d are the radiographs and biopsy specimens of a 65-year-old woman with a history of breast cancer who has been experiencing 6 weeks of increasing left hip pain. She denies any injury. What is the most likely diagnosis?






Figures 88a through 88d are the radiographs and biopsy specimens of a 65-year-old woman with a history of breast cancer who has been experiencing 6 weeks of increasing left hip pain. She denies any injury. What is the most likely diagnosis?






1
Metastatic breast cancer
2
Myeloma
3
Fibrous dysplasia
4
Osteosarcoma
Radiographs reveal a destructive lesion. A differential diagnosis would include metastatic disease, myeloma, lymphoma, or primary sarcoma of bone. Histology shows sheets of plasma cells with eccentric nuclei, coarsely clumped nuclear chromatin, and a perinuclear halo. This pathology is consistent with myeloma. Metastatic disease would reveal nests of epithelia cells in a fibrous
background. Fibrous dysplasia would reveal irregular bony trabecular without rimming osteoblasts. Osteosarcoma would reveal malignant cells making osteoid.
RECOMMENDED READINGS
80. [Palumbo A, Anderson K. Multiple myeloma. N Engl J Med. 2011 Mar 17;364(11):1046-60. doi: 10.1056/NEJMra1011442. Review. PubMed PMID: 21410373. ](http://www.ncbi.nlm.nih.gov/pubmed/21410373)[View Abstract at PubMed](http://www.ncbi.nlm.nih.gov/pubmed/21410373)
81. Swerdlow S, Campo E, Harris N, Jaffe ES, Pileri SA, Stein H, Thiele J, Vardiman JW, eds. _WHO Classification of Tumors of Haematopoietic and Lymphoid Tissues_ , 4th ed. Lyon, France: IARC Press; 2008.
background. Fibrous dysplasia would reveal irregular bony trabecular without rimming osteoblasts. Osteosarcoma would reveal malignant cells making osteoid.
RECOMMENDED READINGS
80. [Palumbo A, Anderson K. Multiple myeloma. N Engl J Med. 2011 Mar 17;364(11):1046-60. doi: 10.1056/NEJMra1011442. Review. PubMed PMID: 21410373. ](http://www.ncbi.nlm.nih.gov/pubmed/21410373)[View Abstract at PubMed](http://www.ncbi.nlm.nih.gov/pubmed/21410373)
81. Swerdlow S, Campo E, Harris N, Jaffe ES, Pileri SA, Stein H, Thiele J, Vardiman JW, eds. _WHO Classification of Tumors of Haematopoietic and Lymphoid Tissues_ , 4th ed. Lyon, France: IARC Press; 2008.
QUESTION 88
of 100
Figures 89a through 89g are the radiographs, MR images, and biopsy specimen of a 32-year-old man who has chronic left thigh and knee pain and recent knee swelling with no specific trauma or injury. The pain is exacerbated with activity but is also present at rest and at night. What is the most appropriate treatment?












Figures 89a through 89g are the radiographs, MR images, and biopsy specimen of a 32-year-old man who has chronic left thigh and knee pain and recent knee swelling with no specific trauma or injury. The pain is exacerbated with activity but is also present at rest and at night. What is the most appropriate treatment?












1
Surgical wide resection and endoprosthetic reconstruction
2
Chemotherapy followed by wide surgical resection and reconstruction
3
Aggressive curettage with allograft placement
4
Aggressive debridement, antibiotic bead placement, and intravenous (IV) antibiotics
The radiographs show a lytic, destructive, poorly marginated femur lesion. MR imaging confirms the infiltrative nature of the lesion, a communication with the joint, and a substantial nonenhancing joint effusion. Biopsy confirms numerous polymorphonuclear neutrophils consistent with osteomyelitis with septic arthritis. The treatment of femur osteomyelitis with a septic knee includes aggressive debridement of all nonviable tissue, placement of antibiotic beads, and IV antibiotics. Surgical wide resection and endoprosthetic reconstruction would be considered only if the lesion were a low-grade malignancy. Aggressive curettage with allograft placement would be considered for benign tumors. Allograft placement is not appropriate in the setting of an infection. Chemotherapy followed by wide surgical resection and reconstruction is only appropriate for a high-grade malignancy.
RECOMMENDED READINGS
82. [Lew DP, Waldvogel FA. Osteomyelitis. Lancet. 2004 Jul 24-30;364(9431):369-79. Review. PubMed PMID: 15276398.](http://www.ncbi.nlm.nih.gov/pubmed/15276398)[View Abstract at PubMed](http://www.ncbi.nlm.nih.gov/pubmed/15276398)
83. [Tetsworth K, Cierny G 3rd. Osteomyelitis debridement techniques. Clin Orthop Relat Res. 1999 Mar;(360):87-96. Review. PubMed PMID: 10101313.](http://www.ncbi.nlm.nih.gov/pubmed/10101313)[View Abstract at PubMed](http://www.ncbi.nlm.nih.gov/pubmed/10101313)
84. [Karchevsky M, Schweitzer ME, Morrison WB, Parellada JA. MRI findings of septic arthritis and associated osteomyelitis in adults. AJR Am J Roentgenol. 2004 Jan;182(1):119-22. PubMed PMID: 14684523.](http://www.ncbi.nlm.nih.gov/pubmed/14684523)[View Abstract at PubMed](http://www.ncbi.nlm.nih.gov/pubmed/14684523)
CLINICAL SITUATION FOR QUESTIONS 90 AND 91
Figures 90a and 90b are the axial MR image and histology of a 27-year-old woman who has a firm lesion in the popliteal fossa. Figure 90c is the gross specimen after resection.
RECOMMENDED READINGS
82. [Lew DP, Waldvogel FA. Osteomyelitis. Lancet. 2004 Jul 24-30;364(9431):369-79. Review. PubMed PMID: 15276398.](http://www.ncbi.nlm.nih.gov/pubmed/15276398)[View Abstract at PubMed](http://www.ncbi.nlm.nih.gov/pubmed/15276398)
83. [Tetsworth K, Cierny G 3rd. Osteomyelitis debridement techniques. Clin Orthop Relat Res. 1999 Mar;(360):87-96. Review. PubMed PMID: 10101313.](http://www.ncbi.nlm.nih.gov/pubmed/10101313)[View Abstract at PubMed](http://www.ncbi.nlm.nih.gov/pubmed/10101313)
84. [Karchevsky M, Schweitzer ME, Morrison WB, Parellada JA. MRI findings of septic arthritis and associated osteomyelitis in adults. AJR Am J Roentgenol. 2004 Jan;182(1):119-22. PubMed PMID: 14684523.](http://www.ncbi.nlm.nih.gov/pubmed/14684523)[View Abstract at PubMed](http://www.ncbi.nlm.nih.gov/pubmed/14684523)
CLINICAL SITUATION FOR QUESTIONS 90 AND 91
Figures 90a and 90b are the axial MR image and histology of a 27-year-old woman who has a firm lesion in the popliteal fossa. Figure 90c is the gross specimen after resection.
QUESTION 89
of 100
What is the most likely diagnosis?
What is the most likely diagnosis?
1
Desmoid tumor
2
High-grade pleomorphic sarcoma
3
Synovial sarcoma
4
Extraskeletal Ewing sarcoma
- Desmoid tumor_
QUESTION 90
of 100
Immunohistochemical analysis of this lesion will be characterized by expression of
Immunohistochemical analysis of this lesion will be characterized by expression of
1
CD99.
2
epithelial membrane antigen.
3
estrogen receptor.
4
S100.
The imaging shows an infiltrative soft-tissue mass. Histology demonstrates a bland spindle-cell lesion without nuclear atypia consistent with desmoid tumor. Extraskeletal Ewing sarcoma would be expected to reveal more surrounding edema and small, round blue cells on histology. Synovial sarcoma would have a biphasic appearance consisting of spindle cells and plump epithelial cells arranged in glands or cords. Epithelial membrane antigen is often found in synovial sarcoma. Studies have demonstrated that desmoid tumors express estrogen receptors. As a result, tamoxifen has been 1 of the modalities used to treat this lesion.
RECOMMENDED READINGS
85. [Robbin MR, Murphey MD, Temple HT, Kransdorf MJ, Choi JJ. Imaging of musculoskeletal fibromatosis. Radiographics. 2001 May-Jun;21(3):585-600. Review. ](http://www.ncbi.nlm.nih.gov/pubmed/11353108)[View Abstract at PubMed](http://www.ncbi.nlm.nih.gov/pubmed/11353108)
86. [Deyrup AT, Tretiakova M, Montag AG. Estrogen receptor-beta expression in extraabdominal fibromatoses: an analysis of 40 cases. Cancer. 2006 Jan 1;106(1):208-13. ](http://www.ncbi.nlm.nih.gov/pubmed/16333857)[View Abstract at PubMed](http://www.ncbi.nlm.nih.gov/pubmed/16333857)
87. Molloy AP, Hutchinson B, O'Toole GC. Extra-abdominal desmoid tumours: a review of the literature. Sarcoma. 2012;2012:578052. doi: 10.1155/2012/578052. Epub 2012 Aug 16. PubMed PMID:
[22966217/. ](http://www.ncbi.nlm.nih.gov/pubmed/22966217)[View Abstract at PubMed](http://www.ncbi.nlm.nih.gov/pubmed/22966217)
88. [Hosalkar HS, Torbert JT, Fox EJ, Delaney TF, Aboulafia AJ, Lackman RD. Musculoskeletal desmoid tumors. J Am Acad Orthop Surg. 2008 Apr;16(4):188-98. Review. ](http://www.ncbi.nlm.nih.gov/pubmed/18390481)[View Abstract at PubMed](http://www.ncbi.nlm.nih.gov/pubmed/18390481)
RECOMMENDED READINGS
85. [Robbin MR, Murphey MD, Temple HT, Kransdorf MJ, Choi JJ. Imaging of musculoskeletal fibromatosis. Radiographics. 2001 May-Jun;21(3):585-600. Review. ](http://www.ncbi.nlm.nih.gov/pubmed/11353108)[View Abstract at PubMed](http://www.ncbi.nlm.nih.gov/pubmed/11353108)
86. [Deyrup AT, Tretiakova M, Montag AG. Estrogen receptor-beta expression in extraabdominal fibromatoses: an analysis of 40 cases. Cancer. 2006 Jan 1;106(1):208-13. ](http://www.ncbi.nlm.nih.gov/pubmed/16333857)[View Abstract at PubMed](http://www.ncbi.nlm.nih.gov/pubmed/16333857)
87. Molloy AP, Hutchinson B, O'Toole GC. Extra-abdominal desmoid tumours: a review of the literature. Sarcoma. 2012;2012:578052. doi: 10.1155/2012/578052. Epub 2012 Aug 16. PubMed PMID:
[22966217/. ](http://www.ncbi.nlm.nih.gov/pubmed/22966217)[View Abstract at PubMed](http://www.ncbi.nlm.nih.gov/pubmed/22966217)
88. [Hosalkar HS, Torbert JT, Fox EJ, Delaney TF, Aboulafia AJ, Lackman RD. Musculoskeletal desmoid tumors. J Am Acad Orthop Surg. 2008 Apr;16(4):188-98. Review. ](http://www.ncbi.nlm.nih.gov/pubmed/18390481)[View Abstract at PubMed](http://www.ncbi.nlm.nih.gov/pubmed/18390481)
QUESTION 91
of 100
Figures 92a and 92b are the reconstruction radiographs of a 16-year-old boy with a high-grade conventional osteosarcoma of his right proximal tibia. He has completed neoadjuvant
chemotherapy. Wide resection, endoprosthetic proximal tibia replacement, a medial gastrocnemius flap, and a split-thickness skin graft were performed. The preferred postsurgical knee rehabilitation regimen is


Figures 92a and 92b are the reconstruction radiographs of a 16-year-old boy with a high-grade conventional osteosarcoma of his right proximal tibia. He has completed neoadjuvant
chemotherapy. Wide resection, endoprosthetic proximal tibia replacement, a medial gastrocnemius flap, and a split-thickness skin graft were performed. The preferred postsurgical knee rehabilitation regimen is


1
therapist-directed passive and active assisted range of motion exercises from 0 to 90 degrees.
2
immobilization in full extension for 6 weeks with therapist-directed gait training and isometric exercises.
3
use of an immediate continuous passive motion machine set at 0 to 90 degrees followed by outpatient physical therapy.
4
use of a knee immobilizer for 2 weeks followed by home use of a continuous passive motion machine (set at 0 to 90 degrees).
This patient underwent resection of the patellar tendon insertion onto the proximal tibia. The residual tendon is sutured to the prosthesis with augmentation of the repair by the medial gastrocnemius flap. Immobilization for 6 weeks in full extension is preferred to permit healing of the tendon repair and prevent patella alta with associated extensor lag. Cast, splint, or brace are all acceptable options for the initial immobilization. Risk for knee stiffness with such immobilization is low because all of the distal knee ligamentous and capsular attachments are transected with resection. Two weeks of immobilization may be adequate for flap and skin graft healing, but this amount of time is inadequate for patellar tendon healing. Continuous passive motion vs therapist-
directed range of motion has not been rigorously compared for proximal tibia replacement. Responses 1 and 2 include early motion.
RECOMMENDED READINGS
89. [Eckardt JJ, Matthews JG 2nd, Eilber FR. Endoprosthetic reconstruction after bone tumor resections of the proximal tibia. Orthop Clin North Am. 1991 Jan;22(1):149-60. PubMed PMID: 1992431. ](http://www.ncbi.nlm.nih.gov/pubmed/1992431)[View](http://www.ncbi.nlm.nih.gov/pubmed/1992431)[ ](http://www.ncbi.nlm.nih.gov/pubmed/1992431)[Abstract at PubMed](http://www.ncbi.nlm.nih.gov/pubmed/1992431)
90. [Jentzsch T, Erschbamer M, Seeli F, Fuchs B. Extensor function after medial gastrocnemius flap reconstruction of the proximal tibia. Clin Orthop Relat Res. 2013 Jul;471(7):2333-9. doi: 10.1007/s11999-013-2851-8. Epub 2013 Feb 20. PubMed PMID: 23423620. ](http://www.ncbi.nlm.nih.gov/pubmed/23423620)[View Abstract at ](http://www.ncbi.nlm.nih.gov/pubmed/23423620)[PubMed](http://www.ncbi.nlm.nih.gov/pubmed/23423620)
91. [Mavrogenis AF, Pala E, Angelini A, Ferraro A, Ruggieri P. Proximal tibial resections and reconstructions: clinical outcome of 225 patients. J Surg Oncol. 2013 Mar;107(4):335-42. doi: 10.1002/jso.23216. Epub 2012 Jul 17. PubMed PMID: 22806768. ](http://www.ncbi.nlm.nih.gov/pubmed/22806768)[View Abstract at PubMed](http://www.ncbi.nlm.nih.gov/pubmed/22806768)
directed range of motion has not been rigorously compared for proximal tibia replacement. Responses 1 and 2 include early motion.
RECOMMENDED READINGS
89. [Eckardt JJ, Matthews JG 2nd, Eilber FR. Endoprosthetic reconstruction after bone tumor resections of the proximal tibia. Orthop Clin North Am. 1991 Jan;22(1):149-60. PubMed PMID: 1992431. ](http://www.ncbi.nlm.nih.gov/pubmed/1992431)[View](http://www.ncbi.nlm.nih.gov/pubmed/1992431)[ ](http://www.ncbi.nlm.nih.gov/pubmed/1992431)[Abstract at PubMed](http://www.ncbi.nlm.nih.gov/pubmed/1992431)
90. [Jentzsch T, Erschbamer M, Seeli F, Fuchs B. Extensor function after medial gastrocnemius flap reconstruction of the proximal tibia. Clin Orthop Relat Res. 2013 Jul;471(7):2333-9. doi: 10.1007/s11999-013-2851-8. Epub 2013 Feb 20. PubMed PMID: 23423620. ](http://www.ncbi.nlm.nih.gov/pubmed/23423620)[View Abstract at ](http://www.ncbi.nlm.nih.gov/pubmed/23423620)[PubMed](http://www.ncbi.nlm.nih.gov/pubmed/23423620)
91. [Mavrogenis AF, Pala E, Angelini A, Ferraro A, Ruggieri P. Proximal tibial resections and reconstructions: clinical outcome of 225 patients. J Surg Oncol. 2013 Mar;107(4):335-42. doi: 10.1002/jso.23216. Epub 2012 Jul 17. PubMed PMID: 22806768. ](http://www.ncbi.nlm.nih.gov/pubmed/22806768)[View Abstract at PubMed](http://www.ncbi.nlm.nih.gov/pubmed/22806768)
QUESTION 92
of 100
Figures 93a through 93f are radiographs, selected MR imaging sequences, and biopsy specimens of the left humerus of a 76-year-old woman who has experienced long-term left arm pain. She has received previous treatment for osteoarthritis of her left shoulder with nonsteroidal anti-inflammatory drugs and an intra-articular corticosteroid injection for her rotator cuff arthropathy. Recent staging studies show no evidence of metastatic disease. What is the most appropriate next treatment?






Figures 93a through 93f are radiographs, selected MR imaging sequences, and biopsy specimens of the left humerus of a 76-year-old woman who has experienced long-term left arm pain. She has received previous treatment for osteoarthritis of her left shoulder with nonsteroidal anti-inflammatory drugs and an intra-articular corticosteroid injection for her rotator cuff arthropathy. Recent staging studies show no evidence of metastatic disease. What is the most appropriate next treatment?






1
Neoadjuvant chemotherapy followed by wide resection
2
Presurgical radiation therapy followed by wide resection
3
Wide resection and endoprosthetic reconstruction
4
Systemic chemotherapy and local radiation
This patient’s radiographs, MR imaging, and histologic examination are diagnostic for low-grade chondrosarcoma, which is treated with surgery alone. In this patient, the tumor is entirely intramedullary. Both wide resection and extended intralesional curettage with intraoperative surgical adjuvant treatment are treatment options. Chemotherapy and radiation are not beneficial in the treatment of low-grade chondrosarcoma.
Endoprosthetic reconstruction using a reverse shoulder arthroplasty may be employed when the rotator cuff is deficient for older patients with neoplasms of the proximal humerus. Allograft-prosthetic composite reverse shoulder arthroplasty also has been used with early success.
RECOMMENDED READINGS
92. [Mermerkaya MU, Bekmez S, Karaaslan F, Danisman M, Kosemehmetoglu K, Gedikoglu G, Ayvaz M, Tokgozoglu AM. Intralesional curettage and cementation for low-grade chondrosarcoma of long bones: retrospective study and literature review. World J Surg Oncol. 2014 Nov 10;12:336. doi: 10.1186/1477-7819-12-336. Review. PubMed PMID: 25382793.](http://www.ncbi.nlm.nih.gov/pubmed/25382793)[View Abstract at PubMed](http://www.ncbi.nlm.nih.gov/pubmed/25382793)
93. [Di Giorgio L, Touloupakis G, Vitullo F, Sodano L, Mastantuono M, Villani C. Intralesional curettage, with phenol and cement as adjuvants, for low-grade intramedullary chondrosarcoma of the long bones. Acta Orthop Belg. 2011 Oct;77(5):666-9. PubMed PMID: 22187844. ](http://www.ncbi.nlm.nih.gov/pubmed/22187844)[View Abstract at PubMed](http://www.ncbi.nlm.nih.gov/pubmed/22187844)
94. [Chalmers PN, Keener JD. Expanding roles for reverse shoulder arthroplasty. Curr Rev Musculoskelet Med. 2016 Mar;9(1):40-8. doi: 10.1007/s12178-016-9316-0. PubMed PMID: 26803609. ](http://www.ncbi.nlm.nih.gov/pubmed/26803609)[View](http://www.ncbi.nlm.nih.gov/pubmed/26803609)
[Abstract at PubMed](http://www.ncbi.nlm.nih.gov/pubmed/26803609)
95. [King JJ, Nystrom LM, Reimer NB, Gibbs CP Jr, Scarborough MT, Wright TW. Allograft-prosthetic composite reverse total shoulder arthroplasty for reconstruction of proximal humerus tumor resections. J Shoulder Elbow Surg. 2016 Jan;25(1):45-54. doi: 10.1016/j.jse.2015.06.021. Epub 2015 Aug 6. PubMed PMID: 26256013. ](http://www.ncbi.nlm.nih.gov/pubmed/26256013)[View Abstract at PubMed](http://www.ncbi.nlm.nih.gov/pubmed/26256013)
Endoprosthetic reconstruction using a reverse shoulder arthroplasty may be employed when the rotator cuff is deficient for older patients with neoplasms of the proximal humerus. Allograft-prosthetic composite reverse shoulder arthroplasty also has been used with early success.
RECOMMENDED READINGS
92. [Mermerkaya MU, Bekmez S, Karaaslan F, Danisman M, Kosemehmetoglu K, Gedikoglu G, Ayvaz M, Tokgozoglu AM. Intralesional curettage and cementation for low-grade chondrosarcoma of long bones: retrospective study and literature review. World J Surg Oncol. 2014 Nov 10;12:336. doi: 10.1186/1477-7819-12-336. Review. PubMed PMID: 25382793.](http://www.ncbi.nlm.nih.gov/pubmed/25382793)[View Abstract at PubMed](http://www.ncbi.nlm.nih.gov/pubmed/25382793)
93. [Di Giorgio L, Touloupakis G, Vitullo F, Sodano L, Mastantuono M, Villani C. Intralesional curettage, with phenol and cement as adjuvants, for low-grade intramedullary chondrosarcoma of the long bones. Acta Orthop Belg. 2011 Oct;77(5):666-9. PubMed PMID: 22187844. ](http://www.ncbi.nlm.nih.gov/pubmed/22187844)[View Abstract at PubMed](http://www.ncbi.nlm.nih.gov/pubmed/22187844)
94. [Chalmers PN, Keener JD. Expanding roles for reverse shoulder arthroplasty. Curr Rev Musculoskelet Med. 2016 Mar;9(1):40-8. doi: 10.1007/s12178-016-9316-0. PubMed PMID: 26803609. ](http://www.ncbi.nlm.nih.gov/pubmed/26803609)[View](http://www.ncbi.nlm.nih.gov/pubmed/26803609)
[Abstract at PubMed](http://www.ncbi.nlm.nih.gov/pubmed/26803609)
95. [King JJ, Nystrom LM, Reimer NB, Gibbs CP Jr, Scarborough MT, Wright TW. Allograft-prosthetic composite reverse total shoulder arthroplasty for reconstruction of proximal humerus tumor resections. J Shoulder Elbow Surg. 2016 Jan;25(1):45-54. doi: 10.1016/j.jse.2015.06.021. Epub 2015 Aug 6. PubMed PMID: 26256013. ](http://www.ncbi.nlm.nih.gov/pubmed/26256013)[View Abstract at PubMed](http://www.ncbi.nlm.nih.gov/pubmed/26256013)
QUESTION 93
of 100
Figures 94a through 94f are the radiographs and MR images of a 16-year-old boy who experiences left ankle pain with activity. What is the most likely diagnosis?






Figures 94a through 94f are the radiographs and MR images of a 16-year-old boy who experiences left ankle pain with activity. What is the most likely diagnosis?






1
Aneurysmal bone cyst (ABC)
2
Fibrous dysplasia
3
Simple bone cyst
4
Ewing sarcoma
Radiographs reveal a purely lytic, mildly expansile lesion of the distal fibula metaphysis in a skeletally immature patient. All of the responses can be seen in the fibula of skeletally immature
patients and can show lytic areas. The MR images show multiple fluid-fluid levels in the lesion consistent with an ABC lesion. Simple bone scans can demonstrate a single fluid-fluid level particularly if they have fractured, but are generally less expansile and do not have the multiple fluid-fluid levels seen with ABCs. Ewing sarcoma and fibrous dysplasia tend to be more diaphyseal in location and do not involve the fluid-fluid levels seen in this patient. An aneurysmal bone cyst can occur because a secondary lesion is almost any bone tumor. Telangiectatic osteogenic sarcoma may mimic ABC and should be considered. Surgeons should perform biopsies with the highest-grade lesion considered in the differential and confirm pathology prior to proceeding with definitive treatment.
RECOMMENDED READINGS
96. [Wootton-Gorges SL. MR imaging of primary bone tumors and tumor-like conditions in children. Magn Reson Imaging Clin N Am. 2009 Aug;17(3):469-87, vi. doi: 10.1016/j.mric.2009.03.010. Review. PubMed PMID: 19524197.](http://www.ncbi.nlm.nih.gov/pubmed/19524197)[View Abstract at PubMed](http://www.ncbi.nlm.nih.gov/pubmed/19524197)
97. [Munk PL, Helms CA, Holt RG, Johnston J, Steinbach L, Neumann C. MR imaging of aneurysmal bone cysts. AJR Am J Roentgenol. 1989 Jul;153(1):99-101. PubMed PMID: 2735305. ](http://www.ncbi.nlm.nih.gov/pubmed/2735305)[View Abstract at](http://www.ncbi.nlm.nih.gov/pubmed/2735305)[ ](http://www.ncbi.nlm.nih.gov/pubmed/2735305)[PubMed](http://www.ncbi.nlm.nih.gov/pubmed/2735305)
98. Rapp TB, Ward JP, Alaia MJ. Aneurysmal bone cyst. J Am Acad Orthop Surg. 2012 Apr;20(4):233-
[41/. doi: 10.5435/JAAOS-20-04-233. Review. PubMed PMID: 22474093. ](http://www.ncbi.nlm.nih.gov/pubmed/22474093)[View Abstract at PubMed](http://www.ncbi.nlm.nih.gov/pubmed/22474093)
patients and can show lytic areas. The MR images show multiple fluid-fluid levels in the lesion consistent with an ABC lesion. Simple bone scans can demonstrate a single fluid-fluid level particularly if they have fractured, but are generally less expansile and do not have the multiple fluid-fluid levels seen with ABCs. Ewing sarcoma and fibrous dysplasia tend to be more diaphyseal in location and do not involve the fluid-fluid levels seen in this patient. An aneurysmal bone cyst can occur because a secondary lesion is almost any bone tumor. Telangiectatic osteogenic sarcoma may mimic ABC and should be considered. Surgeons should perform biopsies with the highest-grade lesion considered in the differential and confirm pathology prior to proceeding with definitive treatment.
RECOMMENDED READINGS
96. [Wootton-Gorges SL. MR imaging of primary bone tumors and tumor-like conditions in children. Magn Reson Imaging Clin N Am. 2009 Aug;17(3):469-87, vi. doi: 10.1016/j.mric.2009.03.010. Review. PubMed PMID: 19524197.](http://www.ncbi.nlm.nih.gov/pubmed/19524197)[View Abstract at PubMed](http://www.ncbi.nlm.nih.gov/pubmed/19524197)
97. [Munk PL, Helms CA, Holt RG, Johnston J, Steinbach L, Neumann C. MR imaging of aneurysmal bone cysts. AJR Am J Roentgenol. 1989 Jul;153(1):99-101. PubMed PMID: 2735305. ](http://www.ncbi.nlm.nih.gov/pubmed/2735305)[View Abstract at](http://www.ncbi.nlm.nih.gov/pubmed/2735305)[ ](http://www.ncbi.nlm.nih.gov/pubmed/2735305)[PubMed](http://www.ncbi.nlm.nih.gov/pubmed/2735305)
98. Rapp TB, Ward JP, Alaia MJ. Aneurysmal bone cyst. J Am Acad Orthop Surg. 2012 Apr;20(4):233-
[41/. doi: 10.5435/JAAOS-20-04-233. Review. PubMed PMID: 22474093. ](http://www.ncbi.nlm.nih.gov/pubmed/22474093)[View Abstract at PubMed](http://www.ncbi.nlm.nih.gov/pubmed/22474093)
QUESTION 94
of 100
A patient undergoes excision of a presumed lipoma of the superficial thigh. Final pathology reveals synovial sarcoma without reference to the margins. What is the recommendation for definitive treatment?
A patient undergoes excision of a presumed lipoma of the superficial thigh. Final pathology reveals synovial sarcoma without reference to the margins. What is the recommendation for definitive treatment?
1
Observation
2
External beam radiation therapy alone
3
Wide resection of the tumor bed and radiation therapy
4
Radiation therapy and chemotherapy
An unplanned excision of a soft-tissue sarcoma occurs when a surgeon removes a soft-tissue mass while believing it is benign, and, upon pathologic examination, learns that it is malignant. These procedures often are performed without presurgical staging studies or appropriate oncologic surgical technique. Following an unplanned excision, patients usually are referred to a sarcoma center for definitive care. Definitive treatment is hindered by the lack of presurgical imaging, sophisticated pathologic examination findings, and a contaminated tumor bed larger than the original tumor. Further, as many as 50% of cases are associated with residual disease within the tumor bed, even when no tumor can be identified with imaging or an examination and the initial
surgical report indicates all gross disease has been removed. Most patients for whom an inadequate excision of an unsuspected sarcoma is performed are treated with reexcision of the tumor bed, and, very often, adjuvant radiotherapy.
RECOMMENDED READINGS
99. [Gutierrez JC, Perez EA, Moffat FL, Livingstone AS, Franceschi D, Koniaris LG. Should soft tissue sarcomas be treated at high-volume centers? An analysis of 4205 patients. Ann Surg. 2007 Jun;245(6):952-8. PubMed PMID: 17522521.](http://www.ncbi.nlm.nih.gov/pubmed/17522521)[View Abstract at PubMed](http://www.ncbi.nlm.nih.gov/pubmed/17522521)
100. [Johnson GD, Smith G, Dramis A, Grimer RJ. Delays in referral of soft tissue sarcomas. Sarcoma. 2008;2008:378574. doi: 10.1155/2008/378574. PubMed PMID: 18317511. ](http://www.ncbi.nlm.nih.gov/pubmed/18317511)[View Abstract at PubMed](http://www.ncbi.nlm.nih.gov/pubmed/18317511)
surgical report indicates all gross disease has been removed. Most patients for whom an inadequate excision of an unsuspected sarcoma is performed are treated with reexcision of the tumor bed, and, very often, adjuvant radiotherapy.
RECOMMENDED READINGS
99. [Gutierrez JC, Perez EA, Moffat FL, Livingstone AS, Franceschi D, Koniaris LG. Should soft tissue sarcomas be treated at high-volume centers? An analysis of 4205 patients. Ann Surg. 2007 Jun;245(6):952-8. PubMed PMID: 17522521.](http://www.ncbi.nlm.nih.gov/pubmed/17522521)[View Abstract at PubMed](http://www.ncbi.nlm.nih.gov/pubmed/17522521)
100. [Johnson GD, Smith G, Dramis A, Grimer RJ. Delays in referral of soft tissue sarcomas. Sarcoma. 2008;2008:378574. doi: 10.1155/2008/378574. PubMed PMID: 18317511. ](http://www.ncbi.nlm.nih.gov/pubmed/18317511)[View Abstract at PubMed](http://www.ncbi.nlm.nih.gov/pubmed/18317511)
QUESTION 95
of 100
Figures 96a and 96b are the MRI sections of the symptomatic left knee of a 28-year-old man with left anterior knee pain 18 months after undergoing an allogenic bone marrow transplant for acute myelogenous leukemia. His intraoperative fluoroscopy images are shown in Figures 96c and 96d. What is most critical when obtaining a diagnosis for this patient?




Figures 96a and 96b are the MRI sections of the symptomatic left knee of a 28-year-old man with left anterior knee pain 18 months after undergoing an allogenic bone marrow transplant for acute myelogenous leukemia. His intraoperative fluoroscopy images are shown in Figures 96c and 96d. What is most critical when obtaining a diagnosis for this patient?




1
Sampling from the periphery of the lesion
2
Immediate formalin fixation
3
Sending unfixed fresh tissue
4
Fixation with ribonucleic acid (RNA) stabilization solution
Flow cytometry and cytogenetic analysis are frequently crucial to make an accurate diagnosis of leukemia and lymphoma. These techniques are best performed on fresh, unfixed tissue. Optimal technique includes moistening the tissue to prevent desiccation and immediately sending the specimen for pathologic analysis. Communication with the pathologist regarding the possibility of
a leukemia or lymphoma is prudent to facilitate prompt processing. It is advisable to have a hematology technician in the operating room to handle tissue. Sampling the periphery of tumors with cystic components is often necessary to obtain cellular tissue, but this necessity is not specific to leukemia and lymphoma cases. Formalin is the standard tissue preservation solution for most biopsies. RNA stabilization solution is usually used for research rather than clinical purposes.
RECOMMENDED READINGS
101. [Traina F, Errani C, Toscano A, Pungetti C, Fabbri D, Mazzotti A, Donati D, Faldini C. Current concepts in the biopsy of musculoskeletal tumors: AAOS exhibit selection. J Bone Joint Surg Am. 2015 Jan 21;97(2):e7. doi: 10.2106/JBJS.N.00661. Review. PubMed PMID: 25609446. ](http://www.ncbi.nlm.nih.gov/pubmed/25609446)[View Abstract at](http://www.ncbi.nlm.nih.gov/pubmed/25609446)[ ](http://www.ncbi.nlm.nih.gov/pubmed/25609446)[PubMed](http://www.ncbi.nlm.nih.gov/pubmed/25609446)
102. Virgo PF, Gibbs GJ. Flow cytometry in clinical pathology. Ann Clin Biochem. 2012 Jan;49(Pt 1):17-
[28/. doi: 10.1258/acb.2011.011128. Epub 2011 Oct 25. Review. PubMed PMID: 22028426. ](http://www.ncbi.nlm.nih.gov/pubmed/22028426)[View](http://www.ncbi.nlm.nih.gov/pubmed/22028426)[ ](http://www.ncbi.nlm.nih.gov/pubmed/22028426)[Abstract at PubMed](http://www.ncbi.nlm.nih.gov/pubmed/22028426)
103. Huang Q, Reddi D, Chu P, Snyder DS, Weisenburger DD. Clinical and pathologic analysis of extramedullary tumors after hematopoietic stem cell transplantation. Hum Pathol. 2014 Dec;45(12):2404-10. doi: 10.1016/j.humpath.2014.07.022. Epub 2014 Aug 23. PubMed PMID:
[25294373/. ](http://www.ncbi.nlm.nih.gov/pubmed/25294373)[View Abstract at PubMed](http://www.ncbi.nlm.nih.gov/pubmed/25294373)
a leukemia or lymphoma is prudent to facilitate prompt processing. It is advisable to have a hematology technician in the operating room to handle tissue. Sampling the periphery of tumors with cystic components is often necessary to obtain cellular tissue, but this necessity is not specific to leukemia and lymphoma cases. Formalin is the standard tissue preservation solution for most biopsies. RNA stabilization solution is usually used for research rather than clinical purposes.
RECOMMENDED READINGS
101. [Traina F, Errani C, Toscano A, Pungetti C, Fabbri D, Mazzotti A, Donati D, Faldini C. Current concepts in the biopsy of musculoskeletal tumors: AAOS exhibit selection. J Bone Joint Surg Am. 2015 Jan 21;97(2):e7. doi: 10.2106/JBJS.N.00661. Review. PubMed PMID: 25609446. ](http://www.ncbi.nlm.nih.gov/pubmed/25609446)[View Abstract at](http://www.ncbi.nlm.nih.gov/pubmed/25609446)[ ](http://www.ncbi.nlm.nih.gov/pubmed/25609446)[PubMed](http://www.ncbi.nlm.nih.gov/pubmed/25609446)
102. Virgo PF, Gibbs GJ. Flow cytometry in clinical pathology. Ann Clin Biochem. 2012 Jan;49(Pt 1):17-
[28/. doi: 10.1258/acb.2011.011128. Epub 2011 Oct 25. Review. PubMed PMID: 22028426. ](http://www.ncbi.nlm.nih.gov/pubmed/22028426)[View](http://www.ncbi.nlm.nih.gov/pubmed/22028426)[ ](http://www.ncbi.nlm.nih.gov/pubmed/22028426)[Abstract at PubMed](http://www.ncbi.nlm.nih.gov/pubmed/22028426)
103. Huang Q, Reddi D, Chu P, Snyder DS, Weisenburger DD. Clinical and pathologic analysis of extramedullary tumors after hematopoietic stem cell transplantation. Hum Pathol. 2014 Dec;45(12):2404-10. doi: 10.1016/j.humpath.2014.07.022. Epub 2014 Aug 23. PubMed PMID:
[25294373/. ](http://www.ncbi.nlm.nih.gov/pubmed/25294373)[View Abstract at PubMed](http://www.ncbi.nlm.nih.gov/pubmed/25294373)
QUESTION 96
of 100
Figures 97a through 97d are the radiographs and MR images of a 21-year-old man with symptoms of a left medial thigh mass. Upon examination, you palpate a firm, fixed, deep, nontender mass of the medial proximal left thigh. No other masses are found during the examination. The patient fears metastatic disease. What is the risk for malignant transformation throughout this patient’s lifetime?




Figures 97a through 97d are the radiographs and MR images of a 21-year-old man with symptoms of a left medial thigh mass. Upon examination, you palpate a firm, fixed, deep, nontender mass of the medial proximal left thigh. No other masses are found during the examination. The patient fears metastatic disease. What is the risk for malignant transformation throughout this patient’s lifetime?




1
0%
2
Less than 1%
3
Less than 15%
4
More than 15%
The images reveal a solitary pedunculated osteochondroma. Malignant degeneration of solitary osteochondromas occurs in fewer than 1% of patients. A reasonable approach would be to inform the patient of the rare (less than 1%) incidence of malignant degeneration and to return for evaluation if symptoms develop or if the patient notices growth of the lesion.
RECOMMENDED READINGS
104. Schwartz AJ. Benign cartilage tumors. In: Biermann JS, ed. _Orthopaedic Knowledge Update Musculoskeletal Tumors 3_. Rosemont, IL: American Academy of Orthopaedic Surgeons; 2013:97-106.
105. [Aboulafia AJ, Kennon RE, Jelinek JS. Benign bone tumors of childhood. J Am Acad Orthop Surg. 1999 Nov-Dec;7(6):377-88. Review. PubMed PMID: 11505926.](http://www.ncbi.nlm.nih.gov/pubmed/11505926)[View Abstract at PubMed](http://www.ncbi.nlm.nih.gov/pubmed/11505926)
RECOMMENDED READINGS
104. Schwartz AJ. Benign cartilage tumors. In: Biermann JS, ed. _Orthopaedic Knowledge Update Musculoskeletal Tumors 3_. Rosemont, IL: American Academy of Orthopaedic Surgeons; 2013:97-106.
105. [Aboulafia AJ, Kennon RE, Jelinek JS. Benign bone tumors of childhood. J Am Acad Orthop Surg. 1999 Nov-Dec;7(6):377-88. Review. PubMed PMID: 11505926.](http://www.ncbi.nlm.nih.gov/pubmed/11505926)[View Abstract at PubMed](http://www.ncbi.nlm.nih.gov/pubmed/11505926)
QUESTION 97
of 100
Figures 98a and 98b are the radiograph and biopsy specimen of a 20-year-old man who is being evaluated for the first time for foot pain. Treatment should include



Figures 98a and 98b are the radiograph and biopsy specimen of a 20-year-old man who is being evaluated for the first time for foot pain. Treatment should include



1
first-ray amputation.
2
extended curettage and grafting or cementation.
3
extended curettage, radiation, and chemotherapy.
4
wide resection and chemotherapy.
This pathology is most consistent with giant-cell tumor. Note the presence of multinucleated cells and stroma of spindlelike cells with pale staining cytoplasm and nuclei. Giant-cell tumors typically occur in patients ages 20 to 40. Common sites include the epiphysis of the distal femur or proximal tibia (50% of the time). Although it is a benign lesion, giant-cell tumors have a tendency for bone destruction, recurrence, and, rarely, metastasis. The initial treatment of choice is curettage with grafting or cementation. For recurrent or stage III tumors, wide excision may be necessary. Chemotherapy or radiation therapy are not indicated as initial treatment, especially if this is an isolated primary lesion.
RECOMMENDED READINGS
106. [Turcotte RE. Giant cell tumor of bone. Orthop Clin North Am. 2006 Jan;37(1):35-51. Review. PubMed PMID: 16311110.](http://www.ncbi.nlm.nih.gov/pubmed/16311110)[View Abstract at PubMed](http://www.ncbi.nlm.nih.gov/pubmed/16311110)
107. [Eckardt JJ, Grogan TJ. Giant cell tumor of bone. Clin Orthop Relat Res. 1986 Mar;(204):45-58. Review. PubMed PMID: 3514036.](http://www.ncbi.nlm.nih.gov/pubmed/3514036)[View Abstract at PubMed](http://www.ncbi.nlm.nih.gov/pubmed/3514036)
RECOMMENDED READINGS
106. [Turcotte RE. Giant cell tumor of bone. Orthop Clin North Am. 2006 Jan;37(1):35-51. Review. PubMed PMID: 16311110.](http://www.ncbi.nlm.nih.gov/pubmed/16311110)[View Abstract at PubMed](http://www.ncbi.nlm.nih.gov/pubmed/16311110)
107. [Eckardt JJ, Grogan TJ. Giant cell tumor of bone. Clin Orthop Relat Res. 1986 Mar;(204):45-58. Review. PubMed PMID: 3514036.](http://www.ncbi.nlm.nih.gov/pubmed/3514036)[View Abstract at PubMed](http://www.ncbi.nlm.nih.gov/pubmed/3514036)
QUESTION 98
of 100
What are the most common primary sites for carcinomas metastatic to bone?
What are the most common primary sites for carcinomas metastatic to bone?
1
Lung, breast, prostate, kidney, and thyroid
2
Lung, cervical, prostate, breast, and kidney
3
Breast, lung, prostate, bladder, and adrenal
4
Prostate, lung, breast, bladder, and cervical
The lung, breast, prostate, kidney, and thyroid are the most common primary sites metastatic to bone. Thyroid cancer metastases are becoming less common when patients pursue treatment. Other metastatic disease including metastases from cervical, hepatocellular, adrenal, and bladder cancers is less common. Metastatic disease most commonly involves the spine and pelvis.
RECOMMENDED READINGS
108. Nielsen GP, Rosenberg AE. _Diagnostic Pathology Bone_. Manitoba, Canada: Amirsys; 2013:14.1-14.7.
109. Coleman R, Brown J, Terpos E, Lipton A, Smith MR, Cook R, Major P. Bone markers and their prognostic value in metastatic bone disease: clinical evidence and future directions. Cancer Treat Rev. 2008 Nov;34(7):629-39. doi: 10.1016/j.ctrv.2008.05.001. Epub 2008 Jun 24. Review. PubMed PMID:
[18579314.](http://www.ncbi.nlm.nih.gov/pubmed/18579314)[View Abstract at PubMed](http://www.ncbi.nlm.nih.gov/pubmed/18579314)
RECOMMENDED READINGS
108. Nielsen GP, Rosenberg AE. _Diagnostic Pathology Bone_. Manitoba, Canada: Amirsys; 2013:14.1-14.7.
109. Coleman R, Brown J, Terpos E, Lipton A, Smith MR, Cook R, Major P. Bone markers and their prognostic value in metastatic bone disease: clinical evidence and future directions. Cancer Treat Rev. 2008 Nov;34(7):629-39. doi: 10.1016/j.ctrv.2008.05.001. Epub 2008 Jun 24. Review. PubMed PMID:
[18579314.](http://www.ncbi.nlm.nih.gov/pubmed/18579314)[View Abstract at PubMed](http://www.ncbi.nlm.nih.gov/pubmed/18579314)
QUESTION 99
of 100
Figures 100a through 100c are the select T1 and T2 axial and T2 sagittal MR images of a 26-year-old-woman who has had intermittent left thigh pain for 6 months that is exacerbated by activity. Left femur radiographs are unremarkable. Initial treatment should include



Figures 100a through 100c are the select T1 and T2 axial and T2 sagittal MR images of a 26-year-old-woman who has had intermittent left thigh pain for 6 months that is exacerbated by activity. Left femur radiographs are unremarkable. Initial treatment should include



1
observation.
2
sclerotherapy.
3
open biopsy.
4
wide resection.
MR imaging reveals a lesion within the vastus intermedius muscle that has signal characteristics consistent with vascular structures and a “bag-of-worms” appearance consistent with a vascular malformation. T1-weighted MR imaging shows fat interspersed among the tissue consistent with a vascular malformation. Vascular malformations often can be determined on imaging alone, particularly if the radiographs reveal phleboliths. Biopsy is generally unnecessary and open biopsy can be particularly difficult due to significant bleeding if performed without the tourniquet, and difficulty identifying the lesion if a tourniquet is utilized. Wide resection generally is unnecessary because these lesions do not have malignant potential. Excision of vascular malformations can be curative, but many patients experience symptom relief with percutaneous sclerotherapy. This patient should be referred for consideration of this less morbid minimally invasive approach.
RECOMMENDED READINGS
110. [Fayad LM, Hazirolan T, Bluemke D, Mitchell S. Vascular malformations in the extremities: emphasis on MR imaging features that guide treatment options. Skeletal Radiol. 2006 Mar;35(3):127-37. Epub 2006 Jan 27. Review. Erratum in: Skeletal Radiol. 2006 Dec;35(12):964. Fayad, Laura [corrected to Fayad, Laura M]. PubMed PMID: 16447042. ](http://www.ncbi.nlm.nih.gov/pubmed/16447042)[View Abstract at PubMed](http://www.ncbi.nlm.nih.gov/pubmed/16447042)
111. Greene AK, Orbach DB. Management of arteriovenous malformations. Clin Plast Surg. 2011 Jan;38(1):95-106. doi: 10.1016/j.cps.2010.08.005. Review. PubMed PMID: 21095475.
[View Abstract at PubMed](http://www.ncbi.nlm.nih.gov/pubmed/21095475)
112. [Marler JJ, Mulliken JB. Current management of hemangiomas and vascular malformations. Clin Plast Surg. 2005 Jan;32(1):99-116, ix. Review. PubMed PMID: 15636768. ](http://www.ncbi.nlm.nih.gov/pubmed/15636768)[View Abstract at PubMed](http://www.ncbi.nlm.nih.gov/pubmed/15636768)
_**This is the last question of the exam.**_
_**GOOD LUCK**_
RECOMMENDED READINGS
110. [Fayad LM, Hazirolan T, Bluemke D, Mitchell S. Vascular malformations in the extremities: emphasis on MR imaging features that guide treatment options. Skeletal Radiol. 2006 Mar;35(3):127-37. Epub 2006 Jan 27. Review. Erratum in: Skeletal Radiol. 2006 Dec;35(12):964. Fayad, Laura [corrected to Fayad, Laura M]. PubMed PMID: 16447042. ](http://www.ncbi.nlm.nih.gov/pubmed/16447042)[View Abstract at PubMed](http://www.ncbi.nlm.nih.gov/pubmed/16447042)
111. Greene AK, Orbach DB. Management of arteriovenous malformations. Clin Plast Surg. 2011 Jan;38(1):95-106. doi: 10.1016/j.cps.2010.08.005. Review. PubMed PMID: 21095475.
[View Abstract at PubMed](http://www.ncbi.nlm.nih.gov/pubmed/21095475)
112. [Marler JJ, Mulliken JB. Current management of hemangiomas and vascular malformations. Clin Plast Surg. 2005 Jan;32(1):99-116, ix. Review. PubMed PMID: 15636768. ](http://www.ncbi.nlm.nih.gov/pubmed/15636768)[View Abstract at PubMed](http://www.ncbi.nlm.nih.gov/pubmed/15636768)
_**This is the last question of the exam.**_
_**GOOD LUCK**_
